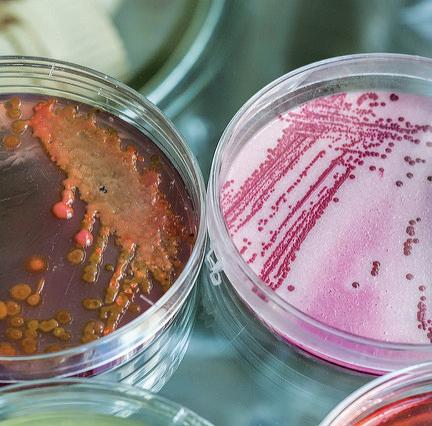
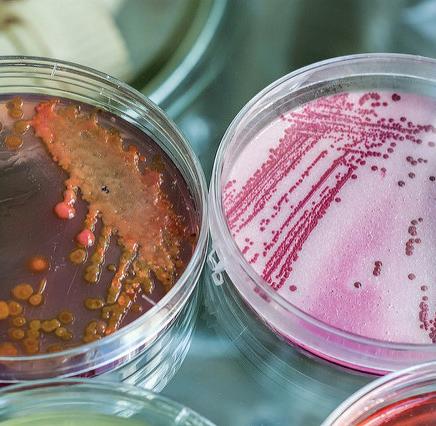

Published by Accelerate Learning Inc., 5177 Richmond Ave, Suite 800, Houston, TX 77056. Copyright © 2025, by Accelerate Learning Inc. All rights reserved. No part of this publication may be reproduced or distributed in any form or by any means, or stored in a database or retrieval system, without prior written consent of Accelerate Learning Inc., including, but not limited to, in any network or other electronic storage or transmission, or broadcast for distance learning.
To learn more, visit us at www.stemscopes.com.

Student Expectations
The student is expected to demonstrate an understanding that living things range from simple to complex organisms, are organized hierarchically, are composed of cells, and function as whole living systems.
How can a tiny cell be the building block for everything from a simple plant to a complex human being?
Key Concepts
• The cell theory states that all living organisms are composed of cells, the cell is the basic unit of structure and function in living things, and all cells arise from preexisting cells. This theory holds true for all living things, unicellular or multicellular.
• All living things are made up of cells, which are the smallest units that can be said to be alive.
• A virus is nonliving, does not have its own metabolism, lacks cellular structure, and is unable to reproduce outside of a host cell.
• An organism may consist of one single cell or many different numbers and types of cells.
• Unicellular organisms, like multicellular organisms, need food, water, a way to dispose of waste, and an environment in which they can live.
• Groups of cells, the smallest units of a plant or animal, form tissues. Tissues with similar structures and functions form organs. Organ systems are the result of various organs working together. Organisms are the sum of all levels of organization operating together.
This unit develops students’ understanding of cells as the basic unit of life and how living things, from unicellular to complex multicellular organisms, are organized hierarchically. Students gather and analyze evidence to distinguish living, onceliving, and nonliving materials, classify organisms by cellularity, and trace key contributions that shaped cell theory. They model how cells form tissues, organs, and body systems, constructing explanations that connect structure and function to show how interacting subsystems operate as whole living systems.
Scope Vocabulary
The terms below and their definitions can be found in Picture Vocabulary and are embedded in context throughout the scope.
Cell
The basic structural and functional unit of living organisms
Cell Theory
A theory that states the following: all life is made up of cells, cells are the fundamental unit of life, and all cells come from preexisting cells
Multicellular
A category of organisms made up of more than one cell and of different types of cells
Organ
A collection of similar tissues joined together into a structure that performs specialized functions
Organism
A self-contained living thing
Tissue
A mass of similar cells that perform a specialized function
Unicellular
A category of organisms made up of one cell
Virus
A nonliving particle dependent on host cells for replication of genetic material
Notes
Students explore the hierarchical organization of living things to understand that the cell is the basic unit of life.
• Engage in a guided discussion to identify organs/structures in animals and plants and what they are made of.
• Work in small groups to sort picture cards into organisms, structures, cells, and organelles.
• Discuss conclusions about the hierarchy and record a student-generated definition of “cell” in lab journals.
Activity - Multicellular vs. Unicellular
Students investigate that all living things are composed of cells and distinguish unicellular from multicellular organisms.
• Use microscopes to prepare and observe slides from a range of living, once-living, and nonliving samples to collect evidence of cells.
• Decide whether samples are living, once-living, or nonliving based on the presence of cells and observable life functions.
• Construct a claim-evidence-reasoning explanation summarizing what living things have in common.
• Analyze images to classify organisms as unicellular or multicellular and identify examples of each.
Students investigate how key scientific contributions shaped the development of cell theory.
• In groups, research an assigned scientist’s contribution to understanding cells.
• Create a poster with visuals representing the contribution, labeled only with the scientist’s name and dates.
• Arrange posters chronologically to build a class timeline of discoveries.
• Synthesize learning through a guided discussion and journal reflections on cells, uni-/multicellular examples, cell theory, and the role of microscopes.
Making a Model - Levels of Organization
Students investigate how cells form tissues, organs, and systems by using analogies and evidence to understand biological organization.
• Sequence and sort cards to model levels of organization from simplest to most complex.
• Create and illustrate analogies (e.g., building components) to reinforce how parts combine into larger systems.
• Categorize structures (organelle, tissue, organ, system), pair them by shared function, and identify the needs they meet.
• Use a Body Systems text to write and peer-review a CER explaining that the human body is a system of interacting subsystems composed of groups of cells.
L.6.1.1, 1.2, 1.5 & 1.6

15 min - 30 min
L.6.1.1,
Students organize photos of organisms, organs, cells, and organelles to explore cells as the basic unit of living things.
Materials
Printed
● 1 Units of Life (per student)
● 1 Picture Cards (per group)
Consumable
● 1 lab journal (per student)
SEP Connection
Print and cut one set of Picture Cards per group. These may be laminated for future use.
Developing and Using Models, and Planning and Carrying Out Investigations, and Obtaining, Evaluating, and Communicating Information
During this activity, students will develop and use models to describe and predict the phenomenon of how a tiny cell can be the building block for everything from a simple plant to a complex human being. By organizing photos of organisms, organs, cells, and organelles, students will evaluate the limitations of their models and modify them based on evidence to represent systems and interactions at unobservable scales. This process will help them understand the mechanistic account of natural phenomena and communicate their findings effectively.
Notes
Systems and system models and Structure and function
During this activity, students will use models to represent systems and their interactions, exploring how cells, as the basic unit of life, form complex structures and systems in organisms. They will analyze the structure and function of cells and organelles, understanding how these microscopic systems interact and contribute to the larger systems of organs and organisms. Through organizing and modeling, students will gain insights into how systems may interact with other systems and the limitations of models in representing complex biological systems.
1. Begin the activity with a discussion:
○ If we were to look inside an animal or human being, what would we see? Accept all answers, but lead students to a list of organs and structures, such as bones, muscles, etc., that perform different functions in the body.
○ What specialized structures would we see in a plant? Leaves, stems, roots, etc.
○ What are these organs and structures made of? Cells
○ What are cells made of? A membrane, nucleus, and other organelles
2. Place students into small groups. Give each group a set of Picture Cards.
3. Ask students to arrange the cards into four rows: organisms, structures, cells, and organelles.
4. Discuss the following:
○ What do you conclude from the picture chart you have made? Organisms are composed of specialized structures made up of cells that contain organelles.
○ Which level do you believe is the basic unit of life? The cell. All larger structures depend on the cell, and there is no living thing which is only an organelle. The word cell also means "a small room." A cell can be compared to a room in which the organelles are the furniture. Even though it contains furniture, the room would be the basic unit of living space.
○ How would you define a cell? Have students write their definition in their lab journals. A cell is the basic unit of life.
In this activity, students have to organize picture cards into organisms, structures, cells, and organelles. This could be a laborious task for some students if they do not fully comprehend or remember the definitions of these terms. Before this activity, a review of these terms and their definitions, along with examples given for each term, could ensure students fully understand the definitions before completing the activity. An engaging pre-activity for the whole class using whiteboards, technology (iPads), etc., could help all students recall previous knowledge of these terms and help them better master this scope. Find more strategies to help students classify objects in the Intervention Toolbox.
Phenomenon Connection
How do the basic structures and functions of cells enable them to be the building blocks for all living organisms, from simple plants to complex human beings?
1. Based on your arrangement of the picture cards, how do cells contribute to the formation of complex structures in organisms?
2. If cells are the basic unit of life, how do organelles within a cell work together to support the cell’s function?
3. How might the organization of cells differ between a simple plant and a complex human being, and what does this tell us about their roles in different organisms?
FACILITATION TIP
Model how to sort a couple of cards so students know what “rows” should look like.
FACILITATION TIP
Clarify that organism refers to a complete, independent living thing.

Estimated 2 hrs - 3 hrs
Explore
In Part I, students conduct an investigation to produce data to serve as the basis for evidence that living things are made of cells—either one cell or many cells—and that cells are observable at microscopic scales. In Part II, students view images to determine which organisms are unicellular and which are multicellular.
Materials
Printed
● 1 Student Journal (per student)
● 1 Cell Theory CER Key (per teacher)
Reusable
● 1 microscope (per group)
● 5 microscope slides (per group)
● 5 coverslips (per group)
● 1 pipette (per group)
● 1 scalpel (per group)
● Prepared slides of different cells (optional)
● Prepared slides of minerals (optional)
Consumable
● Water, 50 mL (per group)
● Water, pond, 50 mL (per group)
● 1 leaf, plant, water (per group)
● Sand, 5 mL (~7 g) (per group)
● 1 lab journal (per student)
● Student Journals should be printed individually for student use. Review the Cell Theory CER Key prior to conducting the CER with students.
● Items for students to investigate can be obtained in two ways. Students could take a walk around the schoolyard and gather different items from which to make slides to examine for cells. If you choose this option, make sure the items the students collect can be sliced thinly enough to put on a slide. You may need to supplement their selections with prepared slides for examples that may be difficult for them obtain, such as viruses and bacteria.
● There can be items such as the ones listed in the Materials List for students to investigate in the classroom. Make sure to provide a variety of living and nonliving samples, including examples of viruses and bacteria.
● The number of items for the students to observe will vary with available time. Students should observe enough, however, so that each student will be able to practice making a slide. If the students have not used a microscope before or have not made wet mounts, then you may need to show the proper procedures.
Developing and Using Models, and Planning and Carrying Out Investigations, and Obtaining, Evaluating, and Communicating Information
During this activity, students will develop and use models to describe and predict the phenomenon of how a tiny cell can be the building block for everything from a simple plant to a complex human being. By conducting investigations and using microscopes to observe cells, students will evaluate the limitations of their models and modify them based on evidence to match what happens when variables or components of a system are changed. They will also communicate their findings through scientific explanations, integrating qualitative and quantitative information to clarify their claims about the natural world.
Systems and system models and Structure and function
During this activity, students will use systems and system models to explore the phenomenon of how a tiny cell can be the building block for everything from a simple plant to a complex human being. They will investigate and model the complex structures and systems of unicellular and multicellular organisms, analyzing how their function depends on the shapes, composition, and relationships among their parts. Through this exploration, students will understand how cells interact within larger systems and recognize the limitations of models in representing only certain aspects of these systems.
1. A set of suggested procedures is given in the Student Journal. These procedures are to be used as an example. You may choose to guide the students in planning their own investigation by going through each of the suggested 10 steps before distributing the Student Journal or have the students plan their investigations using the Student Journal as a guide.
2. Begin the activity with a discussion:
○ How can you determine if something is living or not? Look for cells or life functions.
○ How would you categorize a cat—living or nonliving? Living
○ How would you categorize wood? Accept all answers, but guide students toward the idea of once living.
○ How would you categorize a rock? Nonliving
3. To complete Step 10, instruct students to write a conclusion and a scientific explanation based on the following prompt: What do all living things have in common?
4. After students complete their task, have them use their data and the observations they gathered in the investigation to write a scientific explanation that includes a claim, evidence, and reasoning (CER).
5. Review student findings with a discussion. Have students record their answers in complete sentences in their lab journals throughout the discussion.
○ How were you able to determine if something was living? It had cells and/or displayed life functions.
○ How were you able to determine if something was once living? It had cells.
○ How were you able to determine if something was nonliving or never living? It did not have cells.
○ Why do you need a microscope to use the presence of cells to identify if something is living? Cells are microscopic and are at a scale too small for humans to see without magnification.
Notes
FACILITATION TIP
Let students brainstorm their own “living vs. nonliving” criteria before steering toward cells and life functions.
FACILITATION TIP
Clarify the difference between never living (rock) vs. once living (wood).
L.6.1.1, 1.2, 1.5 & 1.6

L.6.1.1, 1.2, 1.5 & 1.6
Part II: Single or Multiple
1. Have students work in groups of four or in pairs to complete this task.
After students propose what “uni-” and “multi-” mean, have them check their definitions for unicellular and multicellular with a partner before class discussion.
2. Begin the activity with a discussion:
○ What does the prefix uni- mean? One
○ What does the prefix multi- mean? Many
○ What would the word unicellular mean? Having one cell
○ What would the word multicellular mean? Having more than one cell
3. Have students complete the activity using the prompts in the Student Journal.
4. Review student findings with a discussion. Have students record their answers in complete sentences in their lab journals throughout the discussion.
○ Describe unicellular and multicellular organisms. Unicellular organisms consist of one cell. Multicellular organisms consist of many cells.
○ Provide an example for each. An example of a unicellular organism is a bacterium, yeast, or unfertilized chicken egg. An example of a multicellular organism is a bat, tree, or frog.
Sharp Objects
Be sure to instruct students on how to properly use a scalpel to prevent injury.
Exit Slip
At the end of the Explore, have students write a short description of the activity. Make sure to remind students to use vocabulary from the lesson including cells, unicellular, multicellular, and organisms. Once students have completed their descriptions, hold a class discussion on what they wrote.
How can a tiny cell be the building block for everything from a simple plant to a complex human being?
1. Based on your observations, how do the structures of unicellular and multicellular organisms differ in supporting life functions?
2. How do the functions of cells in a multicellular organism contribute to the organism’s overall complexity and ability to survive?
3. In what ways do cells in a multicellular organism communicate and work together to maintain the organism’s health and functionality?

Estimated 2 hrs - 3 hrs
L.6.1.1, 1.2, 1.5 & 1.6
Students research the contributions of various scientists to the cell theory.
Materials
Printed
● 1 Student Journal (per student or group, or class set)
Reusable
● 1 set, markers, colored (per group)
● 1 computer with Internet access (per group)
Consumable
● 1 paper or board, poster-sized (per group)
● 1 lab journal (per student)
You may want to review the process for using different search engine tools and the procedure for verifying sources of online information. You can also set up a web page with links for the assignment.
● Student handouts can be printed individually for student use or as a reusable class set, or they can be assigned online.
● Gather materials needed for each part of the activity.
● Group students if they are not already in groups.
Developing and Using Models, and Planning and Carrying Out Investigations, and Obtaining, Evaluating, and Communicating Information
During this activity, students will develop and use models to describe and predict the phenomenon of how a tiny cell can be the building block for everything from a simple plant to a complex human being. By researching the contributions of various scientists to the cell theory, students will evaluate the limitations of models and modify them based on evidence to match changes in variables or components of a system. They will also plan and carry out investigations to gather data, supporting explanations of the cell theory’s development. Additionally, students will obtain, evaluate, and communicate information by synthesizing research findings into visual displays, such as posters, to clarify the contributions of scientists and the role of engineering in the development of the cell theory.
Notes
Systems and system models and Structure and function
During this activity, students will explore systems and system models by researching the contributions of various scientists to the cell theory, which illustrates how cells, as sub-systems, interact within larger complex systems such as plants and humans. By creating models and visual representations, students will analyze the structure and function of cells, understanding how their microscopic structures contribute to the overall function of living organisms, thus addressing the phenomenon of how a tiny cell can be the building block for everything from a simple plant to a complex human being.
1. Begin with a discussion:
○ What is the building block of living things? The cell
○ How do we know this? Accept all answers.
○ Who came up with this idea? Accept all answers.
2. Assign each student group one of the following scientists. Have students research the contribution the scientist made to the discovery of cells.
○ Zacharias and Hans Janssen
○ Robert Hooke
○ Anton Van Leeuwenhoek
○ Matthias Schleiden
○ Theodor Schwann
○ Robert Remak
3. Have each group draw a poster about the scientist and his contribution to the cell theory. The only words on the poster should be the scientist’s name and the year or range of years during which he contributed. Everything else should be a drawing representing the scientist's contribution.
4. When students complete their posters, have them display them in chronological order.
5. Wrap up the activity with a discussion. Have students record their answers in complete sentences in their lab journals throughout the discussion.
○ What is a cell? A cell is the smallest unit of all living things.
○ Describe unicellular and multicellular organisms. Unicellular organisms consist of one cell. Multicellular organisms consist of many cells.
○ Provide an example for each. An example of a unicellular organism is an amoeba. An example of a multicellular organism is a plant.
○ What is the cell theory? Cell theory is an explanation of the relationship between cells and living organisms. All living things are made of cells.
○ How did engineering play a role in the development of the cell theory? The microscope had to be invented so that scientists could observe and discover cells. Cells are microscopic-scale phenomena that can typically be observed only when using a microscope. Cells typically cannot be observed individually at the natural scale of the human eye.
Notes
FACILITATION TIP
Show an early sketch of a cell (Hooke’s cork cells) or an early microscope photo to hook student interest.
FACILITATION TIP
Use a gallery walk to allow groups to circulate and take notes on each scientist before the final discussion.
L.6.1.1, 1.2, 1.5 & 1.6

L.6.1.1, 1.2, 1.5 & 1.6 Cell
After the students have explored different contributions of scientists to the cell theory, have them collect their thoughts to take part in the following activity. Students work collaboratively in groups of four to dramatize scientist contributions.
● Place the following headings on small folded pieces of paper in a container:
○ Zacharias and Hans Janssen
○ Robert Hooke
○ Anton Van Leeuwenhoek
○ Matthias Schleiden
○ Theodor Schwann
○ Robert Remak
● Divide students into groups of four.
● Instruct students to create a small skit that shows the contribution of their assigned scientist.
● Give the groups 5–10 minutes to prepare their skits. Groups need to decipher when each individual will act out his or her word. (Groups should not use "sounds like" as a clue.)
● As groups prepare skits, place numbers on small folded pieces of paper.
● Have each group pick a paper out of the container to randomly assign the order of skit presentations.
● Warn each group that you will allow one minute of "thinking time" after each skit presentation concludes. (Students should not immediately call out answers during this time.)
● After the "thinking time," direct each group to guess the scientist that the group tried to act out.
● Have the groups keep guessing until they correctly pick the scientist.
How did the development of the cell theory change our understanding of living organisms?
1. How did the invention of the microscope contribute to the discovery and understanding of cells?
2. In what ways do the contributions of scientists like Hooke and Leeuwenhoek illustrate the importance of collaboration and building on previous knowledge in scientific discovery?
3. How does the cell theory help explain the complexity and diversity of life forms, from unicellular organisms to complex multicellular organisms like humans?
Notes

Estimated 1 hr - 2 hrs
Students organize pictures that illustrate the levels of organization of living things as they compare to the organization of a building. Students next create their own levels of organization analogy. They complete a chart identifying structures that perform similar functions within each level of organization. Students then read scientific text adapted for classroom use to find evidence that the described systems are made of cells.
Materials
Printed Material
● 1 Student Journal (per student, group, or class)
● 1 Body Systems (per student)
● 1 Levels of Organization Cards (Part II) (per student)
● 1 Levels of Organization Cards (Part IV) (per group)
● 1 CER Rubric Key (per teacher)
Reusable Material
● 1 Scissors (per student)
● 1 glue, stick (per group)
● Consumable Material
● 1 lab journal (per student)
● Student Journals can be printed individually for student use or as a reusable class set, or they can be assigned online.
● Review the CER Rubric KEY prior to conducting the CER with students.
● Print one copy of the Levels of Organization (Part II) for each student.
● Print one copy of the Levels of Organization (Part IV) per group.
● Print one copy of the Body Systems per student as a class set and laminate for future use.
Developing and Using Models, and Planning and Carrying Out Investigations, and Obtaining, Evaluating, and Communicating Information
During this activity, students will develop and use models to describe and predict the phenomenon of how a tiny cell can be the building block for everything from a simple plant to a complex human being. By organizing and comparing levels of organization in living organisms to a building, students will evaluate the limitations of their models and modify them based on evidence. They will also plan and carry out investigations to gather data supporting their explanations of cellular organization. Additionally, students will obtain, evaluate, and communicate information through reading scientific texts and writing explanations, thereby enhancing their understanding of the systems and interactions within living organisms.
Systems and system models and Structure and function
During this activity, students will use models to explore the phenomenon of how a tiny cell can be the building block for everything from a simple plant to a complex human being. By organizing and analyzing the levels of organization in living organisms, students will understand how systems and subsystems interact within larger complex systems. They will model and visualize the structure and function of these systems, recognizing how the composition and relationships among parts contribute to their overall function. Through this process, students will learn the limitations of models and how they represent specific aspects of the systems under study.
Part I
1. Begin the activity with a discussion:
○ What is the basic building block of an apartment building? Brick
○ If you put a number of bricks together, what do you have? A wall
○ After all the walls are built, what is the smallest part of the building you have? A room
○ When you put all the rooms together, what do you have? An apartment
○ When you put all the apartments together, what do you have? An apartment building
○ How is this arrangement like the organization of a living organism? Accept all answers.
2. Have the students work in groups to come up with their silly sentences. You may want to have them illustrate their sentences in their lab journals to help them remember the sentences.
Part II
1. Pass out the Levels of Organization Cards (Part II) sheet to each student.
2. Ask students to cut out the cards and glue them in order from simplest to most complex.
Part III
1. Have the students work in groups to come up with their analogies. You may want to have them illustrate their analogies in their lab journals to help them remember.
Part IV
1. Pass out the Levels of Organization Cards (Part IV) sheet to each student.
2. Ask students to organize the cards into the categories of organelle, tissue, organ, and system.
3. Then, have students pair cards from each category together by common function.
4. Finally, have students determine the need that is met by these components.
Notes
FACILITATION TIP
When students create “silly sentences,” let them share aloud. This playfulness helps retention.
FACILITATION TIP
Let students compare with a partner before finalizing their order.
L.6.1.1, 1.2, 1.5 & 1.6

Part V
1. Pass out Body Systems.
Provide a rubric or 2–3 guiding questions for reviewing each other’s work (e.g., “Did they include a claim? Evidence? Reasoning?”).
2. Ask students to use the information to write an explanation to support this statement: The human body is a system of interacting subsystems composed of groups of cells.
3. After students have completed their scientific explanations, have students exchange papers and evaluate each other’s evidence and reasoning.
4. Finish with a discussion to review findings. Have students record their answers in complete sentences in their lab journals throughout the discussion.
○ How did you match the cells to the tissue? The tissue is made up of the same types of cells.
○ How did you match the tissue to the organ? The organ is made up of the same type of cells.
○ How did you match the organ to the organ system? The organ system is made up of the same type of cells.
After the students have completed the Explore, give them an opportunity to show their understanding by playing the Magnificent Quad Game. In this game, you will review the major levels of organization in complex life.
The Magnificent Quad Technique:
● Place students in groups of four.
● Give each group four index cards.
● Assign each group one of the following terms: cell, tissue, organ, organism.
● Each member of the group should complete one index card (A, B, C, or D) as follows:
○ Student A decorates the word to be defined on the first index card.
○ Student B illustrates the word to be defined on the second index card.
○ Student C writes the definition in bold type on the third index card.
○ Student D writes an antonym of the word on the fourth index card.
Notes
● Instruct the group to choose a small symbol to place on the back upper-right corner of all four index cards.
● Pick up the cards, mix them up, and redistribute the cards to all the students.
● Direct students to find their matches for each group of cards. Allow students to use the symbols on the backs of the cards, if necessary, to find their matches.
● Have the new student groups of four then discuss the new word, the illustration, the definition, and the antonym and prepare to present their word to the class.
● Facilitate this process by asking each group to report the strategies they used to find their matches.
How does the organization of cells into increasingly complex structures allow a tiny cell to be the building block for everything from a simple plant to a complex human being?
1. In what ways does the organization of cells into tissues, organs, and systems compare to the construction of a building from bricks to rooms to entire structures?
2. How does each level of organization in living organisms contribute to the overall function and complexity of the organism?
3. What evidence can we find in the human body to support the idea that it is a system of interacting subsystems composed of groups of cells?
L.6.1.1, 1.2, 1.5 & 1.6

L.6.1.1, 1.2, 1.5 & 1.6
STEMscopedia
Reference materials that includes parent connections, career connections, technology, and science news.
Linking Literacy
Strategies to help students comprehend difficult informational text.
Picture Vocabulary
A slide presentation of important vocabulary terms along with a picture and definition.
Content Connections Video
A video-based activity where students watch a video clip that relates to the scope’s content and answer questions.
Career Connections - Neurologist
STEM careers come to life with these leveled career exploration videos and student guides designed to take the learning further.
Math Connections
A practice that uses grade-level appropriate math activities to address the concept.
Reading Science - Your Liver Is Your Friend
A reading passage about the concept, which includes five to eight comprehension questions.
Notes
Claim-Evidence-Reasoning
An assessment in which students write a scientific explanation to show their understanding of the concept in a way that uses evidence.
Multiple Choice Assessment
A standards-based assessment designed to gauge students’ understanding of the science concept using their selections of the best possible answers from a list of choices
Open-Ended Response Assessment
A short-answer and essay assessment to evaluate student mastery of the concept.
Guided Practice
A guide that shows the teacher how to administer a smallgroup lesson to students who need intervention on the topic.
Independent Practice
A fill in the blank sheet that helps students master the vocabulary of this scope.
Extensions
A set of ideas and activities that can help further elaborate on the concept.
Use this template to decide how to assess your students for concept mastery. Depending on the format of the assessment, you can identify prompts and intended responses that would measure student mastery of the expectation. See the beginning of this scope to identify standards and grade-level expectations.
Student Learning Objectives
The cell theory states that all living organisms are composed of cells, the cell is the basic unit of structure and function in living things, and all cells arise from preexisting cells. This theory holds true for all living things, unicellular or multicellular.
All living things are made up of cells, which are the smallest units that can be said to be alive.
A virus is nonliving, does not have its own metabolism, lacks cellular structure, and is unable to reproduce outside of a host cell.
An organism may consist of one single cell or many different numbers and types of cells.
Unicellular organisms, like multicellular organisms, need food, water, a way to dispose of waste, and an environment in which they can live.
Groups of cells, the smallest units of a plant or animal, form tissues. Tissues with similar structures and functions form organs. Organ systems are the result of various organs working together. Organisms are the sum of all levels of organization operating together.
Does Student Mastery Look Like?

The student is expected to demonstrate understanding of the components of cells, how the components function together to support the lives of prokaryotic and eukaryotic organisms, and how the cells of these organisms are similar and different.
How do tiny parts inside a cell work together to keep different types of living things alive and what makes them similar or different?
Key Concepts
• All living things are made of either prokaryotic cells (archaebacteria and bacteria) or eukaryotic cells (protists, fungi, plants, and animals).
• Prokaryotes are abundant small unicellular organisms that are unorganized (they have single-loop DNA but have no nucleus or membranebound organelles).
• Eukaryotes are unicellular and multicellular organisms with larger cells than prokaryotes. Eukaryotes are organized with membrane-bound organelles and compacted, helix-shaped DNA in a nucleus. Fungi, one group of eukaryotes, are heterotrophic, digest food outside their cells, and have cell walls made of chemicals that are different from those found in plant cell walls. Kingdom Protista is composed of another group of eukaryotic organisms that cannot be classified as animals, plants, or fungi; they have great structural diversity and diverse methods of getting food. Most protists are singlecelled organisms.
• Cells have some structures (organelles) in common, such as a cell membrane (controls movement in and out of a cell), cytoplasm (holds organelles), and DNA (has genetic information). Other organelles include the cell wall (provides support in plants), cilia and flagella (allow movement), the nucleus (controls cell and stores genetic information), mitochondria (produce energy), chloroplasts (capture light for photosynthesis in plants), vacuoles (store water and food), and vesicles (bring in large molecules and release them from a cell).
This unit develops conceptual and applied understanding of cell structure and function. Students activate prior knowledge, model organelles with everyday analogies, and design system-level representations to reveal how structures coordinate to perform life processes. Through observation and comparison of diverse eukaryotic cells, learners classify them into kingdoms and distinguish plant and animal features. Throughout, students connect structure to function and compare prokaryotic and eukaryotic organization, emphasizing commonalities, differences, and interdependence of cell components in sustaining organisms.
The terms below and their definitions can be found in Picture Vocabulary and are embedded in context throughout the scope.
Bacteria
One of the three taxonomic domains; a highly diverse group of single-celled, prokaryotic organisms
Cell Membrane
A lipid barrier that encloses the cytoplasm and controls what enters and exits the cell
Cell Wall
A tough, protective barrier that surrounds the outer membrane of some types of cells
Chloroplast
A membrane-bound organelle in plants that is the site of photosynthesis
Cilia
Hairlike structures on the outside of some cells that produce movement
Cytoplasm
The jellylike material inside the outer membrane of a cell that holds the nucleus, organelles, and other components of the cell
Eukaryotic Cell
A cell with a nucleus and membrane bound organelles
Fungi
Heterotrophic eukaryotes that reproduce through asexual spores, break down dead materials, and can spread disease
Mitochondrion
The organelle that functions in energy production; the power factory of the cell
Multicellular
A category of organisms made up of more than one cell and of different types of cells
Nucleus
A membrane-bound organelle in eukaryotic cells that contains the DNA; the control center of the cell
Organelle
A structure inside a cell that performs a specialized function
Prokaryotic Cell
A cell lacking a nucleus or any other membrane-enclosed organelle
Unicellular
A category of organisms made up of one cell
Vacuole
The organelle that stores water and food in both plant and animal cells Scope
Students model cell structure and function using familiar objects to solidify understanding of parts and their roles.
• Activate prior knowledge about cell parts and their functions.
• Select an everyday object to serve as a model of a cell and its organelles.
• Create a written and/or drawn explanation mapping object features to cell components and the jobs cells perform.
• Use provided cell-part references (including plant vs. animal) while explaining the model; teacher monitors for misconceptions.
Making a Model - Designing a System
Students model how cell structures function together by designing and analyzing an analogous manufacturing system.
• Brainstorm familiar systems and how components work together, connecting the idea to cell organelles and their roles.
• Design a product’s manufacturing process, create a flowchart and floor plan, and align plant/animal cell structures to system components.
• Compare and discuss designs to identify shared processes and specialized functions, including distinctions between plant and animal cells.
Activity - Comparing Cells
Students investigate eukaryotic cell types to classify them into Protista, Fungi, Plantae, or Animalia.
• Observe prepared slides (or conduct online research) to examine protist, fungal, plant, and animal cells.
• Record observations and answer guiding questions in student journals using provided reference sheets.
• Compare and contrast structural features to determine each cell’s kingdom, then discuss class findings.
Notes

Estimated 30 min - 45 min
Students use an everyday object as a model for a cell and its parts. They explain how their object resembles a cell.
Materials
Printed
● 1 Parts of Cells (per student)
● Copy a Parts of Cells document page for each student, or project the page on the board.
● Copy a Plant Cells vs. Animal Cells document for each group.
During this activity, students will develop and use models to describe and predict how tiny parts inside a cell work together to keep different types of living things alive, highlighting similarities and differences. By using everyday objects as models for cells, students will evaluate the limitations of their models, modify them based on evidence, and represent systems and interactions within cells. This process will help them understand unobservable mechanisms and energy flows within cellular systems. Additionally, students will analyze and interpret data to identify similarities and differences in cell structures and functions, enhancing their understanding of the phenomenon.
● 1 Plant Cells vs. Animal Cells (per group) Notes
During this activity, students will use models to represent systems and their interactions by selecting everyday objects to symbolize cells and their parts. This will help them understand how systems may interact with other systems and have sub-systems, as well as how the function of these systems depends on the shapes, composition, and relationships among their parts. By analyzing and describing how their chosen objects resemble cells, students will explore the phenomenon of how tiny parts inside a cell work together to keep different types of living things alive and what makes them similar or different.
1. Instruct students to think about what they know about the parts of cells.
2. Direct students to choose an everyday object that they feel they can use to represent a cell and the parts of the cell.
3. Ask the students to use words and/or drawings to describe their everyday object and how it is similar to a cell and the parts of a cell.
4. As students are working, remind them to consider the jobs a cell needs to be able to do. They should keep this in mind while choosing their everyday object and try to represent those jobs. For example, a student might choose to use a car as a model for his or her cell. The student may include a description of how the doors open and close to allow people in and out of the car and relate that to the cellular membrane.
5. Monitor for misconceptions.
Students may not have the experience and/or capability to generalize knowledge of a real-life example and be able to hypothetically compare it to something completely different. In this activity, students are asked to use an everyday object as a model for a cell and its parts and then explain how the everyday object they selected resembles a cell. This is very abstract and requires access to knowledge that students with disabilities may not have. Some students may especially struggle with this task if they tend to be literal thinkers. Provide a list of everyday examples that could resemble a cell and allow students to select and explain in their own words how their selection could resemble a cell. Find more strategies to help students generalize in the Intervention Toolbox.
Phenomenon Connection
How do the parts of a cell work together to maintain life, and how can we use everyday objects to better understand these cellular functions?
1. Based on your comparison with other classmates, how does your chosen everyday object effectively represent the function of a specific cell part, and what improvements could be made to enhance this representation?
2. If you were to modify your everyday object to represent a different type of cell (e.g., plant vs. animal), what changes would you need to make, and why?
3. How can the interactions between different parts of your everyday object model help us understand the similarities and differences in how plant and animal cells function?
Push students to pick different objects (car, restaurant, house, computer, sports team, etc.) so analogies are more creative and not all the same.

Estimated 1 hr - 2 hrs
Connections L.6.1.3 & 1.4
Students develop and use models to explain how specific cellular components (cell wall, cell membrane, nucleus, chloroplast, vacuole, and mitochondria) function together to support the life of prokaryotic and eukaryotic organisms, including plants, animals, fungi, protists, and bacteria (not to include biochemical function of cells or cell parts), by developing a floor plan of a manufacturing system to model a cell system.
Materials
Printed
● 1 Student Journal (per student, group, or class)
● 2 Cell Structure Labels (per group)
Reusable
● 1 envelope (per group)
● 1 tape, masking (per group)
Consumable
● 1 paper, plain, white, sheet (per group)
● 1 paper, butcher, 1 m (per group)
● 1 pencil, colored, set (per group)
● 1 sticky notes, set (per group)
Preparation
● Student Journals can be printed individually for student use or as a reusable class set, or they can be assigned online.
● Gather materials needed for the activity.
● Print one Cell Structure Labels, and cut the two sets of five labels. Store each set, along with a small stack of sticky notes and a wad of sticky tack, in an envelope.
● Group students if they are not already in groups.
Developing and Using Models
Analyzing and Interpreting Data
During this activity, students will develop and use models to describe how specific cellular components function together to support life in various organisms. By creating a floor plan of a manufacturing system to model a cell system, students will evaluate the limitations of their models, modify them based on evidence, and use them to describe and predict the interactions and energy flows within cell systems. This process will help students understand the similarities and differences in cell structures across different types of living things, providing a mechanistic account of the natural phenomenon of cellular function.
● 1 lab journal (per student) Notes
Systems and system models
Structure and function
During this activity, students will develop and use models to explore how cellular components function together as a system to support life in various organisms. By creating a manufacturing system floor plan as an analogy for a cell, students will understand how systems and subsystems interact, representing inputs, processes, and outputs. They will analyze the structure and function of cell components, recognizing that while models can illustrate these interactions, they are limited in representing the full complexity of cellular systems. This will help them grasp the similarities and differences in cell structures across different types of living organisms.
This activity prompts students to work through the different components of a system, specifically a manufacturing plant, as an analogy to how plant and animal cells work.
1. For the Pre-Activity Discussion, ask student groups to use their lab journals to brainstorm some familiar examples of different specific systems and briefly explain how different parts work together. If students are struggling, you can prompt them to think about specific sports teams, businesses, or complex machines, for example. Instruct the students to take two minutes to write down their lists in their lab journals. Tell them to take about three more minutes to identify each part and describe its role or function. After five minutes, ask each group to share their examples with the class. Use one or more of the shared examples to lead a class discussion identifying how each example is an analogy for how plant and animal cells work. Like the examples, plant and animal cells have different parts, called organelles, which have different jobs within the cell, but they all work together.
○ What are some examples of different kinds of systems in which the different parts, or components, work together? Brainstorm a list of three or more, such as football teams, technology company, car, bike, school, etc.
○ Choose one example from your list, and identify the different components of that system. Our favorite football team is a system with different parts that work together. The parts include quarterback, receiver, offensive lineman, kicker, coach, and sports medicine specialist.
○ For each component, write a complete sentence that describes its primary role or function. The coach directs the team's overall activities (e.g., plays and strategies). The quarterback throws the ball to the best choice as a receiver during a play. The receiver must work to get open, away from the other team's players, to successfully receive and then run with the ball. The offensive lineman must protect the quarterback from the other team's players to give him a chance to successfully pass the ball to a receiver. The kicker either kicks off the ball or attempts a field goal. The sports medicine specialist analyzes and treats injuries to players as needed.
2. Tell the students their challenge is to design a system with a purpose. Within their groups, students are to come up with one business idea for manufacturing a specific product. With that purpose in mind, they are then to figure out how they would design a manufacturing system to produce the item.
3. To begin the activity, give students no more than five minutes to come up with a product idea. Tell them they will have just 10–15 minutes to create their flowchart. You may wish to list the considerations on a classroom board to remind them as they develop the flowchart of their manufacturing process.
4. Their flowchart will help guide them in developing their more detailed floor plan of the manufacturing plant. Provide each group the butcher paper and set of colored pencils. Allow them about 10–15 minutes to complete their floor plans. Again, remind students about the requirements to include.
Project a timer to help students monitor time as they brainstorm.
During sharing, chart their examples on the board to use later when discussing the organelle functions.

FACILITATION TIP
Explain to students that only plants have cell walls and chloroplasts (strength + energy capture).
Notes L.6.1.3 & 1.4
5. When paired groups are ready for Step 4 in the activity, distribute an envelope with the set of Cell Structure Labels, a set of sticky notes, and a wad of sticky tack to each group. Students should use a bit of the sticky tack to adhere each label to the floor plan. Explain to students that the definitions on the Cell Structure Labels will not exactly match what is happening in a group's manufacturing system. However, they should think about the function of each part of the system and decide on matches that are closest. If they discover that a label could be used in more than one spot on a floor plan, they should write the cell structure name on a sticky note and use that for the additional placement.
6. Two of the labels may or may not be used: Cell Wall and Chloroplasts (the latter may be used if a group included an on-site energy-capturing component, such as solar panels). Use this as an opportunity to discuss how those two components are lacking in animal cells. Why do plant cells have these, while animal cells do not?
7. Finish with a class discussion. For future content reference, have students record their answers in complete sentences in their lab journals throughout the discussion.
○ Which components within your own group's manufacturing system could be swapped to keep your product manufacturing working the same way? Explain. Only components that are similar, such as those that transport or store materials or energy, could possibly be swapped with each other. Otherwise, the components have too specific a function, such as a certain way to process materials, to be swapped with any other components.
○ Compare and contrast your system with that of the other group. What are the similarities and differences between them? Draw a Venn diagram in your lab journal, and use it to list some of them. Venn diagrams will commonly list shared characteristics that relate to processes, such as transporting materials, getting or producing energy, storing sub-products, or removing waste; or structures, such as processing areas or some kind of boundary or wall surrounding the facility. Differences may relate to specific kinds of functions or roles that are not included in the floor plans of both groups.
○ Why do you think there are similarities? Why do you think there are differences? Explain. There are similarities because some common needs must be met to make a product, regardless of the kind of product being made. For example, a manufacturing facility has a central control office that oversees activities, as well as some sort of accommodation for transporting raw materials into the facility. The equipment used must have some sort of energy source and be able to use that energy in order to function. Finished products must be transported out of the facility. There are some differences between the facilities of the groups due to the type of product being produced or the different choices the groups make about how exactly the process will flow. There may also be a difference in energy source; for example, one group's facility includes on-site solar panels that produce energy for the facility to use, while a second group's facility uses electricity generated by another facility.
○ If your group's manufacturing facility is an analogy of a plant or animal cell, then what can you conclude about plant and animal cell structures? If our facilities are analogous to plant and animal cells, then the different components of our facilities are like the different cell structures contained within cells. That is, each organelle or cell part has a structure and plays a different role, or does a different job, within the cell. For example, the nucleus acts as the sole control center that coordinates the activities of the other cell structures in the system. The cell membrane contains the other cell structures but also is in charge of monitoring and allowing what goes into and out of the cell.
Sample Student Responses and Answer Key


Think Time/Talk Time
After students complete the Explore lesson, allow them to form groups by numbering off from one to four. Allow them Think Time to answer the questions in their journals. Then, give them Talk Time to discuss their answers with each other. When you call a number, each student with that number should report for his or her group.
Possible questions and sentence stems could be the following:
● Level 1 Knowledge Question: How would you describe a cellular component?
○ Stem: A cellular component is ______ .
● Level 2 Comprehension Question: What can you say about a cellular component?
○ Stem: I can say that a cellular component is ______ .
● Level 3 Application Question: How would you show your understanding of a cellular component?
○ Stem: I would show my understanding of a cellular component by ______
● Level 4 Analysis Question: What is the difference between mitochondria and chloroplasts?
○ Stem: The difference between mitochondria and chloroplasts is ______ .
● Level 5 Synthesis Question: What facts can you compile to determine what a specific cellular component does?
○ Stem: I can determine what a cellular component does by ______ .
● Level 6 Evaluation Question: How could you use the different types of cellular components to describe what a cell is doing internally?
○ Stem: I could use the different types of cellular components to describe a cell's internal activity by ______ .
How do the different components within a cell work together to maintain life, and what similarities or differences exist between these components in various organisms?
1. How do the roles of the cell membrane and nucleus in a cell compare to the roles of the walls and control office in your manufacturing system model?
2. In what ways do the chloroplasts and mitochondria in plant cells differ in function from the energy sources used in your manufacturing system, and why are these differences important?
3. Considering the similarities and differences between plant and animal cells, how might the presence or absence of certain organelles, like the cell wall or chloroplasts, affect the overall function of the cell? L.6.1.3 & 1.4

Estimated 30 min - 45 min
In this activity, students compare and contrast different cells to classify them as protists, fungi, plants, or animals.
Materials
Printed
● 1 Cell Structures (per group)
● 1 Student Journal (per student)
Reusable
● 1 microscope (per group)
● 1 animal-cell prepared microscope slide, such as blood, cheek, or bone cell (per group)
● 1 plant-cell prepared microscope slide, such as a leaf or guard cell (per group)
● 1 protist-cell prepared microscope slide, such as euglena, amoeba, or paramecium (per group)
● 1 fungus-cell prepared microscope slide, such as mold (per group)
● 1 computer with Internet access, optional (per group)
● Create a microscope station for each group with a set of slides with an example of one of the cells for students to observe from each of the eukaryotic kingdoms: Protista, Fungi, Plantae, and Animalia.
● If slides are unavailable, have students conduct research using the Internet to find examples of microscopic cells from each of the four eukaryotic kingdoms.
● Print Cell Structures for each group in your class.
● Print one Student Journal for each student in your class.
Developing and Using Models
Analyzing and Interpreting Data
During this activity, students will develop and use models to describe and predict the phenomenon of how tiny parts inside a cell work together to keep different types of living things alive and what makes them similar or different. By comparing and contrasting different cells to classify them as protists, fungi, plants, or animals, students will evaluate limitations of models, develop or modify models based on evidence, and analyze data to determine similarities and differences in findings. This will help them understand the interactions and energy flows within systems at unobservable scales.
Systems and system models
Structure and function
During this activity, students will use models to represent systems and their interactions by examining and comparing different cell types. They will explore how the structure and function of cells from different eukaryotic kingdoms contribute to the larger system of living organisms, analyzing how these microscopic structures interact and function within their respective systems. This will help them understand the phenomenon of how tiny parts inside a cell work together to keep different types of living things alive and what makes them similar or different.
1. Have students examine their Student Reference Sheets to compare and contrast each of the eukaryotic cells.
2. Direct students to record answers in their Student Journal.
3. Have students observe the corresponding microscope slides that are related to the four eukaryotic kingdoms. Allow students to analyze each microscope slide to determine which kingdom is represented. If slides are unavailable, have students conduct research using the Internet to find examples of microscopic cells from each of the four eukaryotic kingdoms.
4. Have students answer the corresponding questions about each of the cells they observe.
5. Discuss similarities and differences of each cell type as a class.
After the students have a chance to explore, place them in a circle in an open area. Explain to them that you will say some sentences about the activity out loud. If they agree with the statement, they should walk into the inside of the circle and stand facing someone who does not agree with the statement. Then, they can discuss why they agree or disagree with the statement. Be sure to model the game before beginning.
How do the structures within different types of cells contribute to the survival of various living organisms, and what similarities and differences can we observe among these cells?
1. Based on your observations, what are the key structural differences between plant, animal, protist, and fungi cells, and how might these differences relate to their functions in keeping organisms alive?
2. How do the organelles within these different cell types work together to perform essential life processes, and what similarities can we find in their functions across different kingdoms?
3. Considering the diversity of cell types, what might this suggest about the evolutionary relationships between protists, fungi, plants, and animals?
Notes
FACILITATION TIP
Encourage students to start with obvious features (e.g., cell wall present/absent, chloroplasts present/absent) before moving to subtler distinctions (e.g., vacuole size, nucleus shape). This prevents them from feeling overwhelmed.
FACILITATION TIP
You can also project different images of slides. If you choose that option, be sure to show an example of a 100-400 magnification as well as an example of and electron microscope image. This allows you to spiral in how technology has impacted scientific discovery.
L.6.1.3 & 1.4

1.4
STEMscopedia
Reference materials that includes parent connections, career connections, technology, and science news.
Linking Literacy
Strategies to help students comprehend difficult informational text.
Picture Vocabulary
A slide presentation of important vocabulary terms along with a picture and definition.
Content Connections Video
A video-based activity where students watch a video clip that relates to the scope’s content and answer questions.
Career Connections - Hematopathologist
STEM careers come to life with these leveled career exploration videos and student guides designed to take the learning further.
Math Connections
A practice that uses grade-level appropriate math activities to address the concept.
Reading Science - Prokaryotic and Eukaryotic Cells
A reading passage about the concept, which includes five to eight comprehension questions.
Notes
Claim-Evidence-Reasoning
An assessment in which students write a scientific explanation to show their understanding of the concept in a way that uses evidence.
Multiple Choice Assessment
A standards-based assessment designed to gauge students’ understanding of the science concept using their selections of the best possible answers from a list of choices
Open-Ended Response Assessment
A short-answer and essay assessment to evaluate student mastery of the concept.
Guided Practice
A guide that shows the teacher how to administer a smallgroup lesson to students who need intervention on the topic.
Independent Practice
A fill in the blank sheet that helps students master the vocabulary of this scope.
Extensions
A set of ideas and activities that can help further elaborate on the concept.
Use this template to decide how to assess your students for concept mastery. Depending on the format of the assessment, you can identify prompts and intended responses that would measure student mastery of the expectation. See the beginning of this scope to identify standards and grade-level expectations.
Student Learning Objectives
All living things are made of either prokaryotic cells (archaebacteria and bacteria) or eukaryotic cells (protists, fungi, plants, and animals).
Prokaryotes are abundant small unicellular organisms that are unorganized (they have singleloop DNA but have no nucleus or membrane-bound organelles).
Eukaryotes are unicellular and multicellular organisms with larger cells than prokaryotes. Eukaryotes are organized with membranebound organelles and compacted, helix-shaped DNA in a nucleus. Fungi, one group of eukaryotes, are heterotrophic, digest food outside their cells, and have cell walls made of chemicals that are different from those found in plant cell walls. Kingdom Protista is composed of another group of eukaryotic organisms that cannot be classified as animals, plants, or fungi; they have great structural diversity and diverse methods of getting food. Most protists are single-celled organisms.
Cells have some structures (organelles) in common, such as a cell membrane (controls movement in and out of a cell), cytoplasm (holds organelles), and DNA (has genetic information). Other organelles include the cell wall (provides support in plants), cilia and flagella (allow movement), the nucleus (controls cell and stores genetic information), mitochondria (produce energy), chloroplasts (capture light for photosynthesis in plants), vacuoles (store water and food), and vesicles (bring in large molecules and release them from a cell).

Student Expectations
The student is expected to demonstrate an understanding of the relationships among survival, environmental changes, and diversity as they relate to populations and the environment.
How do different animals and plants survive and adapt when their environment changes, and why are some species more successful than others in these situations?
Key Concepts
• The biotic components of an ecosystem include all organisms composed of cells, from unicellular fungi and bacteria to the wide variety of multicellular organisms that permanently live in or migrate through the ecosystem.
• The abiotic factors of an environment are all the nonliving components, which include temperature range, available sunlight, water, soil, and seasonal variations.
• The study of the biosphere is ordered into different levels to understand how each fits into a larger system, ranging from the largest and most diverse level, the ecosystem, to communities, populations, and the smallest and least diverse level, the organism.
• Environmental changes and limiting factors, such as deforestation, disease, human activities, floods, droughts, and fires, bring changes in resources that will cause some organisms or populations to perish or move and permit other organisms or populations to thrive.
This unit develops students’ understanding of how living and nonliving components interact within ecosystems and how those interactions influence population survival and diversity. Students classify biotic and abiotic factors, analyze ecosystem images for component relationships, and model the ecological levels of organization across biomes. They examine how environmental changes—including invasive species and catastrophic events—disrupt populations, track patterns of impact and recovery, and reason about predictable versus variable outcomes, aligning evidence-based explanations with the expectation.
The terms below and their definitions can be found in Picture Vocabulary and are embedded in context throughout the scope.
Abiotic Factor
A nonliving thing that affects the ecosystem
Biome
A type of biological community defined by its predominant plants, animals, and environmental conditions
Biosphere
The sum of all living matter on Earth
Biotic Factor
A living thing that affects the ecosystem
Community
All the populations of different species in a particular area
Deforestation
Removal of a forest or section of trees for human use
Disease
A disorder in an organism that produces adverse effects and is not a result of physical injury; can be identified by specific signs or symptoms and can affect one or more parts of the organism
Diversity
The quality or state of having many different forms, types, ideas, etc.
Ecosystem
A system comprising all the biotic and abiotic factors in an area and all the interactions among them
Limiting Factor
Biotic or abiotic environmental factor that restricts the growth of a population
Long-Term Environmental Change
A change to the environment that occurs over a long period.
Population
A group of interacting individuals of the same species located in the same area
Species
A group of organisms with similar characteristics that are able to interbreed or exchange genetic material
Notes
Students use a prediction game to distinguish living and nonliving components of ecosystems.
• Make yes/no predictions about a series of examples using thumbs up/down and stand/sit cues.
• Analyze patterns in items (e.g., animals, plants, weather, machines) to infer the underlying rule.
• Identify the distinction between living and nonliving and apply the terms biotic and abiotic.
• Participate in a brief whole-class reveal to solidify vocabulary and understanding.
Students analyze a pond ecosystem image to identify components and interactions and classify them as living or nonliving.
• Observe a pond photograph and record individual observations, then contribute to a class master list.
• Re-examine the image to identify and document interactions within the ecosystem, followed by a class discussion to compile examples.
• Classify items into biotic and abiotic categories using a T-chart, culminating in a discussion on the relative importance of identified components.
Making a Model - Organization and Interactions in an Environment
Students investigate and model ecological levels of organization within assigned biomes.
• Research an assigned biome and identify species, populations, communities, ecosystems, and the biome level using Student Journals.
• Design and build a physical model (e.g., stacked components) that represents the five levels of organization and related biotic/ abiotic factors.
• Share and refine understanding through a gallery walk, recording insights from peers’ models on provided triangles.
Students investigate how environmental changes cause population shifts in ecosystems through discussion, analysis, and modeling.
• Students record predictions, take a four-corners stance on an invasive species scenario, and justify reasoning to define invasive species using the kudzu/kudzu bug context.
• In groups, students brainstorm catastrophic events and their effects, analyze disruptive event scenarios, and create a timeline modeling ecosystem changes.
• Whole-class debrief focuses on how event scale influences impacts and which variables in recovery are predictable versus less predictable.
Notes

Estimated 15 min - 30 min
In this activity, students classify biotic and abiotic factors of ecosystems.
Materials
Printed
● 1 Read My Mind (per class)
Reusable
● 1 projector or whiteboard (per class)
SEP Connection
Developing and Using Models
Analyzing and Interpreting Data
● Prepare to project the Read My Mind document, or copy the list onto the whiteboard. If copying the list from the table, copy everything in black but NOT the red text.
Obtaining, Evaluating, and Communicating Information
Asking Questions and Defining Problems
During this activity, students will develop and use models to describe and predict how different animals and plants survive and adapt when their environment changes. By classifying biotic and abiotic factors of ecosystems, students will evaluate the limitations of their models and modify them based on evidence to understand why some species are more successful than others. This process will involve analyzing and interpreting data to identify patterns and relationships, and obtaining, evaluating, and communicating information to support their findings.
Cause and effect: Mechanism and explanation, Systems and system models, and Stability and Change
During this activity, students will explore cause and effect relationships by classifying biotic and abiotic factors in ecosystems. They will predict phenomena related to how different animals and plants survive and adapt when their environment changes. This will help them understand that some species are more successful than others due to various causal factors, and they will use models to represent these systems and their interactions. Additionally, students will examine stability and change by considering how changes in one part of an ecosystem can impact others, recognizing that stability can be affected by both sudden and gradual changes.
Notes
1. Tell your students they are playing a game to try to read your mind. Refer students to the list you have projected or written on the board. Point out that next to item 1, a dog barking, the response is yes and that next to item 2, a thunderstorm, the response is no.
2. Now, challenge the students by asking, "Can anyone predict what I will put (either yes or no) for item 3, a leaf that is swaying gently on its stem?" Tell them to give a thumbs up if they think it will be yes and a thumbs down if they think it will be no. Pause, ask for a thumb sign, and glance around the class. Write yes for item 3.
3. Pause, then ask if they can read your mind and predict (with a thumbs up, or a thumbs down) what you will write for item 4, the blades of a windmill. Pause, ask for the thumb sign, and then write no for the blades of the windmill.
4. Add a twist: tell everyone who thinks they can predict what you will write for item 5, a jet airplane that you hear in the distance, to stand up. Tell them if they continue to be right, they can remain standing, but if their prediction is wrong, they must sit down again. Some students will stand.
5. Pause, ask the whole class for the thumb sign (whether they are sitting or standing), and then write no for item 5. Students with thumbs up sit down; students with thumbs down remain standing. Some students may have thumbs down but not really know why they made the right prediction. Explain to them that they have to continue making the correct prediction to remain standing.
6. Say that anyone who thinks they know what you will write for number 6, a bird flying into a tree, should stand up. Ask for the thumb sign, then write yes for item 6. Those with thumbs up remain standing, and those with thumbs down must sit down. Remind students that they must continue to make the correct prediction to remain standing.
7. By this time, you might have a few students who have determined that you are thinking about living and nonliving things. Tell them not to give away the answer as you continue the game. Continue each round by asking students to stand if they think they can predict what you will write; then ask for the thumb sign, write yes or no, and have students either remain standing if correct or sit down if not correct.
8. When all students have figured out that you are thinking about living and nonliving things (or at the end of item 15), explain to students that scientists call living things in an ecosystem "biotic factors" and nonliving things "abiotic factors."
Encourage reasoning, not guessing . After a few rounds, ask volunteers to explain why they predicted yes/no instead of just giving the thumbs sign. This shifts focus from chance to critical thinking.
3.3
L.6.3.1

L.6.3.1 - 3.3 Ecosystems Engage
9. Explain that the word biotic is from the Greek word biotiks and means "pertaining to life." Write biotic and abiotic on the board.
○ A dog barking Yes
Clarify living vs. nonliving. Emphasize that biotic equals living or once-living. For example, shrimp and plankton are living, but water (Gulf of Mexico) is abiotic.
○ A thunderstorm No
○ A leaf that is swaying gently on its stem Yes
○ The blades of a windmill No
○ A jet airplane that you can hear in the distance No
○ A bird flying up into a tree Yes
○ The road in front of the school No
○ A flowing stream No
○ The smoke released from a factory No
○ A cave No
○ A tree that you saw on the way to school Yes
○ An ant crawling on a blade of grass Yes
○ The Gulf of Mexico No
○ Shrimp harvested from the Gulf of Mexico Yes
○ Plankton Yes
When ecosystems change, how do the interactions between biotic and abiotic factors influence the survival and adaptation of different species, and why do some species thrive while others struggle?
1. How do biotic factors, like plants and animals, interact with abiotic factors in an ecosystem to adapt to environmental changes?
2. In what ways might the classification of factors as biotic or abiotic help us understand why some species are more successful in adapting to changes than others?
3. Can you think of an example where a change in an abiotic factor led to a significant impact on a biotic factor within an ecosystem? How did this change affect the overall ecosystem?
Notes

Estimated 30 min - 45 min
Students observe a photo of a pond to define biotic and abiotic interactions within a pond ecosystem.
Materials
Printed
● 1 Student Journal (per student)
● 1 Slideshow (per class)
Reusable
● Computer with projector (per class)
● Print one Student Journal for each student.
● Project the Slideshow for the class to observe.
Developing and Using Models
Analyzing and Interpreting Data
Obtaining, Evaluating, and Communicating Information
Asking Questions and Defining Problems
During this activity, students will develop and use models to describe and predict the interactions within a pond ecosystem, focusing on how biotic and abiotic factors influence survival and adaptation. By analyzing and interpreting their observations, students will evaluate the limitations of their models and refine them to provide a mechanistic account of the phenomenon of species adaptation and survival in changing environments. This process will help students understand why some species are more successful than others in adapting to environmental changes.
Notes
Cause and effect: Mechanism and explanation, Systems and system models, and Stability and Change
During this activity, students will use cause and effect relationships to predict how different animals and plants survive and adapt when their environment changes, recognizing that these phenomena may have more than one cause. By examining the pond ecosystem, students will classify interactions as causal or correlational and understand that correlation does not necessarily imply causation. They will also explore how systems and subsystems interact within the pond, using models to represent these interactions and considering stability and change over time, including how sudden or gradual changes can impact the ecosystem’s equilibrium.
1. Pass out the Student Journal, and project the image of the pond.
2. Give students a few minutes to observe the photograph and record their observations.
3. Hold a discussion as to what students observe in the picture. List these observations on the board to create a master list.
4. Ask students to add to their list as needed.
5. Have students look at the image again, but this time prompt them to observe what is happening in the photograph. What interactions are taking place?
6. Give students a few minutes to observe and record.
7. Hold a discussion as a class. Create a master list of interactions.
8. Ask students to add to their list as needed.
9. Lastly, as they identify items, have students begin to fill in items on their T-chart of biotic (living) versus abiotic (nonliving) items. Remind students the definition of these terms from the Engage activity. Provide clarification of the meaning of each term as needed.
10. Conclude the lesson by asking students which items they think are more important. Hold a class discussion.
Students may have trouble differentiating between and remembering the differences between biotic and abiotic factors. Have students complete a Venn diagram or T-chart to serve as a visual aid to help them fully comprehend the difference between abiotic and biotic factors. Creating a diagram or chart will also give students a reference tool to use in future investigations. Learn more strategies to help students learn new vocabulary in the Intervention Toolbox.
Notes
Have students share observations with a partner before the class list. This allows quieter students to contribute ideas and increases the diversity of responses.
Remind students that moving water is abiotic (not alive), but organisms within it (fish, plankton) are biotic. Also stress that once-living things (fallen leaves, dead trees) still count as biotic.
3.3

Sentence Stems
Inform students that they will be making a claim concerning either a biotic or an abiotic factor from the Explore. Then, allow students to complete the following sentence stems:
● My claim is ________.
● My evidence is ________ .
● My reasoning is ________.
● I heard you say ________, and I have not thought about that before. However, I think ________.
Let students work in pairs to develop their thoughts. After completing the sentences, have students trade sentences with their partner, read that student’s reasoning, and ask questions to make sure they understand what was written. Then, instruct students to write either a rebuttal to or a reflection on their partner’s responses.
How do the interactions between biotic and abiotic factors in a pond ecosystem help certain species adapt and survive better than others when environmental changes occur?
1. Based on your observations, how do the biotic and abiotic interactions in the pond ecosystem support the survival of certain species over others?
2. How might changes in the abiotic factors, such as temperature or water levels, impact the biotic components of the pond ecosystem?
3. Can you think of a species in the pond ecosystem that might be more successful in adapting to changes? What characteristics or interactions contribute to its success?

Estimated 2 hrs - 3 hrs
Explore 2: Making a Model - Organization and Interactions in an Environment
Students develop and use models to describe the levels of organization for a species in a biome.
Materials
Printed
● 1 Student Journal (per student)
Reusable
● 1 camera, digital (per group)
● 1 computer (per group)
Consumable
● Plastic or Styrofoam cups (per group)
● Wire coat hangers (per group)
● Yarn or string (per group)
● Poster board (per group)
● Paper (per group)
● 1 lab journal (per student)
● Create a list of biomes for students to choose from on a whiteboard. Have groups draw for a biome from a hat, or assign biomes randomly.
○ Freshwater biome
○ Marine biome
○ Desert
○ Tropical rain forest
○ Temperate rain forest
○ Temperate deciduous forest
○ Taiga
○ Tundra
○ Grassland
Developing and Using Models
Analyzing and Interpreting Data
Obtaining, Evaluating, and Communicating Information
Asking Questions and Defining Problems
During this activity, students will develop and use models to describe the levels of organization for a species in a biome, allowing them to predict and explain how different animals and plants survive and adapt when their environment changes. By constructing and analyzing these models, students will evaluate the limitations of their models and modify them based on evidence to reflect changes in variables or components of the system. This process will help them understand why some species are more successful than others in adapting to environmental changes.
Cause and effect: Mechanism and explanation, Systems and system models, and Stability and Change
During this activity, students will develop and use models to describe the levels of organization for a species in a biome, allowing them to explore cause and effect relationships by predicting how different animals and plants survive and adapt when their environment changes. By examining these models, students can classify relationships as causal or correlational, understand the interactions within and between systems, and explain stability and change in natural systems.
1. Pass out a Student Journal to each student.
2. Open the activity with a background discussion about the levels of organization in an ecosystem. Draw a triangle on the board, and moving from the bottom to the top, write Biome, Ecosystem, Community, Population, and Species.
○ What is a species? A species is any single type of living organism within its environment. Examples include lions, humans, cats, dogs, etc.
○ What is the purpose of utilizing the levels of organization in an ecosystem? The purpose is to show how biomes are organized from the smallest to largest levels and to show the relationships among species and their abiotic and other biotic factors at each level.
○ What level of organization would include abiotic factors? Ecosystem
3. Place students in small groups, and decide which biome they will be researching.
4. Have students research the various levels of organization for their biome using Internet devices. Remind students to fill in these levels on their triangles provided in the Student Journal.
5. Using the level-of-organization triangles, tell students that they will be developing a model to describe the levels of organization in their assigned biome. They may make a model using various materials.
6. Have students use their Student Journal to guide them through the planning and building process.
7. If needed, guide students to the idea that they could use Styrofoam or plastic cups for their model, with more cups labeled with various abiotic and biotic factors to represent the largest level of organization (biome). Stack the cups up five levels tall, using only one cup on the top to represent a species. Write out the organism names, or draw/print out different images of organisms on each of the cups to represent the organisms that would be in each of the levels.
8. Once the students' models have been constructed, have students conduct a gallery walk of the other groups' models, and have additional blank triangles for students to fill in from other students' models at the end of the Student Journal.
Start with familiar examples. Before introducing the triangle, walk through a local example (e.g., backyard, park, pond). Ask: “What is one species we might see here?” Build up through population, community, ecosystem, and biome with student input.
Give students guiding questions for the gallery walk (e.g., “What similarities do you notice across models?” “What unique factors did another group include that your group missed?”).
3.3

Explore 2: Making a Model - Organization and Interactions in an Environment
English Language Proficiency
Card Sort
Through this task, students demonstrate an understanding of relationships in an ecosystem.
Create a set of cards that have different vocabulary terms from this scope: biotic, abiotic, freshwater biome, marine biome, desert, tropical rain forest, temperate rain forest, temperate deciduous forest, taiga, tundra, grassland, population, species, community, and ecosystem. Make a matching set of cards with nonlinguistic representations of these terms, such as an image. Make enough matching sets for students to work in groups of two.
Have students work with a partner to match the vocabulary terms with their representations. Allow time for students to discuss their choices with other pairs.
Phenomenon Connection
When environments change, how do different species within a biome adapt and survive, and why are some species more successful than others in these situations?
1. Based on your research and models, how do the abiotic and biotic factors in your assigned biome influence the survival and adaptation strategies of species?
2. How might the levels of organization within a biome help us understand why some species are more resilient to environmental changes than others?
3. Considering the gallery walk and comparisons with other groups, what adaptations or strategies did you find most effective for species survival across different biomes?
Notes

Estimated 1 hr - 2 hrs
In this activity, students analyze cause-and-effect relationships to explore how changes in the physical environment can lead to population changes within an ecosystem.
Materials
Printed
● 1 Student Journal (per student)
● 1 Before and After (per group)
Consumable
● 1 lab journal (per student)
SEP Connection
Developing and Using Models Analyzing and Interpreting Data
● For Part I, designate an area in the room for each student prediction (Student A, B, C, and D) where students may group themselves.
● For Part II, Student Journals can be printed individually for student use or as a reusable class set, or they may be assigned online. Print one copy of the Disruptive Event Scenarios for each group.
Obtaining, Evaluating, and Communicating Information Asking Questions and Defining Problems
During this activity, students will develop and use models to describe and predict how different animals and plants survive and adapt when their environment changes. They will evaluate the limitations of these models and modify them based on evidence to match changes in variables or components of an ecosystem. By analyzing and interpreting data, students will identify cause-and-effect relationships and determine the impact of invasive species and natural disasters on ecosystems, thereby gaining insights into why some species are more successful than others in adapting to environmental changes.
Notes
CCC Connection
Cause and effect: Mechanism and explanation, Systems and system models, and Stability and Change
During this activity, students will analyze cause-and-effect relationships to explore how changes in the physical environment can lead to population changes within an ecosystem. They will classify relationships as causal or correlational, recognizing that correlation does not necessarily imply causation. By examining the introduction of invasive species and the impact of natural disasters, students will predict phenomena in natural systems and understand that these phenomena may have more than one cause. They will also use models to represent systems and their interactions, considering stability and change over time, and how systems in dynamic equilibrium can be disturbed by sudden events or gradual changes.
1. Have students complete the Student Journal page and answer the questions.
2. After students have had time to record their answer, have them stand in the corner that corresponds to the response with which they most strongly agree (i.e., Student A, B, C, or D).
3. Allow students to discuss their choices; remind them to make sure to provide an explanation as to why they agree or disagree with each response.
4. Have a discussion about their choices:
○ Out of the four student responses, which one do you agree with the most? Explain your thinking. Allow students to debate their reasoning; or assemble the room into four corners, and have students discuss which student is most correct. Assuming that kudzu bugs, which were indigenous to the kudzu plant, have now been introduced into the ecosystem, they would serve as a new food source for the frog population, which would lead to Student A's statement being correct.
○ Based on the events listed in this ecosystem, how would you define an invasive species? The events from this island help me to describe an invasive species as a new or emerging species that enters an ecosystem when it was not originally a part of the ecosystem.
○ How has the introduction of kudzu impacted this ecosystem? Kudzu bugs, which were indigenous to the kudzu plant, have now been introduced into the ecosystem and serve as a new food source for the frog population. It also creates competition for resources between the frog and the grasshopper.
○ Besides the introduction of invasive species, what is another way an ecosystem can change? Accept all student answers, including natural disasters such as hurricanes, forest fires, deforestation, pollution, etc.
1. Begin with a discussion:
○ What are some catastrophic events that can affect ecosystems? Floods, fires, hurricanes, tornadoes, pollution, etc.
○ What effects can catastrophic events have on an ecosystem? Example answers: destroy homes, destroy or cause food source to leave, pollute or destroy water source
○ How can we determine the effects such an event has had on an ecosystem? Accept all ideas. Some responses may include surveys and other scientific studies of an area.
2. Have students work in groups of four to complete this task. Students should write answers to the question prompts in their lab journals.
3. As students review and analyze the Disruptive Event Scenarios, you may wish to provide some guidance as the groups discuss each set of images.
4. When students choose one of the scenarios to create the timeline representation, suggest that students leave plenty of room around the line itself to fill in the details. Students should rely on what they already know and can reasonably predict to complete their timeline.
Before students move, remind them: “There are no wrong answers at this stage. Your job is to justify your reasoning.”
Reinforce that invasive species:
Are non-native to the ecosystem
Spread quickly
Compete with or displace native species
Write a student-friendly definition on the board as a class consensus.

5. Wrap up with a discussion of their observations:
Differentiate Predictable vs. Unpredictable
Predictable: basic recovery processes (plants regrow, soil stabilizes).
Unpredictable: sudden invasive species, unusual weather shifts, human intervention.
Encourage students to color-code their timeline to show which effects are predictable vs. unpredictable.
○ Discuss how the scale of a disruptive event affects changes to an ecosystem. The larger the scale of a disruptive event, the greater the impact on an ecosystem. A large-scale event can wipe out whole populations of species or drastically change the abiotic conditions of an area. A small-scale event might temporarily wipe out the species living in an area, but the adjacent colonies often repopulate the gap relatively quickly.
○ After a disruptive event, many variables factor into how the ecosystem will be affected. Which variables are predictable, and which are less predictable? Predictable variables include general climate conditions, unaffected neighboring species, and the underlying geology and soil conditions. Less predictable variables include invasive species that may find their way to the area more quickly; deeper geological changes that may have significantly shifted the soil and water dynamics (thereby causing the environment to no longer be suitable for at least some of the species that previously lived in the affected area); climatic variations, such as unusually wet or dry years; and the occurrence of other large or small natural disturbances.
Sentence Stems
Allow the students to use the following sentence stems to help them determine the outcome of their disruptive event.
● The situation is ______________________________.
● The event will hurt plants because ___________________.
● The event will hurt animals because _________________.
● The harmful effect this has on the environment is _________________________.
● The helpful effect this has on the environment is _____________________.
● The most immediate effect the event has is ___________________________________
When an ecosystem undergoes changes, how do different species adapt to survive, and why are some species more successful than others in these situations?
1. How do invasive species, like the kudzu bugs, impact the survival and adaptation of native species within an ecosystem?
2. In what ways can natural disasters alter the balance of an ecosystem, and how might different species respond to these changes?
3. What factors determine whether a species will thrive or struggle when faced with environmental changes, and how can we predict these outcomes?

L.6.3.1 - 3.3
STEMscopedia
Reference materials that includes parent connections, career connections, technology, and science news.
Linking Literacy
Strategies to help students comprehend difficult informational text.
Picture Vocabulary
A slide presentation of important vocabulary terms along with a picture and definition.
Content Connections Video
A video-based activity where students watch a video clip that relates to the scope’s content and answer questions.
Career Connections - Farmer
STEM careers come to life with these leveled career exploration videos and student guides designed to take the learning further.
Math Connections
A practice that uses grade-level appropriate math activities to address the concept.
Reading Science - Otters and Urchins
A reading passage about the concept, which includes five to eight comprehension questions.
Notes
Claim-Evidence-Reasoning
An assessment in which students write a scientific explanation to show their understanding of the concept in a way that uses evidence.
Multiple Choice Assessment
A standards-based assessment designed to gauge students’ understanding of the science concept using their selections of the best possible answers from a list of choices
Open-Ended Response Assessment
A short-answer and essay assessment to evaluate student mastery of the concept.
Guided Practice
A guide that shows the teacher how to administer a smallgroup lesson to students who need intervention on the topic.
Independent Practice
A fill in the blank sheet that helps students master the vocabulary of this scope.
Extensions
A set of ideas and activities that can help further elaborate on the concept.
Use this template to decide how to assess your students for concept mastery. Depending on the format of the assessment, you can identify prompts and intended responses that would measure student mastery of the expectation. See the beginning of this scope to identify standards and grade-level expectations.
The biotic components of an ecosystem include all organisms composed of cells, from unicellular fungi and bacteria to the wide variety of multicellular organisms that permanently live in or migrate through the ecosystem.
The abiotic factors of an environment are all the nonliving components, which include temperature range, available sunlight, water, soil, and seasonal variations.
The study of the biosphere is ordered into different levels to understand how each fits into a larger system, ranging from the largest and most diverse level, the ecosystem, to communities, populations, and the smallest and least diverse level, the organism.
Environmental changes and limiting factors, such as deforestation, disease, human activities, floods, droughts, and fires, bring changes in resources that will cause some organisms or populations to perish or move and permit other organisms or populations to thrive.

Student Expectations
The student is expected to demonstrate an understanding of the interactions of organisms, including competitive or mutually beneficial relationships, and the transfer of energy through an ecosystem.
How do plants, animals, and tiny organisms work together to share energy and resources in a forest?
Key Concepts
• Some interactions benefit both individuals involved, whereas others benefit one individual to the detriment of another.
• Competition occurs when ecological niches overlap and multiple organisms seek the same biotic or abiotic resources.
• Predation (predator consumes prey), parasitism (parasite consumes host), and herbivory (herbivore eats, but does not destroy, the plant) are interspecific interactions in which one organism consumes another to obtain resources.
• Symbiotic relationships can be mutualistic (both organisms benefit), parasitic (only one organism benefits), or commensal (one organism benefits and the other is unaffected).
• Food chains diagram the transfer of energy as it flows from the Sun to producers (autotrophs) to consumers (heterotrophs).
• Food webs diagram the complex relationships of energy flow in an ecosystem containing a variety of producers, consumers, and decomposers.
• Energy pyramids diagram the decreasing amount of available energy as it flows from one trophic level to the next, moving from producers at the bottom of the food pyramid to tertiary consumers at the top of the food pyramid.
This unit develops understanding of how organisms interact and how energy moves through ecosystems. Through analysis, matching, classification, and modeling, students identify and justify competitive, predatory, cooperative, and symbiotic relationships (mutualism, commensalism), distinguish interaction types within food webs, and build representations of food chains, webs, and energy pyramids. Students trace direction of energy flow and explain decreasing energy at higher trophic levels, using precise vocabulary and collaborative reasoning to connect interactions to ecosystem stability, meeting the stated expectation.
The terms below and their definitions can be found in Picture Vocabulary and are embedded in context throughout the scope.
Autotroph
An organism that makes its own food
Commensalism
An interaction between organisms or species that is helpful to one but neither helpful nor harmful to the other
Competition
When more than one individual or population in an ecosystem relies on the same limited resources
Energy Pyramid
A diagram that shows the total amount of energy contained within each trophic level
Heterotroph
An organism that must consume other organisms for energy
Mutualism
A relationship between organisms or species that is helpful to both
Parasitism
A relationship between organisms of different species where one organism benefits at the expense of the other
Predation
The interaction between two animals in which one animal eats the other
Tertiary Consumer
An organism that gets its energy by eating secondary consumers
Trophic Level
The position an organism occupies on the food web
Notes
Students explore how organisms interact within ecosystems by identifying, modeling, and classifying relationship types.
• Analyze an image prompt to infer interaction types (e.g., competition) and justify reasoning.
• In groups, draw relationship cards and act out skits while peers identify the interaction.
• Collaboratively sort examples into a T-chart (symbiosis vs. food web interactions) and label each relationship.
• Create reference flashcards for key terms and conclude with a brief discussion on interaction balance in ecosystems.
Activity - Matching Symbiotic Buddies
Students explore organism interactions by matching organism “dates” that represent different ecological relationships.
• Discuss real-world examples of predation, competition, cooperation, and symbiosis to activate prior knowledge.
• Use invitation cards to find a matching partner whose organism forms the specified interaction; identify roles (e.g., predator/prey, mutualism, commensalism) and record findings.
• Debrief as a class to justify pairings, determine contested resources, and summarize how each interaction functions in an ecosystem.
Activity - Analyzing Food Webs
Students collaboratively model energy transfer in ecosystems through hands-on and visual representations.
• Use organism roles to build a class food web with yarn, identifying producers, consumers (herbivores, omnivores, carnivores), and decomposers.
• Record the web and construct additional models (food chains and an energy pyramid) to represent interconnected feeding relationships.
• Explain the direction of energy flow and the decreasing energy available at higher trophic levels.
• Complete journal reflections to synthesize observations and conclusions.
& 3.5

Estimated 30 min - 45 min
Students investigate organism interactions in a competitive or mutually beneficial relationship (predation, competition, cooperation, or symbiotic relationships).
Materials
Printed
● 1 Relationship Drama (optional) (per student)
● 1 Relationship Description Cards (per class)
● 1 Slideshow (per class)
Reusable
● 1 computer with projector (per class)
Consumable
● 1 lab journal (per student)
● Note cards
● Print (on card stock) and cut out Relationship Description Cards. During the activity, groups will randomly draw a strip from the box to determine what they will act out for the class.
● Draw a large, blank T-chart on the board. Do not record headings in the chart at this time.
● (Optional) Print Relationship Drama charts for students if you'd wish to give it to them instead of having them copy yours down from the board.
SEP Connection
Analyzing and Interpreting Data and Obtaining, Evaluating, and Communicating Information
During this activity, students will analyze and interpret data to provide evidence for how plants, animals, and tiny organisms work together to share energy and resources in a forest. By acting out and identifying different organism interactions, students will construct and interpret graphical displays of data to distinguish between causal and correlational relationships. They will also evaluate and communicate scientific information about these relationships, integrating qualitative and quantitative data to clarify their findings and enhance their understanding of ecosystem dynamics.
CCC Connection
Cause and effect: Mechanism and explanation, and Energy and matter: Flows, cycles, and conservation, and Stability and change
During this activity, students will explore cause and effect relationships by investigating how plants, animals, and tiny organisms interact in a forest ecosystem. They will classify these interactions as competitive or mutually beneficial, and understand how these relationships contribute to the transfer of energy and cycling of matter within the system. By acting out different ecological interactions, students will predict how changes in one part of the system can affect the stability and balance of the entire ecosystem, recognizing that these phenomena may have multiple causes and can be described using probability.
Notes
1. Before beginning the activity, project the image of the fighting deer in the Slideshow (first slide) and ask these questions:
○ What is an ecosystem? A natural environment in which a group of organisms live and interact
○ What different kinds of interactions might we see between living things within an ecosystem? Students may give examples of predator-prey, plant-eating, parasitic, or symbiotic relationships including mutualism, commensalism, or parasitism.
2. Ask students what is occurring in the slide. Encourage students to discuss what processes may lead to the deer doing this, what advantages it creates for the deer population, what adaptations the deer have to help them in this situation, or why the risk of the fight is worth the reward of passing on their genes. Students should determine why the image exhibits competition and defend their reasoning.
3. Organize the students into 10 groups, and have one student per group randomly draw a card from the box to determine what the group will act out for the class. Give students two to three minutes to decide how they will act it out.
4. Project the second slide of the Slideshow (all of the relationship descriptions).
5. Have the group with card 1 act out their skit first. Have the other students try to guess which description on the board the group is acting out.
6. When a group guesses correctly, write down the description in the T-chart. Do not record headings in the T-chart until the very end! Be sure to record all symbiotic relationships on the left and food web relationships on the right (see the Key). Tell the students that the relationship has a scientific name, and then say and record the name on the T-chart. You may have students record the T-chart in their lab journals as you go through each group.
7. Repeat steps 5 and 6, through card 3.
8. Ask students what the descriptions on the left of the T-chart have in common (they are all close relationships between species). Tell students that this type of relationship has a scientific name: symbiosis. Label the left heading of the T-chart Symbiosis.
9. Ask students what the descriptions on the right of the T-chart have in common (they are all found in food webs). Label the right heading of the T-chart In Food Webs.
Encourage skits to be short but expressive. Remind students that clarity (acting out the relationship clearly) is more important than being funny or dramatic.
After each guess, have the acting group explain why their skit represented that relationship. This reinforces comprehension and keeps the whole class engaged.
& 3.5

10. Have groups with cards 4 through 6 act out their skits, but instead of students guessing the description they are seeing, students should guess the name of the relationship that is being acted out.
11. After all of the student groups have completed the skits, let the class know that they will learn about each type of relationship in more detail. You may want to conclude this activity with a brief discussion of any other examples that the students may know regarding these types of relationships.
Have students illustrate their flashcards with simple sketches (ex: lion hunting zebra for predation). Visuals help with memory retention.
12. Have students create a set of four reference flash cards to define the competitive or mutually beneficial relationships organisms exhibit in nature.
○ Symbiosis: Both organisms benefit, or one organism benefits and the other is unaffected or harmed.
○ Predation: One organism benefits, and the other is hunted, killed, and fed upon.
○ Competition: Both organisms need the same resources, but there is not enough for both, so each one is fighting for access to the resources.
○ Cooperation: Two species work together for the benefit of all species in an ecosystem.
13. Conclude the activity with a discussion:
○ Do ecosystems have more or less of any one kind of positive, negative, or neutral interaction? Answers will vary. Be sure and point out that the interaction can be positive for one, such as a predator, and negative for another, such as the prey. Any one ecosystem can have many types of interactions.
○ Would you expect to see a balance of interactions in an ecosystem? The population numbers may vary, but overall, the ecosystem should be sustainable (able to maintain itself).
How do the interactions between plants, animals, and tiny organisms in a forest ecosystem ensure the sharing of energy and resources?
1. Based on your observations, how do different types of relationships (such as symbiosis, predation, competition, and cooperation) contribute to the balance of energy and resources in a forest ecosystem?
2. How might the removal or addition of one species affect the interactions and balance within a forest ecosystem?
3. Can you think of examples where human activity has disrupted these interactions in a forest ecosystem, and what were the consequences?
Notes
L.6.3.4 & 3.5

Estimated 30 min - 45 min
In this activity, students find their "date" as they match the two organisms while investigating interactions in a competitive or mutually beneficial relationship (predation, competition, cooperation, or symbiotic relationships).
Materials
Printed
● 1 Student Journal (per student, group, or class)
● 1 Invitation Cards (per class)
Reusable
● 1 scissors (per class)
● 1 pencil (per student)
Consumable
● Student Journals can be printed individually for student use or as a reusable class set, or they can be assigned online.
● Print the Invitation Cards. Cut out the cards and laminate for durability. Distribute one card per student, making sure to include matching sets.
Analyzing and Interpreting Data and Obtaining, Evaluating, and Communicating Information
During this activity, students will analyze and interpret data to provide evidence for the phenomenon of how plants, animals, and tiny organisms work together to share energy and resources in a forest. By matching organisms and investigating their interactions, students will construct and interpret graphical displays of data to identify relationships such as predation, competition, cooperation, or symbiosis. They will distinguish between causal and correlational relationships and apply statistical concepts to characterize data, considering limitations and seeking to improve data precision. Additionally, students will obtain, evaluate, and communicate information about these interactions, integrating qualitative and quantitative data to clarify claims and findings.
● 1 lab journal (per student) Notes
Cause and effect: Mechanism and explanation, and Energy and matter: Flows, cycles, and conservation, and Stability and change
During this activity, students will explore cause and effect relationships by classifying interactions between organisms in a forest ecosystem as competitive, cooperative, predatory, or symbiotic. They will predict how these interactions influence the transfer of energy and matter, and how changes in one part of the system can affect the stability and dynamics of the ecosystem as a whole.
1. Begin the activity with a discussion about relationships between organisms:
○ What are relationships or interactions that occur between organisms? Competition, cooperation, predation, or symbiosis
○ What are some examples of such relationships? Answers will vary. Example answers: cattle and cattle egret (symbiosis), cat and mouse (predation), cattle and sheep (competition), herds of animals like elephants or lions roaming in packs to work together for common benefits (cooperation)
2. Tell the students their challenge is to pair up as organisms with a relationship of competition, cooperation, predation, or symbiosis.
3. Have students work as individuals until they pair with their "date" to complete this task. Allow students to discuss concepts with their group, if appropriate.
4. When students are finished, have a discussion about the results:
○ In the spider and fly interaction, which is the predator, and which is the prey? The spider is the predator, and the fly is the prey.
○ Sometimes in symbiotic relationships both organisms are helped. Which interaction had this type of relationship? Shark and remora fish, acacia tree and ants, fungi and algae
○ Sometimes in symbiotic relationships one organism is helped, but the other is neither harmed nor helped. Which interaction had this type of relationship? Orchid and tree, northern hogsucker fish and minnow, hydra and mussel
○ What resource are the oak and pine trees fighting for? Light
5. Summarize each type of organism's interactions within an ecosystem:
○ Predation: One organism benefits, and the other is hunted, killed, and fed upon.
○ Competition: Both organisms need the same resources, but there is not enough for both; therefore, each one is fighting for access to the resources.
○ Cooperation: Two species work together to attain resources or meet needs.
○ Symbiosis: Both organisms benefit, or one organism benefits while the other is unaffected or harmed.
Notes
Start with quick think-pair-share: “What relationships between organisms have you seen in your backyard, at the zoo, or on TV?”
Have students briefly present their pair to the class. This ensures exposure to multiple examples, even ones they didn’t think of.
& 3.5

Sentence Stems
For beginner and intermediate ELLs, have the materials translated to their native languages as a reference for them to use during the activity. Prior to the students completing the activity, say the words out loud and have the students repeat them. This scope can be difficult and very confusing for ELPs because of the vocabulary words. When teaching the words, concentrate on using them repeatedly and with examples. This will also facilitate their ability to use academic vocabulary when communicating with other students.
To check their understanding and for future reference, the students can draw pictures and complete the following sentence stems in their journals after the group activity. The students may also read the sentences out loud with a partner or in their groups.
Beginner/Intermediate
Give them a word bank as a reference for labeling their picture.
● I drew a _______________.
● Animals and plants need _______________ to live.
Advanced/Advanced High
Have the students label their picture.
● The importance/priority of _______________ is ____________. I know because ___________________________.
● Something I considered in my decision was ___________________________ because ______________________________.
Phenomenon Connection
How do the interactions between different organisms in a forest ecosystem ensure the sharing of energy and resources?
1. In what ways do symbiotic relationships between plants and animals contribute to the balance of energy and resources in a forest ecosystem?
2. How might competition for resources among organisms affect the overall health and sustainability of a forest ecosystem?
3. Can you think of examples where cooperation between species leads to a more efficient use of resources in a forest? How does this cooperation impact the ecosystem as a whole?
Notes
& 3.5

Estimated 1 hr - 2 hrs
Activity Preparation
While working in groups, students develop and use food chains, webs, and pyramids to analyze how energy is transferred through an ecosystem from producers (autotrophs) to consumers (heterotrophs, including humans) to decomposers.
Materials
Printed
● 1 Student Journal (per student)
● 1 set of Organism Cards (per class)
Reusable
● 1 pair of scissors (per class)
Consumable
● 1 ball of yarn (per class)
SEP Connection
● Print a set of Organism Cards and laminate, if desired. Cut out individual cards.
● Print a class set of Student Journal.
Analyzing and Interpreting Data and Obtaining, Evaluating, and Communicating Information
During this activity, students will analyze and interpret data by constructing and examining food chains, webs, and pyramids to understand how energy is transferred through an ecosystem. They will use graphical displays to identify relationships and distinguish between causal and correlational data, providing evidence for the phenomenon of how plants, animals, and tiny organisms work together to share energy and resources in a forest. Students will also obtain, evaluate, and communicate information by integrating qualitative and quantitative data from their models to clarify claims and findings about the natural world.
Connections
Cause and effect: Mechanism and explanation, and Energy and matter: Flows, cycles, and conservation, and Stability and change
During this activity, students will explore cause and effect relationships by analyzing how energy is transferred through an ecosystem from producers to consumers to decomposers. They will classify these relationships as causal or correlational, recognizing that correlation does not necessarily imply causation. By constructing food chains, webs, and pyramids, students will predict how plants, animals, and tiny organisms work together to share energy and resources in a forest. They will also understand that the transfer of energy drives the cycling of matter within the ecosystem, and that changes in one part of the system might cause large changes in another part, affecting the stability and dynamic equilibrium of the ecosystem.
Notes
1. Have students sit slightly spaced out in an open area.
2. Distribute an Organism Card to each student. (You may want to hand them out so that the producers are closest to the Sun, followed by the herbivores, omnivores, carnivores, and decomposers. This helps to keep the food web from getting too tangled.)
3. Have students look at the organism on their card and decide where and how they would get their energy.
4. On the board or on chart paper, write Sun. Record each pass of the yarn ball on the board so students can visually see the food web being built. Be sure to use arrows to show the flow of energy.
5. Ask students to raise their hand if they would get their energy directly from the Sun.
6. Have the student with the Sun card hold one end of the yarn and toss the ball to a student who has a hand raised.
○ What name do we have for an organism that gets its energy directly from the Sun? A producer or autotroph
7. Ask students to raise their hand if they would get their energy by eating plants.
8. Have the student holding the ball of yarn keep hold of the string and pass the ball to a student who has a hand raised.
○ What type of consumer eats only plants? Herbivores
○ What type of consumer can eat plants and animals? Omnivores
9. Ask students to raise their hand if they would get their energy by eating another animal.
10. Have the student holding the ball of yarn keep hold of the string and pass the ball of yarn to a student who has a hand raised.
○ What name do we have for a consumer that eats only other animals? Carnivore
○ What about the earthworms and the mushrooms? Where do they get their energy? Earthworms and mushrooms are decomposers. They get their energy from dead plants and animals.
11. Have the student with the ball of yarn keep hold of the string and pass the ball to a decomposer.
12. Remind students that any organism can perish and be consumed by a decomposer.
13. Once the ball of yarn reaches a decomposer, cut the yarn and repeat the process again beginning with the Sun. (It is okay for students to end up holding more than one string. Just make sure students hold the strings until the end of the activity.)
14. As the activity continues, encourage students to make reasonable connections in the food web. Even though a hawk is a carnivore, it would not eat a bear.
15. Continue the activity until every organism has been included in the food web.
FACILITATION TIP
Before handing out cards, remind students: “This card represents a real organism. Your job is to think like that organism—where would you get your energy?”
FACILITATION TIP
For each toss of yarn, ask the receiver to explain their role: “Why would this organism eat plants instead of animals?”

After building the web, point out that only ~10% of energy moves up each trophic level, while ~90% is lost as heat or waste. Tie this to why there are fewer top predators.
16. Have students record their class food web on their Student Journal. Create various models to illustrate food webs including a web with numerous arrows representing each of the organisms within the interconnected food chains and also an energy pyramid.
17. Explain how energy is transferred from each level and how the percent of energy that is transferred decreases. Producers are at the base of the pyramid since they obtain their energy directly from the Sun, and this is the most abundant amount of energy.
18. After creating food web models, have students answer the remaining questions in the Reflection and Conclusion section of the Student Journal.
This activity can cause some students to become overly excited due to the new environment or the action of throwing yarn. Encourage students to think before they act and consider the results of their actions. Provide a location for students to remove themselves and pause if they become overexcited during the activity. Read more strategies for overstimulation in the Intervention Toolbox.
Food Chain Gang
After the students have completed the Explore, group students into groups of three. Give each group a large piece of butcher paper.
● Instructions: Illustrate a food chain that includes an energy source, two producers, three herbivores, two carnivores, and one decomposer. Arrows must be included in the drawing to represent the energy transfer from organism to organism.
● Challenge: After creating a food chain, come up with one way that humans can alter that food chain. Explain how it would change that food chain. Students can be given the opportunity to present their food chain to the class.
In what ways do the roles of producers, consumers, and decomposers ensure the continuous flow of energy and resources in a forest ecosystem?
1. How does the energy transfer from the Sun to producers and then to various consumers demonstrate the interconnectedness of organisms in a forest ecosystem?
2. What role do decomposers play in recycling energy and resources, and how does this affect the overall health of the forest ecosystem?
3. How might changes in one part of the food web, such as a decrease in producers or an increase in carnivores, impact the energy flow and resource availability in the forest ecosystem?

STEMscopedia
Reference materials that includes parent connections, career connections, technology, and science news.
Linking Literacy
Strategies to help students comprehend difficult informational text.
Picture Vocabulary
A slide presentation of important vocabulary terms along with a picture and definition.
Content Connections Video
A video-based activity where students watch a video clip that relates to the scope’s content and answer questions.
Career Connections - Zoologist
STEM careers come to life with these leveled career exploration videos and student guides designed to take the learning further.
Math Connections
A practice that uses grade-level appropriate math activities to address the concept.
Reading Science - Kansas Prairie Food Chain
A reading passage about the concept, which includes five to eight comprehension questions.
Notes
Claim-Evidence-Reasoning
An assessment in which students write a scientific explanation to show their understanding of the concept in a way that uses evidence.
Multiple Choice Assessment
A standards-based assessment designed to gauge students’ understanding of the science concept using their selections of the best possible answers from a list of choices
Open-Ended Response Assessment
A short-answer and essay assessment to evaluate student mastery of the concept.
Guided Practice
A guide that shows the teacher how to administer a smallgroup lesson to students who need intervention on the topic.
Independent Practice
A fill in the blank sheet that helps students master the vocabulary of this scope.
Extensions
A set of ideas and activities that can help further elaborate on the concept.
Use this template to decide how to assess your students for concept mastery. Depending on the format of the assessment, you can identify prompts and intended responses that would measure student mastery of the expectation. See the beginning of this scope to identify standards and grade-level expectations.
Some interactions benefit both individuals involved, whereas others benefit one individual to the detriment of another.
Competition occurs when ecological niches overlap and multiple organisms seek the same biotic or abiotic resources.
Predation (predator consumes prey), parasitism (parasite consumes host), and herbivory (herbivore eats, but does not destroy, the plant) are interspecific interactions in which one organism consumes another to obtain resources.
Symbiotic relationships can be mutualistic (both organisms benefit), parasitic (only one organism benefits), or commensal (one organism benefits and the other is unaffected).
Food chains diagram the transfer of energy as it flows from the Sun to producers (autotrophs) to consumers (heterotrophs).
Food webs diagram the complex relationships of energy flow in an ecosystem containing a variety of producers, consumers, and decomposers.
Energy pyramids diagram the decreasing amount of available energy as it flows from one trophic level to the next, moving from producers at the bottom of the food pyramid to tertiary consumers at the top of the food pyramid.
Student Expectations
The student is expected to demonstrate an understanding of classification tools and models such as dichotomous keys to classify representative organisms based on the characteristics of the kingdoms: Archaebacteria, Eubacteria, Protists, Fungi, Plants, and Animals.
Student Wondering of Phenomenon
How can we use a special “yes or no” question game to figure out which kingdom a mysterious living creature belongs to?
Key Concepts
• The taxonomic groups of organisms within each distinct domain share similar characteristics and can be subdivided into kingdoms. Taxonomic classification is a process of science that organizes living organisms by their structure, function, and relationships. Classification of organisms allows the identification of shared characteristics, which reveals how organisms interact with the components of their ecosystem.
• Fundamental differences in the cell, the basic unit of life, allow for the broadest classification of all living organisms into three domains: Bacteria, Archaea, and Eukarya.
• Domains are divided into six kingdoms by identifying internal structures and functions rather than outward characteristics such as color, appendage number, or size of an organism. The domain Bacteria includes the kingdom Bacteria; the domain Archaea includes the kingdom Archaea. The domain Eukarya is subdivided into four kingdoms: Protista, Plantae, Fungi, and Animalia.
This unit develops students’ understanding of how and why organisms are classified across Archaebacteria, Eubacteria, Protists, Fungi, Plants, and Animals. Students analyze shared and distinguishing characteristics (cell type, organization, nutrition, reproduction, genetics), practice using classification tools and models (e.g., dichotomous keys), and apply evidence to sort and justify placements. Through comparative analysis and research, they examine how classification systems have evolved with technological advances (microscopy, genetic sequencing), communicate findings, and synthesize patterns to explain current frameworks and anticipate future refinements.
The terms below and their definitions can be found in Picture Vocabulary and are embedded in context throughout the scope.
Archaebacteria
Single-celled prokaryotic organisms in the domain Archaea that typically live in extreme environments
Dichotomous Key
Tool used to sort organisms by paired similarities or differences based on a series of statements
Eubacteria
Prokaryotic cells , lacking nuclei, commonly referred to as “true bacteria”
Kingdom Animalia
Kingdom of heterotrophic eukaryotes that includes all animals
Kingdom Archaea
Kingdom of prokaryotic, single-celled organisms that live in extreme environments
Kingdom Bacteria
Kingdom of prokaryotic, single-celled organisms that lack a membrane-enclosed nucleus and can be classified by shape
Kingdom Fungi
Kingdom of heterotrophic eukaryotes that reproduce through asexual spores and have cell walls
Kingdom Plantae
Kingdom of autotrophic eukaryotes that includes all plants
Kingdom Protista
Kingdom of single-celled and simple multiplecelled eukaryotic organisms
Kingdoms
The second-highest level in the taxonomic hierarchy; contains six groups: Archaea, Bacteria, Protista, Fungi, Plantae, and Animalia
Taxonomy
The branch of science that formally names and classifies organisms by their structure, function, and relationships Scope Overview Scope Vocabulary
Notes
Students investigate how organisms are broadly classified and why characteristic differences place them in different groups.
• Use a slideshow to introduce and discuss the three domains and six kingdoms while reinforcing key vocabulary.
• Compare a sunflower and mushrooms to examine shared traits (eukaryotic, multicellular) and differences in nutrition (autotroph vs. heterotroph) and reproduction (seeds vs. spores).
• Apply classification criteria by discussing evidence and completing a short question set on the provided handout.
Activity - Methods of Classification
Students investigate how biological classification has evolved by comparing historical and modern systems.
• Work in groups to research an assigned scientist’s classification approach, how it differed from prior systems, and the technologies that enabled it.
• Create an informational page and participate in a gallery walk to share and learn from peers’ findings.
• Synthesize similarities and differences among systems, link advances like microscopy and genetic sequencing to major shifts (e.g., domains), and predict future changes.
Activity - Sorting by Kingdoms
Students investigate biological classification by sorting organisms into kingdoms and communicating evidence for shared traits.
• Cut and sort organism cards into kingdoms using criteria from a reading (cell type, unicellular/multicellular, function, genetics).
• Work in groups to research an assigned kingdom and create an image-supported slideshow highlighting shared structural and behavioral characteristics.
• Present findings, complete comparative tables during peer presentations, and write a scientific explanation based on class data.
Notes
L.6.4.1 & 4.2

L.6.4.1 & 4.2
Estimated 15 min - 30 min
In this demonstration, students examine how scientists classify organisms into three broad classification groupings called domains, as well as six kingdoms.
Materials
Printed
● 1 Classification of Organisms (per student)
● 1 Slideshow (per class)
SEP Connection
Analyzing and Interpreting Data
● Print one Classification of Organisms document for each student in your class.
● Prepare a projector to show the Slideshow to the entire class.
Obtaining, Evaluating, and Communicating Information
Engaging in Argument from Evidence
During this activity, students will analyze and interpret data to determine which kingdom a mysterious living creature belongs to by using a “yes or no” question game. They will construct, analyze, and interpret graphical displays of data to identify relationships and distinguish between causal and correlational relationships. Students will engage in argument from evidence by constructing oral and written arguments supported by empirical evidence to support or refute their classification decisions. They will also obtain, evaluate, and communicate information by integrating scientific information from multiple sources to clarify their claims and findings about the classification of organisms.
Notes
CCC Connection
Patterns and Structure and function
During this activity, students will recognize patterns in the classification of organisms by examining macroscopic characteristics and relating them to microscopic structures. They will use these patterns to identify cause and effect relationships in how organisms are grouped into domains and kingdoms. Additionally, students will model the structure and function of different organisms to understand how their characteristics determine their classification, thereby visualizing the relationships among parts and how they contribute to the organism’s function within its environment.
The activity is designed to begin using concept vocabulary by embedding terms within discussion through questioning strategy.
1. Project the Slideshow to the entire class and discuss the following as each slide is viewed.
○ Slide 1
Introduce students to the demonstration. Tell students that they will complete a short activity to get them thinking about classification. Mention the image on this slide, which illustrates the broadest groups of classification.
○ Slide 2
Say each domain name out loud to get students familiar with pronunciation: Bacteria, Eukarya, and Archaea.
○ Slide 3
Ask students to examine each image on the slide: the sunflower and the mushrooms. Do these two organisms belong in the same group? Prompt students to investigate the answer by thinking about what characteristics they share. For example, the sunflower and mushrooms are both eukaryotes, which students should remember from previous activities. In addition, more than one cell composes each organism.
How does each organism get nutrients (food source)? Lead the discussion to help students recognize that the sunflower has green leaves, which contain chlorophyll. This means that the sunflower can photosynthesize and produce its own food, but it still needs some nutrients and water from the soil. Getting nutrients this way is known as autotrophy (the sunflower is autotrophic).
What about the mushrooms? Students should see that the mushrooms lack chlorophyll. This implies that the mushrooms cannot produce their own food and rely on getting nutrients from where they live. Getting nutrients this way is known as heterotrophy (the mushroom is heterotrophic).
Also discuss how the two organisms reproduce. The sunflower reproduces sexually with seeds, and mushrooms reproduce asexually with spores.
○ Conclude by explaining that although these two organisms share some key characteristics, they differ in how they get nutrients and how they reproduce. When classified, these characteristic differences determine that these two organisms are placed in different subcategories.
2. Prompt students to complete the questions on the Classification of Organisms document. Review student answers within small groups or as a class.
How can we use the characteristics of organisms to determine which kingdom they belong to, and what questions can help us classify a mysterious living creature?
1. What are the key characteristics that differentiate the three domains and six kingdoms of life, and how can these characteristics help us classify a mysterious organism?
2. How can we use a series of “yes or no” questions to narrow down the possible kingdom of a mysterious living creature based on its observable traits?
3. In what ways do the methods of obtaining nutrients and reproduction play a role in classifying organisms into different kingdoms, and how can these factors be used to identify a mysterious organism’s kingdom?
FACILITATION TIP
Use analogies for classification levels. Compare domains and kingdoms to “family trees” or “filing cabinets,” where organisms are grouped by shared traits, to make abstract categories more concrete.
FACILITATION TIP
After Slide 3, ask students to first write down their own reasoning about whether the sunflower and mushroom are in the same group, then discuss with a partner before sharing with the whole class.
FACILITATION TIP
Use a quick “thumbs up/down” or digital poll to check if students can correctly identify autotrophs vs. heterotrophs after the discussion.

Estimated 1 hr - 2 hrs
In this activity, students compare and contrast how scientists currently classify organisms into groups with historical methods of classification.
Materials
Printed
● 1 Student Journal (per student)
Reusable
● 1 computer with Internet access (per group)
● 1 markers, set (per group)
Consumable
● 1 paper, white, 8 x 10 inches (per group)
SEP Connection
Analyzing and Interpreting Data
Preparation
● Print one Student Journal for each student in your class.
● Divide the class into eight research groups.
● Assign each group one of the following scientists: Aristotle, Carl Linnaeus, Ernst Haeckel, Edouard Chatton, Herbert Copeland, Robert Whittaker, Carl Woese, or Thomas Cavalier-Smith. They will be researching how each scientist contributed to the classification of organisms.
Obtaining, Evaluating, and Communicating Information
Engaging in Argument from Evidence
During this activity, students will analyze and interpret data to provide evidence for the phenomenon of classifying a mysterious living creature into a kingdom using a “yes or no” question game. By comparing historical and current classification methods, students will engage in argument from evidence to support or refute classification systems, integrating scientific information from various sources to clarify claims and findings. Through this process, they will apply concepts of statistics and probability to analyze data, consider limitations, and communicate their findings effectively.
Notes
CCC Connection
Patterns
Structure and function
During this activity, students will identify and analyze patterns in the historical and modern classification systems of organisms, recognizing how macroscopic patterns in classification relate to microscopic and genetic-level structures. By comparing these systems, students will understand the structure and function of classification methods and how technological advancements have shaped and refined these systems over time.
1. Lead the class in a Pre-Activity Discussion:
○ How do scientists classify organisms? Accept all ideas.
○ Has the method of classification of organisms remained the same or has it changed over time? Explain your ideas. Accept all ideas.
2. Tell each group which scientist they are to research.
3. Explain that each group should research the answer to the following questions:
○ Who is the scientist, and when did he/she live?
○ What is the scientist's method of classification of organisms?
○ How is this classification system different from the previous method or methods?
○ What (if any) technology allowed for the development of this new method of classification?
4. Ask students to create an informational page that includes their researched data that will be shared during a gallery walk.
5. Provide time for students to create their product.
6. Complete a gallery walk for students to share their research.
7. Lead the class in a Post-Activity Discussion:
○ How are the various methods of classification similar? All are methods of categorizing organisms based on what can be observed by humans.
○ How are the various methods of classification different? Early classification methods were based on physical attributes that are easily observed and had few divisions, such as plant or animal. As technology advanced, organisms were able to be observed at the microscopic level. This allowed scientists to observe differences between organisms at the cellular level. This led to new divisions or categories of organisms such as fungi, protists, and bacteria. With the advent of genetic sequencing, the heredity of an organism can be established. This has led to the addition of new categories, such as the three domains of Archaea, Bacteria, and Eukarya and the removal of others, such as the kingdom Monera.
○ What technological advances have led to changes in how organisms are classified today? Microscopes have allowed scientists to observe organisms at the cellular level, which has led to the identification of prokaryotes and eukaryotes as part of classification. Genetic sequencing and the ability to study organisms at the genetic level has led to the development of the three-domain classification system.
○ What do you predict will happen concerning the method of classifying organisms? History has shown that as scientists make new discoveries about organisms, the classification system changes to accommodate the new information. One example of this is the creation of the threedomain system after Woese established genetic differences and similarities between Archaea, Bacteria, and Eukarya. Future advances in technology and new discoveries of organisms will dictate any changes that may be needed in the classification system.
Ask follow-up questions such as, “Why do you think classification methods might change over time?” to stimulate critical thinking.
Support students who struggle with research by providing simplified resources or guiding questions.

Round-Robin Discussion
After the students have explored ways of classifying organisms, have them reflect on the lesson via a Round-Robin Discussion.
The steps of the Round-Robin strategy are as follows:
● Provide the students with the following sentence stems to assist them with the discussion. Have them write and answer the stems before beginning the activity.
○ We want to classify animals and plants because
○ If I had to categorize organisms, I would classify by _____________________
○ Animals, like dogs and wolves, are categorized today using
● Assign a rotation sequence to the groups using a method of your choice, such as alphabetically, numerically, etc.
How can we use a special “yes or no” question game to figure out which kingdom a mysterious living creature belongs to, and how does this relate to the historical and modern methods of classifying organisms?
1. How did the classification methods of scientists like Aristotle and Linnaeus differ from those of modern scientists like Woese, and what role did technology play in these differences?
2. In what ways do you think the classification system might change in the future with further technological advancements?
3. How can understanding the historical context of classification methods help us improve our current system of identifying and categorizing organisms?
Notes
& 4.2

Estimated 2 hrs - 3 hrs
In this activity, students use organism cards to classify organisms into kingdoms to explore the diversity of organisms within each kingdom. Students also design a slideshow presentation that includes pictures to support claims that organisms have shared structural and behavioral characteristics.
Materials
Printed
● 1 Student Journal (per student)
● 1 In What Kingdom Do I Belong Cards (per student)
● 1 Classifying by Kingdoms (per student)
Reusable
● 1 scissors (per student)
● 1 glue stick (per student)
● 1 computer with Internet access (per group)
● 1 digital camera (per group)
SEP Connection
Analyzing and Interpreting Data
● Print one Student Journal for each student in your class.
● Print one In What Kingdom Do I Belong Cards for each student in your class.
● Print one Classifying by Kingdoms for each student in your class.
Obtaining, Evaluating, and Communicating Information
Engaging in Argument from Evidence
During this activity, students will analyze and interpret data by using organism cards to classify organisms into kingdoms, which will help them explore the diversity of organisms and identify shared structural and behavioral characteristics. This process involves constructing graphical displays of data to identify relationships and using these findings to support claims about the classification of organisms. By engaging in this activity, students will also develop skills in obtaining, evaluating, and communicating information through research and slideshow presentations, and they will engage in argument from evidence by constructing and presenting arguments supported by empirical evidence and scientific reasoning to explain the classification of organisms into kingdoms.
Notes
CCC Connection
Patterns and Structure and function
During this activity, students will identify and analyze patterns in the structural and behavioral characteristics of organisms to classify them into kingdoms. By recognizing these patterns, students will understand the relationship between macroscopic features and microscopic structures, and how these patterns inform the classification system. Additionally, students will explore the structure and function of organisms by modeling and visualizing how their characteristics depend on their composition and relationships among their parts, using this understanding to support their classification claims.
1. Lead the class in a Pre-Activity Discussion:
○ What is used to classify organisms? Organisms can be classified into groups based on their cellular structure—whether they have defined nuclei or not (eukaryotes versus prokaryotes), or whether their entire body is made up of one cell (unicellular) or many cells (multicellular). Scientists can also look at how organisms function to help classify them. They can also be grouped based on how similar their genetic makeup is.
○ Is the classification system of domains and kingdoms the only system that scientists have ever used to classify organisms? Explain your answer. No, the first classification system was divided only into the kingdom Plantae and the kingdom Animalia. Then, physical characteristics of organisms were examined, and the system was changed to five kingdoms: Monera, Protista, Fungi, Plantae, and Animalia. Now, due to the ability to examine an organism's genetic makeup, the system of three domains and six kingdoms has been adopted.
2. Have students cut out the In What Kingdom Do I Belong? Cards.
3. Ask students to read Classifying by Kingdoms, or read as a class.
4. Tell students to use the information to choose the correct kingdom for each organism and paste each organism card in the appropriate kingdom.
1. Assign each student group a kingdom.
2. Provide time for students to complete their research and slideshow following the directions on their Student Journal.
3. When slideshows are complete, have students share their slideshow with the class.
4. Remind students to fill in the tables as students present.
5. Finally, have students use collected data to write a scientific explanation to support the claim that organisms have shared structural and behavioral characteristics.
6. Review as desired.
Notes
FACILITATION TIP
Help students see that organisms are classified not just by what they look like, but also by how they live, grow, and reproduce.
FACILITATION TIP
Give a simple slideshow or table template to reduce cognitive load and keep students focused on content rather than formatting.
& 4.2

For this activity, students may initially work better with a peer partner as opposed to individually. Scaffolding this activity may work well. For example, first the student could work with a peer to arrange the cards, and then the student could independently arrange the cards one-on-one with a teacher. Ask students guiding questions to help them in the sorting process. Learn more strategies to help students with sequencing in the Interventions Toolbox.
After the students have a chance to explore the investigation about the classification of organisms, play a quick game of Wall to Wall.
● Place a sheet of chart paper on each of the four walls of your room, and write down the following numbers and terms:
1. Unicellular vs. Multicellular
2. Autotrophic vs. Heterotrophic
3. Prokaryote vs. Eukaryote
4. Domain vs. Kingdom (Optional: For beginning ELPs, to help with vocabulary understanding, you can place a picture under each word as a reference.)
● Have your students form groups by counting off from one to four.
● Direct students to go to the chart paper with their corresponding number.
● Tell students they have one minute to write down anything they remember about that term.
● Then, have them rotate to the next wall, moving in numerical order (one through four).
● Instruct students to place a check mark next to an idea they agree with that somebody else has already written down.
● After moving through all of the groups, have students go back to their original spots. While there, have them share one to two key points they read from the chart paper to the class, beginning with group 4.
How can we use a special “yes or no” question game to figure out which kingdom a mysterious living creature belongs to, and what characteristics help us make these determinations?
1. Based on your comparison with other classmates, what characteristics did you find most useful in determining the kingdom of an organism?
2. If you were to encounter a new organism, what “yes or no” questions would you ask to classify it into the correct kingdom?
3. How do structural and behavioral characteristics help in distinguishing between organisms of different kingdoms?
STEMscopedia
Reference materials that includes parent connections, career connections, technology, and science news.
Linking Literacy
Strategies to help students comprehend difficult informational text.
Picture Vocabulary
A slide presentation of important vocabulary terms along with a picture and definition.
Content Connections Video
A video-based activity where students watch a video clip that relates to the scope’s content and answer questions.
Career Connections - Arborist
STEM careers come to life with these leveled career exploration videos and student guides designed to take the learning further.
Math Connections
A practice that uses grade-level appropriate math activities to address the concept.
Reading Science - To Group or Not to Group
A reading passage about the concept, which includes five to eight comprehension questions.
Notes
Claim-Evidence-Reasoning
An assessment in which students write a scientific explanation to show their understanding of the concept in a way that uses evidence.
Multiple Choice Assessment
A standards-based assessment designed to gauge students’ understanding of the science concept using their selections of the best possible answers from a list of choices
Open-Ended Response Assessment
A short-answer and essay assessment to evaluate student mastery of the concept.
Guided Practice
A guide that shows the teacher how to administer a smallgroup lesson to students who need intervention on the topic.
Independent Practice
A fill in the blank sheet that helps students master the vocabulary of this scope
Extensions
A set of ideas and activities that can help further elaborate on the concept.
Use this template to decide how to assess your students for concept mastery. Depending on the format of the assessment, you can identify prompts and intended responses that would measure student mastery of the expectation. See the beginning of this scope to identify standards and grade-level expectations.
The taxonomic groups of organisms within each distinct domain share similar characteristics and can be subdivided into kingdoms. Taxonomic classification is a process of science that organizes living organisms by their structure, function, and relationships. Classification of organisms allows the identification of shared characteristics, which reveals how organisms interact with the components of their ecosystem.
Fundamental differences in the cell, the basic unit of life, allow for the broadest classification of all living organisms into three domains: Bacteria, Archaea, and Eukarya.
Domains are divided into six kingdoms by identifying internal structures and functions rather than outward characteristics such as color, appendage number, or size of an organism. The domain Bacteria includes the kingdom Bacteria; the domain Archaea includes the kingdom Archaea. The domain Eukarya is subdivided into four kingdoms: Protista, Plantae, Fungi, and Animalia.
Does Student Mastery Look Like?

Student Expectations
The student is expected to demonstrate an understanding of how fungi, protists, and bacteria obtain energy, move, and respond to their environment.
Key Concepts
• Fungi are multicellular organisms that exist in many different types and sizes. Fungi, such as mushrooms and yeasts, are often confused with plants, but they are unable to make their own food from soil and water. Instead, they live off of other plants and animals.
• The kingdom Protista is composed of eukaryotic organisms that cannot be classified as animals, plants, or fungi; they have great structural diversity and diverse methods of getting food. Most protists are single-celled organisms that live in moist environments. Some protists, such as euglena, can photosynthesize and consume other organisms. Euglena move using flagella, paramecia use cilia, while amoebas have pseudopods.
• Bacteria are unicellular organisms that get their nutrients from their environment or surroundings. Most archaea live in extreme environments like hydrothermal vents, whereas bacteria live everywhere. The majority of bacteria in the world are not harmful.
Scope Overview
This unit immerses students in microorganisms to build understanding of how fungi, protists, and bacteria obtain energy, move, and respond to stimuli. Through observation, modeling, and controlled investigations (e.g., yeast growth), students gather and analyze evidence of life processes and behavior. Microscopic study of single-celled protists supports structure–function connections and comparisons of locomotion. Research and argumentation tasks synthesize how microorganisms can maintain or disrupt ecosystem balance, strengthening scientific reasoning, vocabulary, and collaborative sensemaking.
Scope Vocabulary
The terms below and their definitions can be found in Picture Vocabulary and are embedded in context throughout the scope.
Bacteria
One of the three taxonomic domains; a highly diverse group of single-celled, prokaryotic organisms
Domain Eukarya
One of the three taxonomic domains of organisms; has cells that contain a membrane enclosed nucleus
Euglena
A single-celled organism that moves by a flagellum and is known for its eyespot feature
Heterotrophic eukaryotes that reproduce through asexual spores, break down dead materials, and can spread disease
Multicellular
A category of organisms made up of more than one cell and of different types of cells
Paramecium
A ciliated, single-celled eukaryote that is common in aquatic ecosystems
Protists
Microorganisms from the kingdom Protista; must contain a nucleus
Unicellular
A category of organisms made up of one cell
Notes
Students explore microorganisms and connect their identities, functions, and classifications.
• Discuss what microorganisms are and how they help maintain ecosystem balance.
• Examine images and match each microorganism to its scientific name and use.
• Record the names of five microorganisms and identify their kingdoms, collaborating with peers as needed.
Activity - It’s a Fungi Thing
Students investigate how fungi obtain energy and respond to stimuli through observations and hands-on experiments with mold and yeast.
• Observe and compare foods produced with molds and a sealed sample of moldy bread to discuss fungi’s role.
• Perform a guided yeast investigation by adding sugar and water stepwise to note growth and gas production as evidence of life.
• Design and test a chosen variable (e.g., temperature, light, sugar, water) to examine yeast responses and share findings.
Scientific Investigation - Protists
Students explore and compare the structures and functions of euglena, amoeba, and paramecium through hands-on modeling and microscopic observation.
• Construct a booklet to organize key features and functions of three single-celled organisms.
• Observe prepared slides under microscopes and add observational notes to the booklet.
• Participate in a class discussion to compare organisms and use the booklet to answer reflection questions in their journals.
Activity - Microorganisms on Trial
Students analyze how microorganisms can both support and disrupt the health of organisms and ecosystems through evidence-based debate.
• Review characteristics and roles of bacteria and viruses, then research to build evidence.
• Prepare timed arguments for prosecution and defense in two mock trials; present openings and rebuttals.
• Rotate roles to also serve as jurors, take notes, and deliver justified verdicts based on presented arguments.
• Debrief to synthesize examples of beneficial and harmful impacts and the interdependence of microorganisms and ecosystems.
Notes
4.5

Estimated 15 min - 30 min
In this activity, students match images of specific microorganisms to their scientific names and their use or function. Students then identify which kingdom each microorganism belongs to.
Materials
Printed
● 1 Microorganisms (per student)
The Microorganisms document includes colored images of microorganisms to aid students in identifying each microorganism. If printing colored copies for each student is not allowed, black and white copies may be printed. However, at least one colored copy should be printed for student reference. The colored copy may be laminated for repeated use.
SEP Connection
Planning and Carrying Out Investigations
Analyzing and Interpreting Data
Obtaining, Evaluating, and Communicating Information
During this activity, students will plan and carry out investigations by matching images of microorganisms to their scientific names and functions, identifying independent and dependent variables such as the characteristics of microorganisms and their ecological roles. They will analyze and interpret data by constructing graphical displays to identify relationships between microorganisms and their environments, and evaluate the accuracy of their identifications. Additionally, students will obtain, evaluate, and communicate information by synthesizing data from the activity to describe patterns in the survival and thriving of microorganisms in unseen environments, thereby addressing the phenomenon of how tiny living things like fungi, protists, and bacteria survive and thrive in places where we can’t even see them.
Notes
CCC Connection
Cause and effect: Mechanism and explanation
Energy and matter: Flows, cycles, and conservation
Structure and function
During this activity, students will explore the cause and effect relationships that allow tiny living things like fungi, protists, and bacteria to survive and thrive in unseen environments. By matching microorganisms to their scientific names and functions, students will classify these relationships as causal or correlational, recognizing that correlation does not necessarily imply causation. Additionally, they will examine how the structure and function of these microorganisms contribute to their roles in maintaining ecosystem balance, and how energy and matter are conserved and cycled within these systems.
1. Discuss with students what microorganisms are and ways they help to maintain an ecosystem in balance.
2. For this activity, the students match the images of the microorganisms shown to their name and use in the Microorganisms document.
3. Instruct students to write the name of each of the five microorganisms in the blank that matches its correct image and use, and then to identify which kingdom the microorganism is from. It is all right if the students do not know this. They may collaborate with their classmates if they get stuck.
Phenomenon Connection
How do microorganisms, which are often invisible to the naked eye, manage to survive and thrive in diverse environments, and what roles do they play in maintaining ecological balance?
5. Based on your observations and comparisons, how do the characteristics of different microorganisms help them adapt to environments where they are not visible?
6. If you were to collect and cultivate a sample of these microorganisms, how might their growth and survival be affected by changes in their environment?
7. How do the functions of these microorganisms contribute to the ecosystems they inhabit, and what might happen if one of these microorganisms were removed from the ecosystem?
Notes
FACILITATION TIP
Relate to everyday life: Give examples of how microorganisms are important in daily life, such as:
Yeast in bread and brewing
Bacteria in yogurt and cheese
Microbes decomposing leaves in the soil

Estimated 1 hr - 2 hrs
Students conduct investigations involving various foods to help them gain knowledge about how fungi obtain energy and respond to stimuli.
Materials
Printed
● 1 Student Journal: It's a Fungi Thing (per group)
● 1 Student Guide: It's a Fungi Thing (per group)
Reusable
● 1 Permanent marker (per group)
Consumable
● 1 Piece of moldy bread (for each group)
● 4–5 Foods whose production involves the use of mold, such as blue cheese, Roquefort (cheese), Camembert (cheese), Brie (cheese), Gorgonzola (cheese), soy sauce, sake, tempeh, and miso (having a variety will enhance the discussion)
● 1 Resealable plastic zipper bag, pint-sized (per group)
● 1 Packet of dried yeast (per group)
● ¼ Cup warm water (warm, not hot) (per group)
● 1 Teaspoon sugar (per group)
● 1 Mystery sample in plastic zipper bag (per group)
● Create moldy bread 3–5 days prior to the activity. Each group will need a piece.
○ Use bread that is low in preservatives.
○ Moisten a piece of bread.
○ Seal bread in a resealable plastic zipper bag.
○ Place bag in a warm location away from direct sunlight for 3 to 5 days.
○ Seal the bag so that students will not open it. Mold can be toxic.
● Create a sampler of each of the food products for each group.
● If you choose to guide the students through this activity, prepare your models for the first three steps.
○ Bag 1 will contain just yeast.
○ Bag 2 will contain yeast and sugar.
○ Bag 3 will contain yeast, sugar, and water.
● Collect enough materials for each small group to perform the step-by-step procedure and an inquiry activity, plus the three you will make.
Planning and Carrying Out Investigations
Analyzing and Interpreting Data
Obtaining, Evaluating, and Communicating Information
During this activity, students will plan and carry out investigations to explore how fungi, such as yeast, obtain energy and respond to stimuli, thereby gaining insights into how tiny living things survive and thrive in unseen environments. They will identify independent and dependent variables, use appropriate tools for data collection, and analyze their findings to provide evidence for the phenomenon. Through this process, students will critically evaluate their methods, communicate their results, and refine their understanding of the conditions that support the growth and energy acquisition of fungi.
Cause and effect: Mechanism and explanation
Energy and matter: Flows, cycles, and conservation
Structure and function
During this activity, students will explore cause and effect relationships by investigating how fungi, such as yeast, obtain energy and respond to stimuli, thereby predicting how these microorganisms survive and thrive in environments not visible to the naked eye. They will classify relationships as causal or correlational, recognizing that correlation does not necessarily imply causation, and understand that multiple factors can influence the growth and energy acquisition of fungi. Through hands-on experimentation, students will also track the transfer of energy and matter within the system, observing how energy drives the cycling of matter and supports the survival of these microorganisms.
Procedure and Facilitation
1. Distribute a food sampler to each of the groups, and allow students to make observations. Allow tasting by students who would like to taste. Ask these students to share how the food tasted.
2. You may choose whether to label the foods with their actual names or simply "Sample 1," "Sample 2," etc.
3. Distribute a bag of moldy bread to each group. Stress the importance of not opening the bag.
4. Lead a concluding discussion that guides the students toward understanding that all of the samples and the bread are in some way affected by the fungus, mold.
5. Explain that the students will now use another fungus, yeast, to determine what fungi need to grow and obtain energy.
6. Hand out the Student Guide to each group.
7. Have groups gather materials and follow the steps listed to complete the guided investigation of yeast.
8. Move about the room helping students as they perform each of the steps.
9. Assist in writing descriptive observations as needed.
10. When student groups have completed the guided investigation, challenge students to consider a variable that they would like to test. Assist in brainstorming as needed. Variables could include a change in temperature, light, sugar, water, etc.
11. Allow students to follow their own procedure to investigate how the yeast will react to various stimuli.
Using neutral labels like “Sample 1, 2, 3” allows students to focus on observations rather than prior knowledge or assumptions.
Some students may struggle to describe what they see. Prompt them with questions:
“What color changes do you notice?”
“Is the yeast growing bigger or producing bubbles?”
“How quickly is it changing?”

12. When all groups are finished, ask one representative from each to share their variable and results.
13. Finish with a discussion:
○ What evidence did you observe that could be used to prove that yeast is a living organism? There was growth (change in size), and there was also release of gas (cells give off carbon dioxide as waste when they work).
○ Do you believe adding things one at a time made a difference in the results? Accept all reasonable answers.
Ask students to connect their observations with the concept of variables affecting growth.
○ Do you believe that the order in which the water and sugar were added to the yeast affected the result? Accept all reasonable answers.
Tasting Materials
When permitted, have plenty of toothpicks for individual tasting. You will need to ensure there is no one in class who is sensitive or allergic to any of the materials used.
Do Not Eat or Drink Materials
Students should be reminded not to eat or drink any materials, unless directed to do so.
Complete the Thought
Have students finish these sentences: The food for our yeast was ________________.
I know this because ___________________.
As students write their ideas about yeast and fungi, have them exchange their lab book with a partner and share their ideas.
How do fungi, like yeast and mold, obtain energy and respond to their environment in ways that allow them to thrive in places we can’t see?
1. Based on your observations, what conditions seemed to enhance the growth of yeast in your experiment, and how might these conditions relate to how fungi survive in hidden environments?
2. How did the presence of sugar and water affect the yeast’s activity, and what does this tell us about the resources fungi need to thrive?
3. Considering the moldy bread and the foods you sampled, what similarities and differences did you notice in how fungi interact with different types of food, and how might this relate to their ability to survive in various environments?

Estimated 15 min - 30 min
In this activity, students compare the structures and functions of three single-celled organisms (euglena, amoeba, and paramecium) by constructing a Single-Celled Organisms Booklet and observing samples under a microscope.
Materials
Printed
• 2 Student Guides (per group)
• 1 Single-Celled Organism Booklet (per student)
• 1 Student Journal (per student)
Reusable
• 1 Scissors, pair of (per student)
• 1 Stapler (per group)
• 1 Microscope (per group)
• 1 Prepared slide, amoeba (per group)
• 1 Prepared slide, paramecium (per group)
• 1 Prepared slide, euglena (per group)
Consumable
• 3 Staples (per student)
Planning and Carrying Out Investigations
Analyzing and Interpreting Data
• Print two Student Guides for each group and one Student Journal per student. Print one Single-Celled Organism Booklet per student. If possible, print the Teacher Printout: Single-Celled Organism Booklet two-sided to save paper.
• Construct a booklet of your own using the steps outlined in the Student Guide to show as an example if needed.
• Plan to distribute the Student Journal after students complete the booklet to avoid confusion.
Obtaining, Evaluating, and Communicating Information
During this activity, students will plan and carry out investigations by using microscopes to observe and compare the structures and functions of euglena, amoeba, and paramecium. They will collect and analyze data to provide evidence for how these tiny living things survive and thrive in environments that are not visible to the naked eye. Students will also evaluate and communicate their findings through the creation of a Single-Celled Organism Booklet, integrating qualitative and quantitative information to support their understanding of the phenomenon.
Cause and effect: Mechanism and explanation
Energy and matter: Flows, cycles, and conservation
Structure and function
During this activity, students will explore the structures and functions of single-celled organisms to understand how these tiny living things survive and thrive in environments invisible to the naked eye. By observing and comparing euglena, amoeba, and paramecium, students will classify relationships as causal or correlational, recognizing that correlation does not necessarily imply causation. They will use cause and effect relationships to predict how these organisms function in natural systems. Additionally, students will model the complex structures of these organisms to analyze how their functions depend on their shapes, composition, and relationships among their parts, thereby gaining insight into the energy and matter cycling within these microscopic systems. Activity
1. Have students use the Student Guide to create a Single-Celled Organism Booklet.
2. For Part II, have students use the microscopes to observe the prepared slides of each protist to record observations in the additional notes section of the booklet.
3. When students have made their booklets, lead a class discussion comparing the structures and functions of the different single-celled organisms.
4. Students use their booklets as a reference to help complete their Student Journal questions.
After the students have completed their booklets, have them play a quick game with you. Explain to them that you will state a characteristic of one of the one-celled organisms. They are then to "shout out" which organism(s) you are describing. For example, if you say "has an eyespot," students respond with "euglena." You can use different characteristics to review different organisms.
How do the unique structures and functions of single-celled organisms like euglena, amoeba, and paramecium enable them to survive and thrive in environments that are invisible to the naked eye?
1. How do the structures of euglena, amoeba, and paramecium differ, and how do these differences help them adapt to their environments?
2. In what ways do the functions of these single-celled organisms allow them to obtain nutrients and energy in environments where larger organisms might not survive?
3. How might the survival strategies of these microorganisms be similar to or different from those of fungi, protists, and bacteria in unseen environments?
Notes
Ask students to think about why an organism has a particular organelle or movement method (e.g., flagellum for swimming, cytoplasmic streaming for movement and food capture).

Estimated 15 min - 30 min
In this activity, the students explain how bacteria and viruses both maintain and disrupt the health of organisms and ecosystems. The students prepare and hold mock trials for bacteria and viruses to decide whether they are beneficial or detrimental to other organisms and ecosystems.
Materials
Printed
• 1 Student Journal (per student)
• 1 Student Guide (per student or per group)
Reusable
• 1 Marker, black, permanent (per group)
• 1 Stopwatch (per class)
Consumable
• 8 Sheets butcher paper, large, sticky (per group)
• Arrange for groups to have access to technology for research purposes.
• Provide groups with the butcher paper and markers.
Planning and Carrying Out Investigations
Analyzing and Interpreting Data
Obtaining, Evaluating, and Communicating Information
During this activity, students will plan and carry out investigations by preparing and conducting mock trials to evaluate the roles of bacteria and viruses in ecosystems. They will analyze and interpret data from their research to construct arguments and communicate their findings, distinguishing between beneficial and detrimental impacts. This process will help them understand how tiny living things like fungi, protists, and bacteria survive and thrive in places where we can’t even see them, by critically evaluating the evidence and communicating their conclusions effectively.
Cause and effect: Mechanism and explanation
Energy and matter: Flows, cycles, and conservation
Structure and function
During this activity, students will explore cause and effect relationships by examining how bacteria and viruses can both maintain and disrupt the health of organisms and ecosystems. They will classify these relationships as causal or correlational, recognizing that correlation does not necessarily imply causation. Through mock trials, students will predict phenomena in natural systems and understand that these phenomena may have multiple causes. Additionally, they will consider how the transfer of energy and matter within ecosystems is influenced by microorganisms, and how the structure and function of these tiny living things contribute to their survival and impact on larger systems.
1. Review the characteristics and uses of bacteria and viruses.
2. Explain that students are participating in two court cases to decide whether bacteria and/or viruses should be evicted from our planet.
3. For one case, students either defend or prosecute the bacteria or virus. For the other case, they serve on the jury.
4. Divide each of the two case groups into two teams. Ask one team from each group to prepare arguments that support the defendant. Ask the other team from each group to prepare arguments that support the plaintiff.
Defense for Bacteria
Prosecution for Bacteria
Defense for Viruses
Prosecution for Viruses
5. Prompt students to rely on their Student Journal notes to write statements.
6. Argument preparation can occur individually, with a partner, or as a team.
7. Provide a space for each team to meet and review their ideas. Monitor student groups as they prepare their statements and presentation. Give teams 10 or more minutes to complete their overall arguments.
8. Bring the class back together to proceed with the court cases. Start with the case involving bacteria. The students who did not prepare arguments for the case serve as jurors. Remind the jurors to take notes in their journals, as they will need them later to determine a verdict.
9. Review the court rules and time allotments for each part of case hearings.
Court Rules Time
Arguments for Plaintiff
Arguments for Defendant
Rebuttal Preparation
Rebuttal for Plaintiff
Rebuttal for Defendant
s
s
min
s
s
Jurors Confer and Reach a Verdict 5 min
10. Set up the room so that both sides are facing the jury.
11. After both rebuttals are presented, the jury adjourns for five minutes and returns with a justified verdict. Advise the jury they should make a judgment based on the arguments presented, not on their personal beliefs.
Utilize a visual timer to help groups manage their time.
4.5

1. What are some of the beneficial roles that microorganisms play in maintaining the health of other organisms and ecosystems? Cite one specific example for each type of role. Answers will vary depending on what organisms they choose to cite.
2. In what ways can microorganisms disrupt the health of other organisms and ecosystems? Cite one specific example of each type of disruption. Answers will vary depending on what organisms they choose to cite.
3. Can ecosystems exist without microorganisms? Justify your answer. Answers will vary. Answers should reflect that microorganisms are an integral part of every ecosystem, and they impact every organism in every kingdom.
4. How do microorganisms depend on other organisms and on ecosystems? Answers should reflect that microorganisms depend on other organisms and ecosystems just as strongly as other organisms and ecosystems depend on them.
Some students may become upset by the debate style of this activity. They can either not participate in the activity and watch their other classmates, or participate in a small group. Provide choices for the student to decide what will provide the least amount of stress. Read more strategies for students who are easily stressed or upset in the Interventions Toolbox.
Question, Stem, Share
Question: Students are asked questions at various levels based on their current knowledge or abilities. These questions can be presented on a projected screen, and students can attempt to answer a question as they see fit, or you can choose the level they will answer.
Stem: If students are unsure how to answer or are struggling with choosing the correct wording, you can provide them with a stem to help them formulate a response.
Share: The tallest student begins. Once that student has answered, he or she will choose the next student to answer a different level question.
Possible questions and sentence stems include the following:
• Level 1 Knowledge
⸰ Question: How would you describe a microorganism?
⸰ Stem: I would describe a microorganism as __________________.
• Level 2 Comprehension
⸰ Question: What can you say about the relationship that microorganisms have with plants?
⸰ Stem: I can say _____ about the relationship that microorganisms have with plants.
• Level 3 Application
⸰ Question: What examples can you find to describe the effect microorganisms have on an ecosystem?
⸰ Stem: Examples that describe the effect that microorganisms have on an ecosystem are _______________.
• Level 4 Analysis
⸰ Question: Can you make a distinction between pathogens and microorganisms that are involved in food production?
⸰ Stem: A distinction between pathogens and microorganisms that are involved in food production is ____________________.
• Level 5 Synthesis
⸰ Question: What would be the outcome of a situation in which a new pathogen is introduced to an ecosystem?
⸰ Stem: A situation in which a new pathogen is introduced to an ecosystem would result in ___________________.
• Level 6 Evaluation
⸰ Question: What is your opinion of microorganisms?
Phenomenon Connection
How do microorganisms like bacteria and viruses impact the health of organisms and ecosystems, and what roles do they play in maintaining or disrupting these systems?
1. What are some specific examples of how bacteria and viruses can be beneficial to ecosystems, and how do these benefits compare to their potential harms?
2. In what ways do microorganisms interact with other living organisms to ensure their survival, and how might these interactions be invisible to us?
3. Considering the essential roles microorganisms play, what might happen to an ecosystem if all microorganisms were suddenly removed?
⸰ Stem: My opinion of microorganisms is ___________________. Notes

STEMscopedia
Reference materials that includes parent connections, career connections, technology, and science news.
Linking Literacy
Strategies to help students comprehend difficult informational text.
Picture Vocabulary
A slide presentation of important vocabulary terms along with a picture and definition.
Content Connections Video
A video-based activity where students watch a video clip that relates to the scope’s content and answer questions.
Math Connections
A practice that uses grade-level appropriate math activities to address the concept.
Reading Science - Protists—What the Heck Are They?
A reading passage about the concept, which includes five to eight comprehension questions.
Notes
Claim-Evidence-Reasoning
An assessment in which students write a scientific explanation to show their understanding of the concept in a way that uses evidence.
Multiple Choice Assessment
A standards-based assessment designed to gauge students’ understanding of the science concept using their selections of the best possible answers from a list of choices
Open-Ended Response Assessment
A short-answer and essay assessment to evaluate student mastery of the concept.
Guided Practice
A guide that shows the teacher how to administer a smallgroup lesson to students who need intervention on the topic.
Independent Practice
A fill in the blank sheet that helps students master the vocabulary of this scope.
Extensions
A set of ideas and activities that can help further elaborate on the concept.
Use this template to decide how to assess your students for concept mastery. Depending on the format of the assessment, you can identify prompts and intended responses that would measure student mastery of the expectation. See the beginning of this scope to identify standards and grade-level expectations.
Student Learning Objectives
Fungi are multicellular organisms that exist in many different types and sizes. Fungi, such as mushrooms and yeasts, are often confused with plants, but they are unable to make their own food from soil and water. Instead, they live off of other plants and animals.
The kingdom Protista is composed of eukaryotic organisms that cannot be classified as animals, plants, or fungi; they have great structural diversity and diverse methods of getting food. Most protists are single-celled organisms that live in moist environments. Some protists, such as euglena, can photosynthesize and consume other organisms. Euglena move using flagella, paramecia use cilia, while amoebas have pseudopods.
Bacteria are unicellular organisms that get their nutrients from their environment or surroundings. Most archaea live in extreme environments like hydrothermal vents, whereas bacteria live everywhere. The majority of bacteria in the world are not harmful.

Student Expectations
The student is expected to demonstrate an understanding of Newton’s laws of motion using real-world models and examples.
Scope Overview
This unit develops students’ understanding of Newton’s laws through hands-on investigations, data analysis, and engineering design. Learners explore how friction and unbalanced forces affect motion, collect and graph time–distance data to distinguish speed, velocity, and acceleration, and connect potential, kinetic, and thermal energy through observations of heat transfer. They design, build, test, and iterate protective devices under constraints, using evidence from trials to explain outcomes, compare solutions, and communicate findings—linking real-world models to the laws that govern motion and energy transformations.
• According to Newton’s first law of motion, an object will stay in motion or stay at rest until an unbalanced force acts upon it.
• Newton’s second law states that when a force acts on an object, it will cause the object to accelerate. The larger the mass of the object, the greater the force will need to be to cause it to accelerate. Acceleration is a change in motion (direction, speed, or both). Acceleration of an object will always be in the same direction as the sum of forces applied to the object.
• Newton’s third law states that when one object exerts a force on a second object, the second object exerts an equal force in the opposite direction on the first object.
Scope Vocabulary
The terms below and their definitions can be found in Picture Vocabulary and are embedded in context throughout the scope.
Balanced Forces
Forces on an object that do not change the motion of the object
Collide
To strike or hit something with any amount of force
Force
A push or pull that can change the motion of an object
Friction
A force that resists the motion of two surfaces sliding across one another
Inertia
The tendency of a physical object to remain still or continue moving unless force is applied
Motion
The change in an object’s position with respect to time and in comparison with the position of other objects used as reference points
Newton’s Law of Action-Reaction
Newton’s law stating that for every action force there is an equal and opposite reaction force; often referred to as Newton’s third law of motion
Newton’s Law of Force and Acceleration
Newton’s law stating that acceleration of an object depends on the object’s mass and the magnitude of the force acting upon it (F = ma); often referred to as Newton’s second law of motion
Newton’s Law of Inertia
Newton’s law stating that a n object at rest stays at rest or an object in motion stays in motion until unbalanced forces act upon it; often referred to as Newton’s first law of motion
Reaction
Resistance or force of equal magnitude acting in the opposite direction to an action force
Unbalanced Forces
Forces on an object that cause change in the motion of the object
Students explore how reducing friction affects speed and motion.
• Make predictions about which volunteer will reach the finish line first, then observe a slide race comparing normal shoes to shoes wrapped in smooth towels.
• Analyze obaservations to explain how decreased friction increases speed, linking outcomes to unbalanced forces and energy transformations.
• Extend understanding by evaluating everyday examples, such as when smooth versus rough shoe soles are most effective.
Engineering Solution - Engineering Solution - Safety Device
Students engage in an engineering design challenge to apply Newton’s laws by preventing damage to a dropped object.
• Brainstorm, plan to criteria and constraints, and create scaled diagrams for a fruit-protection device.
• Build and test prototypes with limited materials by dropping fruit from 2 meters; predict outcomes and record bruise counts.
• Analyze results over two days, including measuring bruise depth after cross-sections; redesign and retest with a second fruit.
• Compile data and present designs and findings, comparing effectiveness across groups.
Scientific Investigation - Raceway
Students investigate motion by collecting and analyzing data to compare speed, velocity, and acceleration.
• Work in teams with rotating roles to time, walk, measure distances at 5-second intervals, and record data across multiple trials.
• Conduct several short walks with varied motion (constant speed, faster pace, stop/return, increasing speed) while marking positions with sandbags.
• Measure distances between markers, compile time–distance data, and ensure each group’s procedure reflects their own design.
• Create distance–time and speed–time graphs and analyze how the trials illustrate differences among speed, velocity, and acceleration.
Students explore energy transformations and heat transfer (conduction, convection, radiation) to connect potential, kinetic, and thermal energy within systems.
• Melt ice in their hands to identify the direction of thermal energy transfer.
• Build a foil “conduction bridge” and time how wax chips melt at different positions.
• Use a lamp and radiometer to observe how radiation affects vane motion at varying distances.
• Visualize convection with a lava lamp/heated air and test a paper spiral’s motion above a lamp.

Estimated 15 min - 30 min
In this activity, students make predictions and observations of how decreasing the amount of friction to surfaces increases the speed of the object.
Materials
Reusable
● 2 Hand-sized cloth towels (per class)
Consumable
● 1 Roll duct tape (per class)
SEP Connection
Preparation
This activity is best done on a hard-surfaced floor, not a carpeted floor. Make sure there is enough room for all students to work on the floor. Label start and finish lines for a five-foot distance where the student volunteers will travel.
Constructing Explanations and Designing Solutions
Planning and Carrying Out Investigations
Using Mathematics and Computational Thinking
During this activity, students will plan and carry out investigations to explore the phenomenon of why a skateboard stops moving when you stop pushing it, but a rolling ball keeps going. By manipulating the frictional forces acting on surfaces, students will identify independent and dependent variables, use tools to gather data, and evaluate the accuracy of their methods. They will construct explanations using models to describe the relationship between friction and motion, applying scientific reasoning to support their conclusions. Additionally, students will use mathematical and computational thinking to analyze data, identify patterns, and apply mathematical concepts to support their explanations of the phenomenon.
CCC Connection
Cause and effect: Mechanism and explanation, and Systems and system models, and Energy and matter: Flows, cycles, and conservation
During this activity, students will explore the phenomenon of why a skateboard stops moving when you stop pushing it, but a rolling ball keeps going for a while, by examining the cause and effect relationships involved in friction and motion. They will classify these relationships as causal, recognizing that the decrease in friction leads to increased speed, and use this understanding to predict outcomes in similar systems. Additionally, students will use system models to represent the interactions of forces and energy within the system, understanding that energy transfer drives the motion and affects the cycling of matter, such as the movement of the skateboard and ball.
Notes
1. Ask for two volunteers, and call them to the front of the room.
2. Have the class assemble at the start line, and describe to the class that the volunteers will travel to the finish line at the end of the three meters.
3. Ask the class who they think will get to the finish line first. Once a consensus is reached, tell the volunteers they have to slide their feet the entire distance.
4. Ask students if their pick has changed. Tell the student who was not the consensus pick to wrap a smooth towel around each shoe and use duct tape to secure it.
5. Have the volunteers begin to slide their feet from the start to the finish line.
6. The student using the towels should be the one who wins.
7. Begin a discussion with the class about why that student won. This will provide a great introduction to unbalanced forces and friction as they relate to Newton's laws of motion, kinetic energy, potential energy, and thermal energy.
8. You may also tie in this activity and the topic of friction with something the students can all relate to—shoes. Ask the following questions: When would it be most useful for shoes to have smooth soles? When would it be most useful for shoes to have rough soles or cleats?
Why do you think a skateboard stops moving when you stop pushing it, but a rolling ball keeps going for a while even after you stop pushing it?
1. How does friction play a role in the movement of the skateboard and the rolling ball?
2. In what ways can we reduce friction to make objects move faster or continue moving longer?
3. How do Newton’s laws of motion explain the differences in how a skateboard and a rolling ball behave when pushed?
Ask students why they think wrapping towels around shoes will make a difference. They may or may not know the term friction, but encourage them to describe how the towels change the race.

Estimated 2 hrs - 3 hrs
Preparation P.6.6.1, 6.5 & 6.7
Students use the scientific knowledge they gained as well as the 21st Century Skill of Collaboration to design and construct a safety device by applying Newton's laws of motion.
Materials
Printed
● 1 Student Journal (per student)
● 1 Engineering Design Process (per class)
Reusable
● 1 Computer, with Internet access (per group)
● 1 Colored pencils, set (per group)
● 1 Permanent marker (per group)
● 1 Metric ruler (per group)
● 1 Meterstick (per group)
● 1 Cutting knife (per teacher)
Consumable
2 Pieces of fruit, suggested items are apples or peaches—fruit that will bruise easily (per class)
Assorted materials for design, suggested items include:
● Cardboard
● Straws
● Masking tape
● Duct tape
● Bubble wrap
● String
● Graph paper
● Paper towels
● Paper plates
● The Student Journal can be printed individually for student use or as a reusable class set, or it can be assigned online. Make sure that each group has two pieces of fruit. Students will request materials to create their models. Select display materials that are readily available.
● Review the Engineering Design Process with students who have not practiced this skill before. Review how to make diagrams to scale with students who have not practiced this skill before. Students are tasked with actually building and testing a safety device for a piece of fruit to prevent injury (bruising). Students should list their steps in their lab journals. Students will present their design to the class.
Constructing Explanations and Designing Solutions
Planning and Carrying Out Investigations
Using Mathematics and Computational Thinking
During this activity, students will plan and carry out investigations by designing and constructing a safety device for fruit, applying Newton’s laws of motion to understand the phenomenon of why a skateboard stops moving when you stop pushing it, but a rolling ball keeps going. They will identify independent and dependent variables, use tools to gather data, and evaluate the accuracy of their methods. By constructing explanations and designing solutions, students will use mathematical and computational thinking to analyze data, optimize their designs, and support their conclusions with evidence, thereby deepening their understanding of motion and forces.
Cause and effect: Mechanism and explanation, and Systems and system models, and Energy and matter: Flows, cycles, and conservation
During this activity, students will use cause and effect relationships to predict the effectiveness of their safety device designs in preventing bruising on fruit, thereby exploring the phenomenon of energy transfer and motion. By constructing and testing their prototypes, students will classify relationships as causal, recognizing that the transfer of energy upon impact causes bruising, and they will use this understanding to improve their designs. Additionally, students will model the system of forces acting on the fruit and the safety device, gaining insights into how systems interact and how energy flows within these systems.
Design and construct a safety device for a piece of fruit that prevents injury (bruising).
Facilitation
A. Introduce the challenge, define the research problem, and explore the problem.
Introduce the design challenge.
Give each group a copy of the design challenge along with the rubric.
Discuss the criteria for the design challenge and allow students about 30 minutes to brainstorm ideas on how to accomplish the task.
Remind students that engineers usually work in groups or teams so that many different ideas can be generated and combined to come up with one great idea.
Divide the class into groups.
If needed, allow the students to do some quick research in order to find examples.
The design solution must include all needed materials, safety precautions, and procedures used so that anyone can replicate the investigation.
In order to maximize class time for Day 2, students should create a plan and a diagram of their safety device. The safety device is intended to prevent bruising on a piece of fruit when it is dropped from a height of two meters. The device should allow for the piece of fruit to be easily inserted and removed so that it can be examined (and possibly eaten).
Students should have a method of determining all criteria and constraints have been met.
Make sure the materials needed to complete the project are in a central location that groups can access as needed.
Suggest assigning roles (designer, builder, recorder, tester) so that all students are actively engaged.

6.5
FACILITATION TIP
Ask prompts such as:
“How will your design absorb impact?”
“Will the fruit stay in place during the drop?”
Prompt students to test small sections or components first, then adjust. P.6.6.1, 6.5 & 6.7
FACILITATION TIP
B. Build, test, and analyze the prototypes.
Make sure students have created a materials list, a safety precautions list, and a procedure before they proceed.
Assist students as needed.
Limit students to the materials that are provided in class.
Allow students to have this class period to build and test the prototype of their safety device using the first piece of fruit.
“How can you make your design reusable and easy to use?” Notes
Students should make predictions about the number and depth of bruises on the piece of fruit and record their predictions in their lab journal.
Testing of their prototype design can be done in the classroom and adjustments made as necessary to their device.
After they have made their initial drops, have the students examine the exterior of the fruit and inspect for bruises. Students should indicate the number of the bruises (indentations) with a permanent marker on the fruit itself and record the number of bruises in their lab journals.
At this time, the groups should propose modifications to their design. The teacher will indicate the particular piece of fruit to be used by each group and set it aside for the next class day.
Monitor as the students complete the design process.
Ask questions and redirect thinking as necessary.
C. Improve or redesign and retest the solutions.
Give the groups time to analyze their criteria for the design process.
The day after the fruit was dropped, students should re-examine for any additional external bruises and record on the piece of fruit as well as in their journals.
After all documentation has been completed, the teacher should cut the piece of fruit (along a cross section or lengthwise) so that the students can measure the depth of the bruise or indentation to the nearest millimeter and record each of the bruises (indentations). This should be relatively easy to examine since the bruise itself should turn a brown color.
At this time, students should complete any necessary redesigns of their safety devices. Students should then perform a final drop with the second piece of fruit, then examine the exterior of the fruit and inspect for bruises.
Students should again indicate the number of bruises (indentations) with a permanent marker on the fruit itself and record the number of the bruises in their lab journals for this second piece of fruit.
Assist the students in redesigning and retesting the solution as needed.
D. Collect and analyze data and prepare for presentations.
As before, have the students reexamine the exterior of the fruit and inspect it for bruises, indicate the number of additional bruises (indentations) with a permanent marker, and record in their lab journals the number of bruises that may have appeared overnight.
After all documentation has been completed, the teacher should cut the piece of fruit (along a cross section or lengthwise) so that the students can measure the depth of the bruises or indentations to the nearest millimeter and record each of the bruises (indentations) in their lab journals.
Determine how the group will present their prototype to the class and share the results with other groups.
E. Present and share the solutions.
Allow time for each group to present their results.
Let other groups ask questions. Discuss as desired.
Complete the group rubric for each group.
Discuss with students.
Hold a Post-Activity Discussion which includes the post-activity discussion questions for students to evaluate their solution and make notes for improvement.
Post-Activity Discussion
In conjunction with the student presentations, lead a class discussion that reinforces the engineering design process.
1. How did the use of a prototype assist in the final testing process?
2. What modifications to the design were made as a result of testing?
3. How could the class judge the effectiveness of different design prototypes?
4. Where did students experience the greatest challenges in designing and building their safety devices? What would they do differently in the future?
5. Evaluate each group's solutions. Could different aspects of two or more designs be combined to create a better solution?
6. If this process were to be extended to the actual production of a safety device, what do you think that process would look like from now to the time the safety device is ready for manufacture?
Some students may struggle with visualizing the effect of each step in their design. Before introducing this activity, strategically organize groups of students with mixed-level abilities to complete this project. Have each group member choose an appropriate role within the group so that all students take ownership of the project. Ask group members to think out loud when designing to help students visualize how one part of the device will impact the next. Find more strategies for students who have difficulty identifying cause and effect in the Intervention Toolbox.
Ask students to evaluate how combining features from different groups could improve results.

English Language Proficiency
Sentence Stems
For beginner and intermediate ELPs, have the materials translated to their native languages as a reference.
Students complete the graphic organizer as a group and may use the following sentence stems to help them.
Beginner/Intermediate
They may also draw pictures to help describe their safety device.
• The problem in the challenge is ______________________.
• The plan/hypothesis for the challenge is ______________________.
• The materials for the challenge are ______________________.
• The procedures to complete the challenge are ______________________.
• The following observations were made during testing ______________________.
• The results from the challenge are ______________________.
Advanced/Advanced High
These students may use the above sentence stems if needed, but they also need to complete the stems listed below. The more the students are able to communicate in writing, the better their understanding.
• We might be able to solve the challenge by ______________________.
• This could have happened because ______________________.
• One possible explanation is ______________________.
• I want to know why ______________________.
• Adding/Removing _________________ would cause ______________________.
Phenomenon Connection
How do Newton’s laws of motion help us understand why a skateboard stops moving when you stop pushing it, but a rolling ball keeps going for a while even after you stop pushing it?
1. How does the design and testing of a safety device for fruit relate to the concept of inertia and Newton’s first law of motion?
2. In what ways did friction play a role in your safety device design, and how does this relate to why a skateboard stops moving?
3. How can the concepts of force and motion, as applied in your safety device project, help explain why a rolling ball continues to move after being pushed?

Estimated 1 hr - 2 hrs
In this activity, students investigate the relationships between speed, velocity, and acceleration.
Materials
Printed
● 1 Explore Student Journal (per student)
● 1 Raceway Background (per student)
Reusable
● 1 Marker, permanent, black (per teacher)
● 1 Ruler, metric (per group)
● 1 Timing device, stopwatch (per group)
● 4 Bags, plastic, zip-top, storage, quart-sized (per group)
● 400 mL Sand (per group)
● 1 Clipboard (per group)
Consumable
● 1 m Tape, masking (per group)
● Students design an investigation in which they show speed, velocity, and acceleration. Arrange to have class in an open area, such as a long hallway, the gym, or outside. The students need a straight pathway up to 100 yards (91.4 m) long. Cut a 30 cm long strip of masking tape for each group. Place the strips of masking tape on the floor in open areas of the room. Write "start" on each strip of masking tape. Students begin at the starting line and walk in a straight line for 20 seconds at a time at various speeds. Make sure that there is enough space for each group to complete the activity.
● Prepare bags of sand to be used as place markers during the activity. Each group of students needs four bags. Use the permanent marker to label the bags 5 s, 10 s, 15 s, and 20 s for each group. Pour 100 mL of sand into each bag, and make sure to completely close the zip top.
● It is important to stress safety in this activity. Students need to be aware of their surroundings as they walk. The floors and tables should be cleared and the work areas clearly designated. Review the field safety rules if the investigation will be performed outside.
Constructing Explanations and Designing Solutions
Planning and Carrying Out Investigations
Using Mathematics and Computational Thinking
During this activity, students will plan and carry out investigations to explore the phenomenon of why a skateboard stops moving when you stop pushing it, but a rolling ball keeps going for a while even after you stop pushing it. They will identify independent and dependent variables and controls, use tools to gather data, and evaluate the accuracy of their methods. By collecting data on speed, velocity, and acceleration, students will construct explanations using mathematical and computational thinking to describe the relationships between these variables and the observed phenomenon. They will apply scientific reasoning to ensure their data supports their explanations and conclusions.
Cause and effect: Mechanism and explanation, and Systems and system models, and Energy and matter: Flows, cycles, and conservation
During this activity, students will explore the phenomenon of why a skateboard stops moving when you stop pushing it, but a rolling ball keeps going for a while even after you stop pushing it, by investigating the relationships between speed, velocity, and acceleration. They will use cause and effect relationships to predict and explain these phenomena, recognizing that systems may interact with other systems and that energy transfer drives the motion within these systems. Through designing and conducting experiments, students will classify relationships as causal or correlational, and use models to represent systems and their interactions, understanding that energy and matter are conserved and that energy transfer can be tracked as it flows through the system.
1. Students should be in groups of four so that there is a reader/activity director, a walker, a timer and a measurer. Students should rotate roles for each of the four trials. For example:
2. The student who is the timer counts aloud and has the reader/activity director place a sandbag every 5 seconds for 20 seconds as the walker moves along the area.
3. The person who is the measurer measures the distance between each of the sandbags.
4. The recorder writes down the distances for that particular trial; the recorders all share with each other as the trials are completed.
5. In Part I of the Investigation, students design an experiment in which a walker takes four different walks at different speeds.
6. Students collect distance and time data for a person who takes several different short walks. As outlined in the sample procedure, the first walk trial is a walk at a constant pace. The second trial is somewhat faster than in trial 1. In trial 3, the walker stops and returns to the beginning. Finally, in walk trial 4, they increase their speed as they walk toward the finish. Students design their own experiments, so each group has their own procedure that does not match each other's or the sample. Help the students determine different ways to facilitate their experiment, such as walking backward, stopping during the trial, increasing and decreasing, etc.
7. In Part II, students create graphs in their Student Journals to represent the motion during each of their walk trials. Graphs should be created for distance vs. time and speed vs. time. Students then complete the Analysis questions to compare speed, velocity, and acceleration for their different walk trials.
Act It Out
Have students demonstrate the definitions for speed, velocity, and acceleration. Students can use whole-body motions (e.g., walking or running) or hand gestures. Students can complete the activity individually as an exit strategy or in small groups as a skit.
How do the principles of speed, velocity, and acceleration help us understand why a skateboard stops moving when you stop pushing it, but a rolling ball keeps going for a while even after you stop pushing it?
1. Based on your observations from the activity, how do changes in speed and acceleration affect the motion of objects like a skateboard or a ball?
2. How does friction play a role in the motion of the skateboard and the rolling ball, and how can this be related to the data you collected during your trials?
3. In what ways do the concepts of inertia and momentum explain the differences in how the skateboard and the ball behave when you stop applying force?
While trial examples are given, remind students they can design their own (e.g., walking backward, sudden stop, speeding up gradually). This helps them distinguish between speed, velocity, and acceleration.
Some students may confuse distance vs. time with speed vs. time. Provide sample axes and a short mini-lesson if needed.
P.6.6.1, 6.5 & 6.7

Estimated 2 hrs - 3 hrs
In this investigation, students determine the relationship between potential, kinetic, and thermal energy in energy transformations that occur in different systems.
Materials
Printed
● 1 Explore Student Guide (per group)
● 1 Explore Student Journal (per student)
Reusable
● 2 Lamps, clamp (per class)
● 2 Light bulbs, incandescent (per class)
● 1 Plate, paper (per class)
● 1 String, piece, 22 cm (per class)
● 1 Tape, cellophane, 3 cm (per class)
● 1 Scissors (per teacher)
● 1 Ruler, metric (per class)
● 1 Timing device (per class)
● 1 Ice chest (per teacher)
● 1 Goggles, safety (per student)
● 1 Timing device, stopwatch (per group)
● 1 Ruler, metric (per group)
● 2 Cans, small, cat food, 5.5 oz or tuna, 5.0 oz (per group)
● 1 Candle, tea light (per group)
● 1 Lava lamp (per teacher)
● 1 Gloves, pair, insulated, safety (per teacher)
● 1 Projector, overhead or document (per teacher)
● 1 Cart, media or television, tall (per teacher)
● 1 Radiometer (per group)
● 1 Lamp, clamp (per group)
● 1 Light bulb, incandescent, 150 W (per group)
● 1 Thermometer, Celsius, 0–100° (per group)
Consumable
● 1 Ice, chip (per student)
● 1 Can, cooking fuel, such as Sterno (per teacher)
● 3 Wax balls, orthodontic wax, chocolate chip–sized (per group)
● 1 Foil, aluminum, regular, sheet, 15 cm x 15 cm (per group)
● 1 Tape, masking, 10 cm (per group)
● 1 Match, regular (per group)
● Prepare an aluminum foil bridge by cutting a 15 cm sheet of aluminum foil from the box and wrapping it around a ruler, folding it so that the bridge is four layers thick. Slide the foil off the ruler to complete the bridge. The candle needs to be about 2 cm below the foil bridge. Use small cat food or tuna cans or something nonflammable to raise the foil bridge about 2 cm high. Consider using a piece of wax paper under the setup for easy cleanup.
● Lava lamps may be purchased at stores or online. If not available, check with other teachers or students. Only one per teacher is needed. Be sure to plug in the lava lamp before class. Some lamps take longer to warm up and to start the flowing process. One tall media or television cart is needed for the cooking-fuel convection demonstration. The cart must be tall enough so that the projected light falls on the cooking-fuel can and its shadow appears on the screen or wall.
● Students need ice chips for Activity 1. Groups need a radiometer, a clamp light, and a 150-watt incandescent light bulb for Activity 4. Radiometers differ in their characteristics. Check to be sure that the distances, as described in these instructions, work for your equipment.
● For Activity 5, cut a paper spiral out of a paper plate so that it looks similar to the one in the picture below. Attach a string to the center of the spiral with a piece of tape.

● Print one single-sided copy of the Instructions for Stations on paper. Cut apart the instructions for each of the stations of the investigation. Tape the appropriate instructions at each of the station locations in your classroom.
Safety Precautions
● At the stations, carefully remove and insert electrical plugs in the outlets by grasping the plugs and not the cords.
● Make sure your hands are completely dry before touching the plugs.
● Keep electrical appliances away from water and water sources.
● Do not touch the light bulb with the spiral paper or your body because it is very hot and can cause severe burns.
● Set up stations or do activities as follows:
○ Activity 1: Temperature and thermal energy transfer
○ Activity 2: Conduction bridge
○ Activity 3: Convection in a lava lamp
○ Activity 4: Radiation
○ Activity 5: Paper Spiral
Background
Read the background information with students, or have students read it together in pairs.
Energy measures the ability to cause change within a system. Energy can cause matter to change position, speed, or state.
An underlying principle of our understanding of force, motion, and energy is the law of conservation of energy, which states that energy can be neither created nor destroyed but just changes form. Energy transformations within systems demonstrate the law of conservation of energy regularly in our lives.
When energy flow occurs in a system, measurable changes to parts of the system may occur, such as speeding up, slowing down, and getting warmer or cooler. The total amount of energy within the system remains the same, yet the forms of energy can change. A flashlight demonstrates energy transformation when the energy in a battery changes from chemical energy into electrical energy and then into light energy. A windmill demonstrates energy transformation when the kinetic energy of wind turns the blades, changing into mechanical energy, which is changed into electrical energy by the generator it powers.

Potential energy is the stored energy of position as compared to the "usual position" of an object. For example, if we consider the base of a slide as the usual position, then a child at the top of the slide has potential energy due to position. Another example is a bow: consider an undrawn bow as the usual position; the drawn bow has potential energy due to the position of the bowstring.
Kinetic energy is energy that is in motion (happening). Consider a child on the slide. When the child is moving from the top to the bottom, that child is in motion and has kinetic energy. The same thing is true with the bow and arrow. After the bowstring is stretched with the arrow, once the arrow is released, it has kinetic energy, or energy of motion.
Mechanical Energy
Radiant Energy
It is the energy of motion, or the ability to create motion, and can be categorized as forms of potential and kinetic energy.
It is light energy and can be categorized as a form of kinetic energy. It includes all electromagnetic waves, a great range of wavelengths of different energies, including radio waves, microwaves, visible light, and X-rays. It can travel through empty space, air, or even solid substances.
A runaway skateboard, pedaling a bicycle, chewing food, water rushing through a dam
Light bulbs, burning candles, the light from the Sun
Chemical Energy
Electrical Energy
Thermal Energy
It is the energy from reactions in chemical compounds and can be categorized as potential energy.
It is the flow of charged particles through a conductor and can be categorized as kinetic energy.
It is the energy related to the temperature of a substance and can be categorized as kinetic energy. Thermal energy is a result of tiny particles of matter that move (kinetic).
The faster the movement, the warmer the matter. All matter has thermal energy. Although we cannot see the motion, we can feel or see its effects.
Food, fossil fuels (petroleum, coal, natural gas), plants, batteries
Electrical power generators, static (the type that makes your hair stand on end)
A fire, a hot stove, a pizza just removed from the oven
Note that thermal energy is not the same as heat. Heat is energy transferred between substances or systems due to a temperature difference between them. So it is correct to say that a system contains thermal energy but not that it "contains" heat, since heat means energy that is transferred from one thing to another.
The Law of Conservation of Energy
Energy can be neither created nor destroyed; it just changes form. That energy can be demonstrated, observed, and measured in a system can be stated because of the law of conservation of energy. Contributions of many scientists over the years and new discoveries about different forms of energy have all supported the current acceptance of the law of conservation of energy by the scientific community.
An energy transformation is the change of energy from one form to another. Energy in different parts of a system can increase and decrease, but the total amount of energy stays the same. During transformation, energy can transfer from place to place. However, the total energy remains the same because there is a decrease in the available energy in the energy source and an increase in available energy in the energy receiver.
Constructing Explanations and Designing Solutions, and Planning and Carrying Out Investigations, and Using Mathematics and Computational Thinking
During this activity, students will plan and carry out investigations to explore the phenomenon of why a skateboard stops moving when you stop pushing it, but a rolling ball keeps going for a while even after you stop pushing it. They will identify independent and dependent variables, use tools to gather data, and evaluate the accuracy of their methods. By conducting investigations on energy transformations, students will collect data to construct explanations using scientific reasoning, applying the law of conservation of energy to explain the observed phenomena. They will use mathematical and computational thinking to analyze data and identify patterns, supporting their conclusions with evidence from their experiments.
Cause and effect: Mechanism and explanation, and Systems and system models, and Energy and matter: Flows, cycles, and conservation
During this activity, students will explore the cause and effect relationships in energy transformations within systems to understand the phenomenon of why a skateboard stops moving when you stop pushing it, but a rolling ball keeps going for a while even after you stop pushing it. They will classify relationships as causal or correlational, using models to represent systems and their interactions, and track the transfer of energy as it flows through these systems, thereby predicting phenomena in natural or designed systems.
Procedure and Facilitation
Activity 1: Temperature and Thermal Energy Transfer
1. Students should review and follow the instructions for Activity 1 of the Student Guide and answer questions for Activity 1 of their Student Journal.
2. Distribute one very small chip of ice to each student. The students should place the ice chip in the palm of their hand.
3. As the ice melts, facilitate a discussion regarding the direction of thermal energy transfer. Body temperature is about 37°C. Drawing from prior knowledge, students know that the temperature of water at the freezing/ melting point is 0°C. Energy transfer from their (warmer) bodies to the (cooler) ice causes an increase in the temperature of the ice, so it melts. The brain interprets the sensation of cold as thermal energy is transferring from the students' hands to the ice.
4. Have the students answer the questions in Activity 1 in the Explore Student Journal.
Activity 2: Conduction Bridge
1. Students should review and follow the instructions for Activity 2 of the Student Guide and answer the questions in Activity 2 of the Student Journal.
2. You may wish to show your students an animation of particles of matter in the solid, liquid, and gas phases to further illustrate how particles of matter touch in each phase.
Notes
Compare particle motion to students moving in a hallway. Faster motion equals higher temperature. More students moving overall equals more thermal energy.
6.5 & 6.7

3. Explain that matter in the gas phase does not always touch, as there is more space around each particle. Discuss fire safety with the students.
4. Have students follow this Student Procedure:
○ Use the ruler to place your cans so they are spaced about 15 cm apart.
○ Place the aluminum foil bridge over the top of the cans.
○ Use the masking tape to fasten the foil to the inside top of the can. (See picture below.)
○ Place the small wax chips at 3 cm, 8 cm and 13 cm across the foil.
○ Make sure the candle is about 3–4 cm below the foil.
○ Light the candle with a match.
○ Slide the candle under the first chip (located at 3 cm).
○ Start the timer.
○ Record the time it takes for each chip to begin melting.
○ Record your data in your Explore Student Journal and complete Activity 2 questions.
○ When cleaning up, be sure to recycle the aluminum foil.

Procedure Diagram
Activity 3: Convection in a Lava Lamp
1. Students should review and follow the instructions in Activity 3 of the Student Guide and answer the questions in Activity 3 of the Student Journal.
FACILITATION TIP
Compare to boiling water, hot air balloons, or the way warm air gathers near ceilings while basements stay cooler.
2. Place the can of cooking oil on a television or media cart high enough to show the convective currents in the overhead projector light or document projector. For safety, do not hold or move the can of cooking oil once it has been lit. The projector needs to project a solid white background on the screen to make the shadows of the heated air visible. To stop the flames, carefully place the cover for the can back on top.
3. Have students observe the shadow of the heated air rising from the can of cooking fuel.
4. Be sure students complete the questions in the Student Journal before moving on to Activity 4.
Notes
Activity 4: Radiation
1. Students should review and follow instructions for Activity 4 in the Student Guide and answer the questions for Activity 4 in the Student Journal.
2. Students use a lamp and radiometer to explore one of the characteristics of heat transfer by radiation and the effect of a change in distance. Explain to students how a radiometer works. A radiometer is a glass bulb that has very low pressure inside. Low pressure means there are fewer gas particles than in the surrounding atmosphere. In the bulb, there is a set of vanes that sit on a needle.
3. Caution students to handle the radiometer gently and not to turn it upside down. The vanes are white on one side and black on the other. When enough radiation strikes the vanes, they spin because the different colors absorb differing amounts of thermal energy. The white vanes reflect more radiant energy, and the black vanes absorb more radiant energy. When gas particles in the bulb of the radiometer hit the black sides of the vanes, more thermal energy is transferred to them than when they hit the white sides. The energized gas particles push harder off the black sides and create an unbalanced force that moves the vanes. Thermal radiation is thereby transformed into kinetic (mechanical) energy.
4. Have students follow the directions in the Student Guide to take three measurements.
5. Be sure students complete the questions in the Explore Student Journal before moving on to Activity 5.
Activity 5: Paper Spiral
1. Students should review and follow instructions for Activity 5 in the Student Guide and answer the questions for Activity 5 in the Student Journal.
2. In this activity, students work with a lamp and a spiral to test how the thermal energy is transferred via convection currents.
3. Be sure students complete the questions in the Explore Student Journal for Activity 5 and answer the conclusion and reflection questions for the Explore.

Compare radiation to standing near a heater. You feel warmth even without touching it, unlike conduction.
Students may assume “heat rises.” Reframe to: “Hot fluids (liquids or gases) rise because they become less dense.”

Safety Guide
Fire Extinguisher or Blanket
Have access to a fire extinguisher or blanket when burning materials.
Safety Goggles
When using any form of chemicals, it is safest to protect the eyes by wearing goggles.
Heat-resistant mitts
Wear hand protection when working with hot materials
Secure hair and loose items
Ask students to tie back long hair and to secure loose clothing or jewelry when working with heat sources.
Snowball Fight
● Each student should write a question or observation they made from the activity on a piece of paper and crumple it up into a loose "snowball."
● When you say "Go," have students participate in a snowball fight.
● When you call "Time," each student should pick up the closest snowball and answer the question or comment on the observation. You can have the students do this out loud, or they can write the answer or comment on the paper.
Phenomenon Connection
What role does energy transformation play in the motion and stopping of objects like skateboards and rolling balls?
1. How does the transformation of potential energy to kinetic energy and eventually to thermal energy relate to the motion of a skateboard and a rolling ball?
2. In what ways do friction and energy dissipation affect the stopping of a skateboard compared to a rolling ball?
3. How can the concepts of energy conservation and transformation help us understand the differences in motion between a skateboard and a rolling ball?
● Make sure to have a class discussion about some of the questions. Students should sit in small groups and discuss the information that is on their papers. Students may answer the question or talk about the concept shown in the picture or written about in the sentence. Notes

STEMscopedia
Reference materials that includes parent connections, career connections, technology, and science news.
Linking Literacy
Strategies to help students comprehend difficult informational text.
Picture Vocabulary
A slide presentation of important vocabulary terms along with a picture and definition.
Content Connections Video
A video-based activity where students watch a video clip that relates to the scope’s content and answer questions.
Career Connections - NASA Engineer
STEM careers come to life with these leveled career exploration videos and student guides designed to take the learning further.
Math Connections
A practice that uses grade-level appropriate math activities to address the concept.
Reading Science - Types of Energy
A reading passage about the concept, which includes five to eight comprehension questions.
Data Literacy
Student analyze data sets and interpret information related to the scope’s content.
PhET: Simulation Practice
Student activities using the PhET Interactive Simulations from the University of Colorado Boulder.
Claim-Evidence-Reasoning
An assessment in which students write a scientific explanation to show their understanding of the concept in a way that uses evidence.
Multiple Choice Assessment
A standards-based assessment designed to gauge students’ understanding of the science concept using their selections of the best possible answers from a list of choices
Open-Ended Response Assessment
A short-answer and essay assessment to evaluate student mastery of the concept.
Guided Practice
A guide that shows the teacher how to administer a smallgroup lesson to students who need intervention on the topic.
Independent Practice
A fill in the blank sheet that helps students master the vocabulary of this scope.
Extensions
A set of ideas and activities that can help further elaborate on the concept.
PhET: Simulation Practice
Student activities using the PhET Interactive Simulations from the University of Colorado Boulder.
Use this template to decide how to assess your students for concept mastery. Depending on the format of the assessment, you can identify prompts and intended responses that would measure student mastery of the expectation. See the beginning of this scope to identify standards and grade-level expectations.
According to Newton’s first law of motion, an object will stay in motion or stay at rest until an unbalanced force acts upon it.
Newton’s second law states that when a force acts on an object, it will cause the object to accelerate. The larger the mass of the object, the greater the force will need to be to cause it to accelerate.
Acceleration is a change in motion (direction, speed, or both). Acceleration of an object will always be in the same direction as the sum of forces applied to the object.
Newton’s third law states that when one object exerts a force on a second object, the second object exerts an equal force in the opposite direction on the first object.
Does Student Mastery Look Like?

Student Expectations
The student is expected to demonstrate an understanding of the relationship between distance and contact forces, including magnetic, frictional, and gravitational forces, using investigation and computations.
How can invisible forces like magnetism, friction, and gravity affect objects even when they aren’t touching them?
Key Concepts
• Force is measured in newtons (N). The total of all the forces acting on an object is called the net force. Force diagrams are used to represent all the forces acting on an object.
• The effect of force is dependent on the amount of force applied and the object’s mass.
• Types of contact forces are the applied force, normal force (support force), and friction force. At-a-distance forces are created by a gravitational field, a magnetic field, or an electric field.
• Experiments can be designed to test the effects of forces such as gravity, friction, and magnetism on objects.
Scope Overview
This unit develops students’ understanding of how forces and distance influence motion. Through kinesthetic argumentation, timed trials, and field mapping, learners compute speeds, compare surface friction effects, and visualize gravitational and magnetic interactions at a distance. They apply these concepts in an engineering challenge that balances criteria and constraints to reduce impact on a falling object. Across investigations, students analyze net force, mass, and direction, use data to justify claims, and connect contact and non-contact forces to observable changes in motion.
Scope Vocabulary
The terms below and their definitions can be found in Picture Vocabulary and are embedded in context throughout the scope.
Distance
A measure of how far apart two objects are Friction
A force that resists the motion of two surfaces sliding across one another Gravity
The force that causes objects with mass to attract one another
Magnetism
A force that attracts or repels objects toward or away from each other; caused by electrons in a substance
Net Force
The sum of all the forces acting on an object
Notes
Students analyze image pairs to predict and justify which scenarios cause greater changes in motion, applying concepts of force, mass, and direction.
• Review slide images and select which scenario produces the greater change in motion, then indicate choices by moving to a designated side of the room.
• Discuss and defend reasoning with peers on the same side, focusing on factors like force magnitude, mass, and direction; share out across groups.
• Record choices and explanations in the Forces document, noting which images show the greatest change in speed.
• Participate in a brief class debrief to reflect on observations and clarify misconceptions about net force and measuring motion.
Activity - Race Track Testing
Students investigate how different surfaces affect the motion and speed of toy cars through timed trials and data analysis.
• Set up 5-meter tracks on multiple surfaces with 1-meter intervals and make predictions about fastest and slowest surfaces.
• Conduct two timed trials per surface with assigned roles (starter and timers at each meter), recording times at each position.
• Calculate interval and overall speeds, compare results across surfaces, and discuss patterns observed.
• Collaborate to propose wheel modifications to optimize speed for different surfaces and reflect in journals.
Students explore how gravitational, magnetic, and electric forces act at a distance by mapping force fields with test objects.
• Model a gravity well and trace the path of a test mass to map gravitational pull and label system components.
• Use a bar magnet and compass to map magnetic field directions, tracing needle orientation at multiple positions around the magnet.
• Compare interactions with magnetic north and south by repositioning the compass and noting changes in needle alignment.
• Map electric forces by observing synthetic hair suspended in oil responding to a charged balloon, noting patterns that reveal the field.
Students apply knowledge of gravity and forces to design a solution that safely delivers an egg using a parachute.
• Observe and record how parachute size affects fall time, then brainstorm real-world applications.
• Work in teams with expert roles to analyze criteria/constraints and develop two scale-drawn parachute concepts.
• Select one design to build within weight and material limits; test, collect data, and iterate to protect the egg.
• Present the final solution and complete self and team evaluations using provided rubrics.

Estimated 15 min - 30 min
- 6.4 & 6.6 Forces
In this activity, students make scientific predictions based on several sets of images displayed by the teacher, one of which will produce a bigger change in motion.
Materials
Printed
● 1 Forces (per group or student)
● 1 Slide (per class)
Reusable
● 1 Computer with projector
Consumable
● 1 Length of masking tape for dividing classroom in half
● 1 Lab journal (per student, optional)
SEP Connection
Planning and Carrying Out Investigations
Analyzing and Interpreting Data
● Print one Forces document (per group or student).
● Ensure that the images from the Slide can be displayed on screen.
Constructing Explanations and Designing Solutions
During this activity, students will plan and carry out investigations by predicting which images will produce a bigger change in motion, identifying independent and dependent variables such as force and mass, and using these predictions to analyze and interpret data. They will evaluate the effects of invisible forces like magnetism, friction, and gravity on objects, even when not in contact, by constructing explanations based on evidence gathered from the activity. Students will engage in discussions to refine their understanding and apply scientific reasoning to explain how these forces influence motion, thus connecting their observations to real-world phenomena.
Notes
Patterns
Cause and effect: Mechanism and explanation
Systems and system models
During this activity, students will explore patterns in the effects of invisible forces like magnetism, friction, and gravity on objects, even when they aren’t touching them. They will identify cause and effect relationships by predicting which scenarios will result in greater changes in motion, recognizing that these macroscopic patterns are related to the nature of microscopic and atomic-level structures. Through this process, students will classify relationships as causal or correlational, using models to represent systems and their interactions, and understanding that some cause and effect relationships can only be described using probability.
1. Begin with a discussion:
○ What do you know about how things move? Things move in a straight line unless acted upon by another force.
○ Do you have to watch things move in order to know that movement has taken place? No, you do not have to watch things move in order to know that movement has taken place if you use a frame of reference.
○ Does it make it easier or more difficult for movement to take place if the object is heavier? Yes, it makes a difference if the object is heavier (more mass) because it takes more effort to move the object.
2. Distribute the Forces document page to each student in class, and project the Slide.
3. Have students consider what they have learned about motion, force, and direction.
4. For each of the sets of images, ask students to quietly consider each of the scenarios illustrated on the screen and decide which of the two will cause the greatest change in motion of the object. Have the students stand on the taped line, and then encourage them to move and stand on the side of the room that corresponds to their choice after they review the images side by side.
5. Before moving on to the next set of images, have students discuss with the other members of the side they chose why they chose that particular side. Listen for their explanations.
6. Ask one student from each side of the tape to share reasons why they made their particular choice. Listen for students to mention factors that would affect the change in motion of the objects, such as size of the forces.
7. Once the students have completed their analysis of all the images and have shared with others, have them complete the Forces document activity indicating which of the pictures had or will cause the greatest change in speed.
8. Take time to add any interesting information that you, or your students, can add. Alternatively, ask individuals or groups to share a list item, and ask if other groups have the same response. Look for original ideas.
Before moving to their side of the room, have students write down their prediction and reasoning. This makes them commit to an idea, which helps reveal thinking during discussion.

P.6.6.2 - 6.4 & 6.6
9. After the activity is complete, go through the Post-Activity discussion questions with your students.
○ What is one of the most noticeable things you noticed about each of the pictures? Answers will vary but should include that they noticed that the more people or the more objects are involved, the greater the force that is needed for movement.
○ What are some of the ways that we measure the types of movements? Answers will vary but should include speedometers, changing of positions, etc.
The following misconceptions are addressed in this activity.
● Students may think that force arrows are used to represent opposing forces; the greater force does not win, so the total force is equal to the value of the greater force.
● When using arrows to represent forces, the longer the arrow, the stronger the force. If values are given, arrows going in opposite directions must be subtracted from each other, and arrows going in the same direction must be added to one another. Students may mistakenly add the forces without considering the directions of the forces.
● Students may think that two forces acting in opposite directions will not cancel each other no matter what their strengths are.
How can invisible forces like magnetism, friction, and gravity affect objects even when they aren’t touching them, and how do these forces influence the motion of objects?
1. How do invisible forces like gravity and magnetism cause objects to move without direct contact, and what examples can you think of where this occurs?
2. In the activity, how did the size of the force affect the motion of the objects, and how does this relate to the concept of friction?
3. Can you think of a situation where two forces act on an object in opposite directions? How does this affect the object’s motion, and what role does gravity play in this scenario?
● Two forces of the same strength (value) acting on an object in opposite directions at the same time will cancel one another. Notes
P.6.6.26.4 & 6.6

Estimated 1 hr - 2 hrs
P.6.6.2 - 6.4 & 6.6 Forces
Students investigate the motion of toy cars and collect data to analyze the speed of the vehicles between various points (positions) and their overall speed as they travel across various surfaces.
Materials
Printed
● 1 Student Guide (per group)
● 1 Student Journal (per student)
Reusable
● 1 Toy car, windup or remote control, all having the same mass (per group)
● 1 Timer (per student)
● 1 Measuring tape or meterstick, metric (per group)
● 1 Ruler, metric (per group)
● 1 Calculator (per student)
● 5-meter length of Bubble wrap (per class)
● 5-meter length of Wax paper or parchment paper (per class)
● 5-meter length of Sandpaper
● 5-meter length of Other usable floor space, such as the floor in the classroom or hallway
Consumable
● 1 Roll masking tape (per group or surface)
● 1 Paper, chart (per class)
● 1 Paper, notebook (per student)
● Find an area at the school where groups can set up four different 5-meter tracks. If an area outside the classroom is not available, the classroom area will work for this experiment. Set up one track in each corner or in separate areas. This setup would be ideal, as the students can rotate from one track to another and can share materials.
● A windup or remote control car would work best. Give each group the same type of car, as the variable that is being tested is the type of surface, not the car.
● Copy the Student Guide and the Student Journal pages for each student.
Notes
Planning and Carrying Out Investigations
Analyzing and Interpreting Data
Constructing Explanations and Designing Solutions
During this activity, students will plan and carry out investigations to explore how invisible forces like friction affect the motion of toy cars on different surfaces. They will identify independent and dependent variables, collect and analyze data to determine the speed of the vehicles, and evaluate the accuracy of their methods. By interpreting the data, students will construct explanations for how friction influences the cars’ motion, applying scientific reasoning to support their conclusions.
Cause and effect: Mechanism and explanation
Systems and system models
During this activity, students will investigate how invisible forces like friction affect the motion of toy cars across different surfaces. They will identify patterns in the speed data collected, recognizing how macroscopic patterns are related to the microscopic interactions between surfaces and the cars. By analyzing cause and effect relationships, students will predict how changes in surface type influence the cars’ motion, understanding that these phenomena may have multiple causes. Additionally, students will use system models to represent the interactions between the cars and surfaces, acknowledging the limitations of these models in capturing all aspects of the system.
1. Students should be put into groups of six for this experiment.
2. To perform the tests, each group needs to create a "race track." Each group sets up an initial track for their first surface, and then student groups can rotate to other track surfaces created by other groups.
3. Student groups each create a 5-meter race track, marking off 1-, 2-, 3-, 4-, and 5-meter positions.
4. Have students consider the type of surface the car will be traveling across, and in their Student Journals, have them indicate which surface they think the car will travel across the fastest and which surface the car will travel across the slowest.
5. Allow students to carry out the investigation and record data and conclusions. Take time to walk around and verify that students are measuring correctly, recording data, etc.
6. Five students should be armed with stopwatches at various points along the track. The sixth person (the one who does not have the stopwatch) is the starter. That student says, "Ready, set, go!" and releases the car so that the students in the group who have stopwatches all start timing at the same time. As the car passes each point, the student at that point stops his or her stopwatch.
7. Students should record the times in their data charts.
Before the real trials, run one short practice so stopwatch holders know when to start/stop. This reduces inconsistent timing.
P.6.6.26.4 & 6.6

P.6.6.2 - 6.4 & 6.6 Forces
FACILITATION TIP
Speed calculation scaffolding: Walk through one example calculation of speed (distance ÷ time) as a class before students do it on their own.
8. Once the two time trials for each of the four surfaces are complete, head back to the classroom and analyze the data collected to calculate the speeds of the vehicles between various points and their overall speeds.
9. At this time, have students in their groups collaborate to discuss how they could modify the wheels of the car so that it will travel faster or slower depending on the surface. Have them complete their Student Journals along with the questions.
Graphic Organizer
You can have students discuss the information they have learned about changes in force and motion. After they discuss for about 5 to 10 minutes, have the students create a graphic organizer for the topics they discussed. Partners can complete the graphic organizer together.
● Have students get a piece of construction paper and fold it hot-dog style.
● Have them open the construction paper and fold it hamburger style.
● Instruct students to take the right corner and fold it to the middle fold. Then take the left corner and fold it to the middle fold.
● Tell them they should have two shutters, with a crease in the middle of each shutter. They should cut along the creases.
● On the outside, have them include the name and a pictorial representation of each of the following terms: unbalanced forces, speed, distance–time graph, and motion.
● On the inside flap, have students explain their pictorial representation.
● Opposite the inside flap, on the main body of the graphic organizer, instruct the students to provide a definition of the term.
How do invisible forces like friction affect the motion of objects, such as toy cars, even when they aren’t directly touching them?
1. How does the type of surface affect the speed of the toy car, and what role does friction play in this?
2. In what ways could we modify the toy car or the surface to minimize the effects of friction and increase the car’s speed?
3. How might other invisible forces, such as gravity or magnetism, influence the motion of the toy car on different surfaces?
Notes
P.6.6.26.4 & 6.6

Estimated 1 hr - 2 hrs
Students identify that gravitational, electrical, and magnetic forces between a pair of objects can be mapped by their effects on a test object (mass, charge, or magnet, respectively).
Materials
Printed
● 1 Student Guide (per student, group, or class)
● 1 Student Journal (per student)
Reusable
● Hair, synthetic, black, 3–5 mm long, 5 mL (per group)
● 1 Clay, ball, 130 g (per group)
● 1 Marble, glass, 6 g (per group)
● 1 Bowl, glass or metal, 25 cm diameter rim (per group)
● 1 Marker, black, permanent (per group)
● 1 Paper clip, small (per group)
● 1 Magnet, bar (per group)
● 1 Scissors (per class)
● 1 Fabric, wool, 15 cm x 15 cm piece (per group)
● 1 Ruler, metric (per group)
● 1 Book (per class)
● 1 String, any type, 50 cm (per class)
● 1 Paper, card stock or 3″ x 5″ index card (per group)
● 1 Oil, baby or mineral, bottle, small (per group)
● 1 Balance, electronic (per class)
● 1 Compass (per group)
Consumable
● 1 Plastic wrap, sheet, clear, 30 cm x 40 cm (per group)
● 1 Balloon, round, 9 in. (per group)
● 2 Paper, white, sheet (per group)
● 1 Tape, any type, strip, 3 cm (per group)
● The Student Guide can be printed individually for student use or as a reusable class set, or it can be assigned online. Print a copy of the Student Journal for each student.
● Cut wool fabric into 15 cm by 15 cm squares. The measurements of the fabric pieces do not need to be exact.
● Prepare a book for the demonstration of the Pre-Activity Discussion by wrapping and tying a string around it.
● Weigh clay to create a 130 g ball for each group.
● Prepare one (approximately) 5 cm diameter circle from a 3″ x 5″ card for each group. Students will use this circle to trace around in the mapping magnetic fields activity. You may need to adjust the size of the circle depending upon the length of your bar magnets.
● Place all materials for easy access by students.
● Prepare electric-force viewing bottles in advance. Purchase small clear plastic bottles of baby oil. Remove the bottle labels and the glue from the labels to provide an unobstructed view of the interior. Depending upon the size of your bottle, add 5 mL (1 teaspoon) or less of 3–5 mm long pieces of synthetic hair to the oil in the bottle. Caution students not to remove the cap from the bottle.
Scaffolding Suggestions for Appropriate Grouping
● Group students who need more guided practice, and spend more time with them. Let the other groups work more independently.
● Group students with mixed needs, and have them work together. Monitor all groups equally.
Planning and Carrying Out Investigations
Analyzing and Interpreting Data
Constructing Explanations and Designing Solutions
During this activity, students will plan and carry out investigations to explore how invisible forces like magnetism, friction, and gravity affect objects even when they aren’t touching them. They will identify independent and dependent variables, use tools to gather data, and analyze this data to construct explanations for the observed phenomena. By mapping gravitational, magnetic, and electric force fields, students will collect evidence to support their understanding of how these forces operate at a distance, demonstrating both attraction and repulsion, and apply scientific reasoning to explain the interactions observed.
Patterns, Cause and effect: Mechanism and explanation, and Systems and system models
During this activity, students will explore the phenomenon of how invisible forces like magnetism, friction, and gravity affect objects even when they aren’t touching them. They will identify patterns in the interactions of gravitational, magnetic, and electric forces and use these patterns to understand cause and effect relationships. By mapping force fields and observing the effects on test objects, students will classify these relationships as causal, recognizing that the forces can attract or repel without direct contact. Through this process, they will use models to represent systems and their interactions, gaining insights into the complex systems of forces acting at a distance.
Procedure and Facilitation
1. In Activity A, the students work in groups to map gravitational force fields using a test object and create a gravity well and trace the path using arrows to indicate the direction of the movement. As a group, students should agree on a summary statement that describes the interaction of the forces using a complete sentence in their Student Journal. Students also need to label a diagram to identify the parts of the system, and they need to use complete sentences to explain how the plastic wrap allows them to map the force field of gravity and how this demonstrates the law of gravity.
2. In Activity B, the students investigate magnetic north and a compass using a bar magnet. Students align the magnet's north and south ends to match those of the traced magnet on a piece of paper. As a group, students agree on a summary statement that describes the interaction between the north end of the bar magnet and the compass pointer. They also choose several positions (at least four) to place and trace around the compass on the circle path and draw in the positioning of the north end of the compass needle on each tracing of the compass.
3. In Activity C, students conduct a similar activity as that in Activity B, except instead of the magnetic north, they investigate magnetic south.

P.6.6.2 - 6.4 & 6.6
Ask: “What do the hairs do when the balloon gets closer? What happens when it moves away?” P.6.6.26.4 & 6.6
FACILITATION TIP
Students may lose track of which way the compass points. Circulate to check accuracy.
4. In Activity D, students align the magnet's north and south ends to match those of the traced magnet and its position. Students should note the positioning of the north end of the magnetic pointer while changing the position of the compass as you circle the bar magnet.
5. In Activity E, students map electric forces using a test object by placing a clear plastic bottle filled with mineral oil and small fragments of synthetic hair on the work surface. One student charges a balloon by rubbing it with a woolen cloth; a second student shakes the bottle to evenly distribute the pieces of hair throughout the oil. Students should observe the movement of the pieces of hair.
Pre-Activity Discussion Questions
Have students record answers in complete sentences.
1. What is a force? A push or a pull
2. Clearly, movement can be seen when I touch an object and apply a push or a pull. I can push the object (push the book), or pull it (hold the band and pull), and the motion of the book as a test object changes. However, we have been studying forces that can act at a distance. What are they? Gravitational and electromagnetic forces
FACILITATION TIP
Remind students to rub the balloon thoroughly on wool for a stronger effect. Sometimes weak charging frustrates groups.
3. The ability of these forces to act at a distance depends on force fields generated by a source object that exist invisibly around the object. We have learned that the strength of these force fields changes based on distance to the source object. How does distance affect the strength of these force fields? The closer something is to the source object, the stronger the force field is. (Interestingly enough, scientists have discovered that both gravitational and electromagnetic force fields extend to infinity, though they are stronger at distances closer to the source object.)
4. Does gravity demonstrate attraction or repulsion? Attraction
5. Does electromagnetism demonstrate attraction or repulsion? Both
6. If we think in terms of an object's force field, does gravity push or pull? Pull
7. If we think in terms of an object's force field, does electromagnetism (both magnetic fields and electric fields) push or pull? A magnetic field can push or pull. An electric field can push or pull. Because these force fields are invisible, we use test objects to demonstrate and map their existence.
8. What experience have you had with electric charges? Possible answers can include a battery, electrical wires in household items, being shocked when touching a doorknob, etc. Some electrical charges transfer energy because they have current, such as that found in a battery-operated device or as supplied to our schools and homes through wires. Some electric charges are static (still, not flowing) when an individual object has a positive or a negative charge.
9. How do you think a charged object could be similar to a magnet? Charged objects, such as magnets, interact with other charged objects by repelling or attracting, even when the objects do not touch.
Notes
Post-Activity Discussion Questions
Have students record answers in complete sentences.
1. How did you map gravitational force fields with a test object? Did the forces at a distance demonstrate a push, a pull, or both? How did the test object demonstrate interaction of the force fields? We mapped gravitational force fields by diagramming the interaction between the large and small balls in a gravity well. These forces at a distance demonstrated a pull. The observable motion was the motion of the less massive ball toward the more massive ball.
2. How did you map magnetic force fields with a test object? Did the forces at a distance demonstrate a push, a pull, or both? How did the test object demonstrate interaction of the force fields? We mapped magnetic force fields by diagramming the interaction between the bar magnet and the compass needle. Pushes and pulls were demonstrated by these forces acting at a distance. The interaction of the magnetic force fields pushed and pulled, causing motion of the freely rotating needle on the compass.
3. How did you map electric force fields with a test object? Did the forces at a distance demonstrate a push, a pull, or both? How did the test object demonstrate interaction of the force fields? We mapped electric force fields by diagramming the interaction between the synthetic hair and a charged balloon. Only pulls were demonstrated by the action of these forces at a distance. The interaction of the electric force fields pulled on the synthetic hair and caused it to move toward the balloon. The synthetic hair aligned in a pattern to show the electric force field produced by the charged balloon.
Jigsaw
For each step of this investigation, have students change groups. This should be done in a structured way. For instance, once initial groups are made, students should complete the Pre-Activity questions together. Before moving on, they should number off within the group. Each of the numbers should reconvene at a station together and then complete the lab portion of the activity together. Lastly, have these groups letter themselves (A–D, one letter for each student per group), then people with the same letters should convene to discuss the answers to the Post-Activity questions together. In this format, it is essential that each student have a personal Student Journal to track his or her own answers and data for this activity.
Phenomenon Connection
How do invisible forces like magnetism, friction, and gravity affect objects even when they aren’t touching them, and how can we map these forces using test objects?
1. How did the mapping of gravitational, magnetic, and electric force fields help us understand the effects of these forces at a distance?
2. In what ways did the test objects demonstrate the interaction of force fields, and how did this relate to the concept of invisible forces?
3. How can understanding these invisible forces and their interactions help us in real-world applications or technologies?
Explain to students force fields are like invisible instructions that tell objects how to move.
P.6.6.26.4 & 6.6

Estimated 2 hrs - 3 hrs
This Project-Based Learning Challenge is to solve the problem and create a parachute that will soften the effects of gravity without cracking the hard-boiled egg. Knowledge of gravity and the forces on Earth is needed. Students need to fully understand that without assistance, objects fall quickly back to Earth, and when a parachute is added, the rate of speed changes. Once an object has been dropped from the sky, it falls to the ground at a higher rate of speed than if a parachute were attached to the object. The parachute slows the speed of the object because it catches the wind, otherwise known as drag. The fact that the parachute is defying gravity in the form of air resistance is lift, and if the parachute is thrown instead of dropped, it adds a component of thrust. As the object lands, it needs to be protected so it is not destroyed. Cushioning the fall lessens the effects of gravity on the object.
Materials
Printed
● 1 Entry Document and Expert Roles (per student or group, automatically assigned)
● 1 Expert Mini-Workshops for each role (per expert/group, not automatically assigned)
● 1 Individual 21st Century Skills Performance Rubric (per student, automatically assigned)
● 1 Team Rubric Key (not assigned to student)
Reusable
● 1 Computer, with Internet access (per group)
● 1 Colored pencils, set (per group)
● 1 Scale (per class)
Consumable
● 1 Paper, graph (per group)
● Preset amount of a variety of materials that include boxes, bottles, cups, rubber bands, Bubble Wrap, foil, balloons, plastic shopping bags, metal washers, paper clips, yarn, etc.
● 1 Hard-boiled egg (per group)
● 1 Plastic egg with pennies for testing (per group)
● String (per group)
● Tape (per group)
Possible Student Deliverables
Parachute structure, slideshow presentations, chart, graph, largegroup presentations Activity
● Print one Entry Document and Expert Roles for each student; the students do see this information when you assign the component to them. Students can also see the Individual 21st Century Skills Performance Rubric when you assign the component to them.
● Prepare three different-sized parachutes to use as a demonstration for the students. This allows students to see how the size of the parachute affects the rate the object falls.
● Print one Expert Mini-Workshops set for each group's expert; the students do not see this information until you administer it to them. Students cannot see the Teacher Rubric KEY.
● Do an Internet search for "Orion: America's new spacecraft for human exploration." The website discusses and shows how NASA has created the Orion program and has had to test the effects of gravity on the actual Orion. To show a video of the Orion returning to Earth, search "Orion parachutes feature video." As the parachutes are deployed, the object can be seen slowing down due to the parachutes' minimizing the effects of gravity on the object as it falls to the ground.
Technology Suggestion
Please be aware some online videos may require an update to your computer's software and so may require additional preparation time. Teachers may want to test the playback of the videos on various devices before the lesson, as well as ask technical support personnel for video downloading options to avoid any possible Internet access issues
Additional Internet Resources
Locate and bookmark Web resources that your students can access for information about gravity. NASA websites should be bookmarked as well. Be sure that each group has at least one computer to access.
Planning and Carrying Out Investigations
Analyzing and Interpreting Data
Constructing Explanations and Designing Solutions
During this activity, students will plan and carry out investigations to explore how invisible forces like gravity affect objects, even when they aren’t touching them. They will identify variables and controls, collect and analyze data, and construct explanations based on evidence to understand the phenomenon of gravity’s impact on a parachute system. Through designing and testing parachutes, students will apply scientific reasoning to optimize their designs, demonstrating how air resistance can counteract gravity to protect a falling object.
Patterns, Cause and effect: Mechanism and explanation, and Systems and system models
During this activity, students will explore how invisible forces like gravity and air resistance affect objects, even when they aren’t in direct contact. By designing and testing parachutes, students will identify patterns in how different parachute sizes influence the rate of descent, linking macroscopic observations to underlying principles of physics. They will classify the relationships between parachute design and descent speed as causal, using these cause and effect relationships to predict outcomes in their designs. Through this process, students will develop an understanding of systems and system models, recognizing how parachutes interact with gravitational forces to form a complex system that can be modeled and analyzed.
The following PBL is written for a group or individual challenge.
● Group Designation and Team Forming
○ Separate the class into groups of four. Do NOT assign the Expert Roles until the students have read the Entry Document and Expert Roles as a team. You will address each item before giving whole-group instruction for Scale Drawings Directions.
● The Problem (Entry Document)
○ Show the Entry Event video to the class. In their student groups, students should read and discuss the Entry Document presented. Direct the students to highlight and take notes in the margins of the page. Students individually complete the Know and Need to Know section in their lab journal, then compile a list of Knows and Need to Knows for the team. You facilitate a whole-group discussion to clarify the problem and then set up a T-chart titled Know and Need to Know. You complete the Know column of the chart by requesting that the groups share one bulleted item at a time of what they learned from the Entry Event and Entry Document. This will bring out the criteria and constraints. Then do the same with the Need to Know column, writing each item in the form of a question, making certain to NOT answer any questions until they all have been asked. When recording the questions on the T-chart, the teacher should leave space between each one so that answers can be recorded. This chart should remain visible during the entire PBL. Review the steps for designing a solution using the Engineering Design Process.
Constraints:

P.6.6.2 - 6.4 & 6.6 Forces
Have students submit a quick sketch or scale drawing before building to ensure they’ve considered weight, materials, and constraints. P.6.6.26.4 & 6.6
FACILITATION TIP
Criteria:
● Draw and design two parachutes that will keep the hard-boiled egg from cracking.
● Draw a detailed scale drawing (blueprint) of the two prototypes.
● Present materials in a list or table that details safety considerations of the materials.
● Decide on only one parachute to build and test.
● Each team has one egg and one parachute.
● The parachute and the plastic egg with pennies cannot weigh more than 80 grams.
● Students have two days to complete the project and three minutes to present it.
1. What is the Engineering Design Process? Show the EDP graphic and explain each step.
2. What materials can we use to build our parachute? You must use only the materials your teacher has provided.
3. Where can we find information on parachutes? You may use any print or Internet resources available to you. Be sure to cite your sources.
4. How will this assignment be graded? Your team leader has a team rubric that will guide you as you design and build your parachute. There are also individual rubrics that will give you a grade based on your innovation.
5. Can we build both parachute designs in order to test which one is more effective? No, there are not enough materials for each team to build two parachutes.
● Whole-Class Workshop: Purpose and Benefits of a Parachute
○ Students take notes on the purpose of a parachute and how it slows down the effects of gravity on an object. The teacher demonstrates three different sizes of parachutes attached to a toy of some sort and dropped from about eight feet in the air. Students record in their journal the time it took for each parachute to land on the ground from the same distance. Students should observe that, depending on the size of the parachute, the toy takes a different amount of time to land. A larger parachute catches more wind than a smaller parachute, allowing the effects of gravity on the object to be slowed down. Once the activity is complete, brainstorm a list of real-life situations where a parachute is imperative and needs to slow down the effects of gravity. Notes
● Expert-Group Workshop Facilitation
○ After the students have had the whole-group lesson on Purpose and Benefits of a Parachute, have them refer back to the Entry Document. They decide who will be their Design Engineer Manager, Parachute Deployment Engineer, Materials Engineer, or Graphic Design Engineer. Call Expert Groups, one role at a time, using the specific Expert MiniWorkshop sheet to train them on their specific expertise and share provided resources. Explain to them the expectations for sharing their expert information with the rest of their team as the PBL progresses. Then have them return back to their assigned team.
○ While expert groups are being trained, the remaining team members can review the criteria and constraints and begin to brainstorm their solution.
● Teams work in collaboration to create a prototype for the solution.
○ When all students return to their original teams as Experts in their area to solve the Problem, begin the timer and monitor student groups to ensure that they are collaborating and working within the design criteria and constraints.
○ Once students have planned their design, they should build, test, and refine it as needed. During the building phase, the Project Manager begins planning the presentation and communication of the solution.
● Team Presentation and Evaluations
○ Team Rubric (found with the Project Manager Team Lead Instructions) Upon completion of the design and the group presentation, the Project Manager leads the group in completion of the rubric and distributes individual rubrics to each team member to complete.
○ Individual 21st Century Skills Performance Rubric. Each student should be given this document to evaluate his or her own participation in the group presentations. You can then choose to take the forms from there to add additional comments or have the student pass the rubric to the other team members of the group for peer evaluations.
Time Management: Since the challenge has a two-day build window, give students checkpoints (e.g., by end of Day 1, blueprint approved and materials gathered; by midpoint of Day 2, prototype ready to test).
P.6.6.26.4 & 6.6

This activity could potentially be noisy with the variety of materials used. Allow students who dislike loud noises to wear foam earplugs during the activity to prevent meltdowns from sudden bursts of loud noises (accidental popping of balloons). Integrate silent breaks to provide time for students to refocus. If they are still overwhelmed, provide a place for students to get away from the noise. Read more strategies for sensory overload in the Intervention Toolbox.
After the students have a chance to complete the activity and present, place them in a circle in an open area.
Explain to them that you will make a statement applying to the results from the first activity. If they agree with the statement, they should walk to the inside of the circle and stand facing someone who does not agree with the statement. Then, they can discuss why they agree and/or disagree with the statement.
Be sure to model the game before beginning.
Examples:
● A parachute affects gravity.
● Using a parachute strengthens gravity.
● Using a parachute weakens gravity.
● The egg traveled faster with the parachute attached.
● The egg traveled slower with the parachute attached.
Phenomenon Connection
How do invisible forces like gravity and air resistance work together to affect the motion of objects, such as a parachute slowing down a falling egg?
1. How does the size of a parachute affect the rate at which an object falls, and what role does air resistance play in this process?
2. In what ways can we manipulate the design of a parachute to maximize its effectiveness in counteracting gravity?
3. How do the concepts of thrust, drag, and lift apply to the parachute activity, and how can understanding these forces help us solve real-world problems involving gravity?
● Gravity did not affect this experiment. Notes

STEMscopedia
Reference materials that includes parent connections, career connections, technology, and science news.
Linking Literacy
Strategies to help students comprehend difficult informational text.
Picture Vocabulary
A slide presentation of important vocabulary terms along with a picture and definition.
Content Connections Video
A video-based activity where students watch a video clip that relates to the scope’s content and answer questions.
Career Connections - Civil Engineer
STEM careers come to life with these leveled career exploration videos and student guides designed to take the learning further.
Math Connections
A practice that uses grade-level appropriate math activities to address the concept.
Reading Science - What Is the Force?
A reading passage about the concept, which includes five to eight comprehension questions.
PhET: Simulation Practice
Student activities using the PhET Interactive Simulations from the University of Colorado Boulder.
Claim-Evidence-Reasoning
An assessment in which students write a scientific explanation to show their understanding of the concept in a way that uses evidence.
Multiple Choice Assessment
A standards-based assessment designed to gauge students’ understanding of the science concept using their selections of the best possible answers from a list of choices
Open-Ended Response Assessment
A short-answer and essay assessment to evaluate student mastery of the concept.
Guided Practice
A guide that shows the teacher how to administer a smallgroup lesson to students who need intervention on the topic.
Independent Practice
A fill in the blank sheet that helps students master the vocabulary of this scope.
Extensions
A set of ideas and activities that can help further elaborate on the concept.
Use this template to decide how to assess your students for concept mastery. Depending on the format of the assessment, you can identify prompts and intended responses that would measure student mastery of the expectation. See the beginning of this scope to identify standards and grade-level expectations.
Force is measured in newtons (N). The total of all the forces acting on an object is called the net force. Force diagrams are used to represent all the forces acting on an object.
The effect of force is dependent on the amount of force applied and the object’s mass.
Types of contact forces are the applied force, normal force (support force), and friction force. At-a-distance forces are created by a gravitational field, a magnetic field, or an electric field.
Experiments can be designed to test the effects of forces such as gravity, friction, and magnetism on objects.

Student Expectations
The student is expected to demonstrate an understanding of the composition and formation of the universe, as well as Earth’s place in the universe, using evidence from multiple scientific sources.
How did tiny particles from the Big Bang come together to form everything in the universe, including our planet Earth?
Key Concepts
• The universe is all of space, time, matter, and energy that exists.
• Galaxies are made of millions of stars, dust, and interstellar gases that stay relatively close together due to gravitational attraction.
• The galaxy we live in is the Milky Way galaxy, and it is a spiral galaxy.
Scope Overview
Students develop and refine an evidence-based understanding of how the universe formed, what it’s made of, and how gravity organizes it into hierarchical structures. Through collaborative modeling, diagramming, and analysis of historical and contemporary evidence, students compare explanations, trace evolving scientific ideas, and synthesize a consensus supported by data. They investigate how observations—from background radiation to telescopic and probe data—inform current models and clarify Earth’s place in the universe. Emphasis is on constructing, using, and evaluating models and multiple sources to justify claims.
Scope Vocabulary
The terms below and their definitions can be found in Picture Vocabulary and are embedded in context throughout the scope.
Asteroids
Large and small rocks or metallic masses orbiting the Sun; made up of materials similar to those that formed the planets
Comet
A celestial body of ice, dust, and rock with an elongated and elliptical orbit
Galaxy
A large grouping of stars in space
Gravitational Pull
The attraction between two objects due to the invisible force of gravity; the gravitational pull from the Moon is primarily responsible for the tides that form on Earth
Gravity
The force that causes objects with mass to attract one another
Moon
A celestial body that revolves around a planet
Orbit
A curved path followed by a satellite as it revolves around an object
Planet
A large celestial body that revolves around a star in a solar system
Relative Position
Where an object is located in relation to another object
Solar System
A star and the group of planets and other celestial bodies that are held by its gravitational attraction and revolve around it
Star
A celestial body consisting of a mass of gas held together by its own gravity in which the energy is generated by nuclear reactions in its interior
Sun
The luminous star around which Earth and other planets revolve; composed mainly of hydrogen and helium
Universe
All of space and the matter space contains
Students investigate explanations for how the universe formed by discussing, modeling, and synthesizing ideas.
• Elicit and share initial ideas about universe formation and the forces involved (including gravity).
• Collaboratively design and perform a human model that represents each group’s explanation.
• Present and observe group models to compare and contrast proposed theories.
• Use evidence and reasoning from the models to develop and record a class consensus theory.
Activity - Formation and Composition of the Universe
Students explore the formation and composition of the universe by modeling the big bang and tracing how scientific ideas have developed over time.
• Participate in a human model to simulate pre–big bang conditions, expansion, and galaxy formation using sashes and twine to represent mass and gravitational attraction.
• Create diagrams that depict how galaxies form and summarize the universe’s simplified composition.
• Analyze statements about theories and key discoveries, then sequence them on a timeline to connect evidence (e.g., telescopes, background radiation) with evolving ideas about the universe’s origin.
Making a Model - Structure of the Universe
Students construct and use a model to explore how gravity shapes the hierarchical structure of the universe.
• Build a layered model that represents stars within galaxies, galaxies within groups and clusters, and clusters within superclusters.
• Use the model to observe and explain relative motions and orbits driven by gravity and differences in mass.
• Discuss patterns and cause-and-effect relationships, citing the model as evidence for how mass and gravity organize cosmic structures.
Students investigate how different space technologies gather and interpret data to expand our understanding of the universe.
• Research a specific telescope, satellite, or space probe to learn its purpose, how it works, and key discoveries.
• Synthesize findings into a poster that visually explains the technology and its scientific contributions.
• Present to peers, field questions, and take notes during class presentations to compare tools and techniques.

Estimated 15 min - 30 min
Students create a human model of how the universe may have been formed.
Materials
Printed ● 1 Modeling Formation (per student)
SEP Connection
Developing and Using Models, Planning and Carrying Out Investigations, and Obtaining, Evaluating, and Communicating Information
During this activity, students will develop and use models to describe and predict the phenomenon of how tiny particles from the Big Bang came together to form everything in the universe, including our planet Earth. By creating a human model, students will evaluate the limitations of their models, modify them based on evidence, and represent systems and interactions, such as gravitational forces, to provide a mechanistic account of this natural phenomenon. Through collaborative discussion and investigation, students will gather and communicate scientific information to support their models and refine their understanding of the universe’s formation.
Notes
For this activity, students need space to move around as they act out their models.
Scale, proportion, and quantity and Systems and system models
During this activity, students will create and use human models to explore the phenomenon of how tiny particles from the Big Bang came together to form everything in the universe, including Earth. By engaging in this process, they will observe and understand how systems and their interactions can be represented at different scales, recognizing that phenomena observable at one scale may not be at another. They will also explore how gravitational forces and other interactions contribute to the formation of complex systems, using proportional relationships and models to represent these scientific concepts. Activity
1. Lead the class in a pre-activity discussion:
○ How do you think the universe was formed? Accept all ideas for now, but be sure the big bang theory is included.
○ What force or forces do you think allowed the different components of the universe—such as atoms and molecules, planets, stars, and galaxies—to form? Accept all answers, but be sure gravitational force is included.
2. Have students discuss within their group how the universe was formed.
3. Direct the students to create a human model to demonstrate their idea.
4. Have the groups share their models with the class.
5. End with a discussion:
○ What different theories for the formation of the universe did we see? Listen to students' observations of the models presented, and make a list.
○ What evidence or reasoning argues for each of these models? Accept all ideas that support a scientific explanation.
○ Based on our explorations today, how do you think the universe formed? Lead the students in developing a class theory for the formation of the universe and have them write it on their Modeling Formation document.
How did the forces and interactions that followed the Big Bang lead to the formation of complex structures in the universe, such as galaxies, stars, and planets, including Earth?
1. Based on your human models, what role do you think gravitational force played in the formation of the universe?
2. How might the interactions between tiny particles after the Big Bang be similar to the way ice melts and refreezes in our earlier discussion?
3. What evidence do we have that supports the idea that the universe’s formation involved a series of complex processes starting from simple particles?
Notes
FACILITATION TIP
Before leading a whole-class discussuion right away, give students 1–2 minutes to jot down ideas about universe formation. Then share with a partner before contributing.
FACILITATION TIP
Suggest that students assign roles in their group models (e.g., “I’m a star,” “I’m gravity,” “I’m an atom”) so movement has meaning.
FACILITATION TIP
Have groups briefly explain what each movement represents while performing. This strengthens science connections.

Estimated 1 hr - 2 hrs
E.6.8.1 - .8.3
In this task, students participate in modeling the big bang theory and create diagrams to summarize how galaxies formed and to show a simplified composition of the universe. Students then analyze statements concerning theories and supporting discoveries to create a time line concerning emerging ideas for the formation of the universe.
Materials
Printed
● 1 Student Journal: Formation and Composition of the Universe (per student)
● 1 Galaxy Labels (per class)
● 1 Formation Theories and Supporting Discoveries (per student)
Reusable
● 5 Sashes, cloth, strips, 6 cm x 2 meters (per class)
● 1 Twine, heavy, 60 cm (per student)
● 1 Scissors (per teacher)
● 1 Meterstick (per teacher)
● 1 Hole punch (per teacher)
● 1 Marker, permanent, black (per teacher)
● 1 Scissors (per student)
● 1 Glue stick (per student)
Consumable
● 3 Poster board (per class)
● 6 Tape, masking, 15 cm strips (per class)
Part I
● Print, cut, and laminate the Galaxy Labels to create name placards.
● Plan to distribute one galaxy card to five students to identify each student as a galaxy.
● Cut five cloth sashes such that they are about 2 meters long and 6 centimeters wide.
● Cut 22 pieces of twine into 60-centimeter lengths. Tie an end of one length of twine to the center of one cloth sash. Plan to tie the sash around the waist of the student holding the Whirlpool Galaxy placard such that the twine hangs like a tail.
● Tie one end from each of four lengths of twine to the second sash. Plan to tie the sash around the waist of the student holding the Sombrero Galaxy placard such that the four twine pieces hang.
● Tie one end from each of five lengths of twine to the third sash. Plan to tie the sash around the waist of the student holding the NGC 5866 Galaxy placard such that the five twine pieces hang.
● Tie six lengths of twine to each of the last two sashes. Plan to tie each of these sashes around the waists of students holding the placards for the Milky Way and Andromeda galaxies such that the six twine pieces hang.
● Plan to explain to students that the solar masses that appear on the placards for the five galaxies are estimated values—and that even larger galaxies exist in the universe.
● Write the Summation Sentence for each stage on a poster board. Be prepared to post each statement using masking tape as the students complete the appropriate stage.
Summation Sentences:
Stage 1: Pre-Big Bang. Summation Sentence for poster: The universe exists as a single extremely small, hot, and dense point in space.
Stage 2: The Big Bang. Summation sentence for poster: A single extremely fast and violent event occurs with unimaginable force, causing the universe to expand outward into previously empty space. As the matter began to cool, atoms and larger particles of matter formed.
Stage 3: Galaxies Form. Summation sentence for poster: Due to gravitational force, particles with greater mass attract nearby smaller particles, forming dense groupings of matter known as galaxies.
Part II
● Print one Formation Theories and Supporting Discoveries for each student.
Developing and Using Models, Planning and Carrying Out Investigations, and Obtaining, Evaluating, and Communicating Information
During this activity, students will develop and use models to describe and predict the phenomenon of how tiny particles from the Big Bang came together to form everything in the universe, including our planet Earth. By participating in a human model of the universe’s formation and creating diagrams, students will evaluate the limitations of these models and modify them based on evidence to represent the interactions and energy flows within the system. They will also plan and carry out investigations to gather data that supports their understanding of the universe’s formation, critically evaluate scientific information, and communicate their findings through timelines and discussions.
Scale, proportion, and quantity and Systems and system models
During this activity, students will use models to explore the phenomenon of how tiny particles from the Big Bang came together to form everything in the universe, including Earth. By engaging with the concept of Scale, Proportion, and Quantity, students will observe and analyze the formation of galaxies at various scales, understanding that phenomena observable at one scale may not be visible at another. They will use proportional relationships to gather information about the magnitude of properties and processes involved in the universe’s formation. Additionally, through Systems and System Models, students will represent the interactions and energy flows within the universe’s systems, recognizing the limitations of models in representing complex systems.
1. Introduce the activity by telling the students they will be part of a human model of the formation of the universe. Direct the students to watch for the summation sentence of each stage to be posted as they progress through the steps of the model. The poster boards are shown during the activity to the students much like teleprompter cards are flashed then posted. Select five students to wear the galaxy sashes and matching placards. Have the students tie the sashes around their waists.
2. Lead the class in a pre-activity discussion:
○ Name some objects found in the universe. Stars, moons, planets, galaxies
○ How do astronomers think these objects were created? Accept all answers, but guide students to the idea of the Big Bang.
○ What was the universe like before the Big Bang? Accept all answers, but guide students toward "nothing but energy."
3. Have students follow the prompts on the Student Journal to complete the model.
4. Hold a class discussion:
○ What do the students represent in the beginning of this model? All the energy that makes up the universe
○ What do the lengths of twine represent? The gravitational pull between the masses
○ What do the groupings of students represent? The grouping of students represents galaxies.
Instead of standing still with sashes, have the “galaxy students” physically drift apart in slow motion to model expansion over time. Pause and ask: What does this movement show us about the universe today?
.8.3

○ How is a galaxy a system? The stars and planetary systems are parts of the system.
○ What happened to the energy contained in the universe according to this model? Before the Big Bang, all of the energy was contained in one tiny spot. During the Big Bang, the energy was released and moved away from the spot. After the Big Bang, the energy moved out to form the currently expanding universe.
○ What happened to all matter contained in the universe according to this model? After the Big Bang, as the universe cooled, atoms began to form. Matter was then affected by the force of gravity to be attracted to more massive particles of matter and eventually form the galaxies containing the stars, planets, and planetary systems we know today.
1. Ask students to cut out each of the cards on the Formation Theories and Supporting Discoveries page.
Instead of having each student do the full timeline, assign small groups a subset of the cards. Each group becomes the “expert” on those events, then shares with the class as the timeline is built collaboratively.
2. Tell students to read and analyze each card to determine where the information should be placed on a time line and glue each card in the appropriate location on the time line in the Student Journal.
3. Discuss as a class:
○ What inventions and discoveries were instrumental in developing theories for the formation of the universe? The invention of the telescope was instrumental in developing the theories. Further development of the technology allowed telescopes to see farther and farther into space. The discovery of radio waves led to the ability to collect and measure the background radiation and determine the past density of the universe.
○ Why is the big bang theory the most widely accepted idea for how the universe formed? The big bang theory is supported by the evidence of background radiation, which indicates the universe is continually expanding, which supports the idea of an "explosion" from one point. Analysis of weak radio waves found throughout the universe provides evidence that the density of the universe has decreased over time.
Notes
This kinesthetic activity is a great way for students to create a model to represent the flow of matter and energy during the formation of our solar system. Some students may prefer not to be in close proximity to other students and may have difficulty with others in their personal space. This could cause them to become overwhelmed or anxious about being so close to others, which could lead to a meltdown or outburst. Students may also not understand appropriate distances from others. To minimize any confusion and/or frustration, prepare students who may have a difficult time during this activity, and explain how this activity will work. Find more strategies to assist students with positive and appropriate social interactions in the Intervention Toolbox.
Once students have finished answering the questions in the activity, have students participate in a peer review with a partner. Each pair of students swaps answers. Partners should look for accurate use of vocabulary in addition to supporting facts and evidence. After review, allow students time to complete revisions. Have students share their finished answers either in small groups or in a class discussion.
How did the tiny particles from the Big Bang come together to form everything in the universe, including our planet Earth, and what role did gravity play in this process?
1. How does the gravitational pull between particles help explain the formation of galaxies after the Big Bang?
2. In what ways does the model activity help us understand the transition from energy to matter in the universe’s formation?
3. How do the discoveries and inventions, like the telescope, enhance our understanding of the universe’s expansion and support the Big Bang theory?

Estimated 1 hr - 2 hrs
In this task, students build a model and use it to explain the hierarchical structure of the universe.
Materials
Printed
● 1 Student Journal: Structure of the Universe (per student)
● 1 Universe Structures (per pair)
Reusable
● 1 Scissors (per student)
● 1 Marker (per student)
Consumable
● 1 Paper plate, dinner size (per student)
● 1 Paper plate, dessert size (per student)
● 3 Brads (per student)
SEP Connection
Print one Student Journal for each student.
Print one Universe Structures for each pair of students. Cut apart along the dotted line so each student receives one set of structures.
Developing and Using Models, Planning and Carrying Out Investigations, and Obtaining, Evaluating, and Communicating Information
During this activity, students will develop and use models to describe and predict the hierarchical structure of the universe, evaluating the limitations of their models and modifying them based on evidence to understand how tiny particles from the Big Bang came together to form everything in the universe, including Earth. They will plan and carry out investigations to gather data on celestial structures and use this information to communicate scientific explanations about the formation and organization of stars, galaxies, and larger cosmic systems.
CCC Connection
Scale, proportion, and quantity and Systems and system models
During this activity, students will use models to explore the hierarchical structure of the universe, allowing them to observe how phenomena at different scales, such as the formation of galaxies and clusters, are influenced by the force of gravity. By constructing and analyzing the paperplate model, students will understand how systems interact at various scales and how proportional relationships, like mass and gravitational attraction, contribute to the organization of celestial bodies. This hands-on experience will help them grasp the concept that systems may have sub-systems and be part of larger complex systems, illustrating the interconnectedness and scale-dependent nature of the universe.
Notes
1. Lead the class in a pre-activity discussion.
○ Once the universe came into being, what caused the various celestial bodies and systems to form? The force of gravity pulled matter together.
○ Just like Earth is part of the solar system, what larger system is our Sun a part of? The Milky Way
○ What is the hierarchical structure of the universe? How are the stars organized? Accept all ideas.
2. You may choose to lead the class step-by-step through the construction of the model or have the students work within their groups to complete the model.
3. Lead the class in a post-activity discussion.
○ What force causes large masses to be attracted to each other? Gravity
○ Why does the Sun revolve around the black hole in the center of the Milky Way galaxy and not the other way around? The Sun has less mass than the black hole.
○ Why does the Milky Way revolve around the common center of the Local Group? The Milky Way galaxy has less mass than the common center of the Local Group.
○ What is the basic hierarchical structure of the universe? Stars are part of a galaxy, galaxies are part of a group, groups are part of a cluster, and clusters are part of a supercluster.
○ How does the paper-plate model help us make observations about the relative motions of certain bodies and the structure in the universe? The Milky Way galaxy and the Local Group are on such a large scale we are not able to directly observe the motion or position easily. The paperplate model allows us to observe the hierarchical structure, relative motions and positions of each of the selected bodies, and the similar patterns of motion for each of the systems.
○ What pattern are we able to identify using the model? Objects of less mass are attracted to and orbit objects of greater mass.
○ What cause-and-effect relationship does the pattern identify? The relationship between the force of gravity and the mass of an object causes objects of less mass, like a single star, to be attracted to and orbit a more massive object, like a black hole, to form galaxies. This results in the hierarchical structure of stars, galaxies, groups, clusters, and superclusters.
Notes
To help promote collaboration during construction, if students work in pairs or groups, assign roles (e.g., cutter, brad fastener, note-taker, discussion leader) to keep everyone engaged and avoid one student doing all the work.
Remind students that the paper-plate model is a representation and not to scale. Ask: “If the Sun were the size of this marker tip, how big would the galaxy be?” This emphasizes scale and why models are useful in science.

After the students have had enough time to complete their investigation, allow them to show you what they have learned from the activity by taking part in Ticket Out.
Ticket Out is a short written reflection about the lesson. Hand the students an index card. Have them write down the answer to the reflection question you write on the board.
● Example question: How would you describe the relationship between the Sun and ________?
● Response stem: I would describe the relationship as __________.
After the students complete the sentence stem, allow them to switch index cards with another student. They can read their sentence stems and talk about their responses.
How does gravity influence the formation and organization of celestial bodies in the universe?
1. How does the hierarchical structure of the universe, as demonstrated by your model, help us understand the formation of galaxies and other celestial systems?
2. In what ways does gravity act as a driving force in the organization of matter from the smallest particles to the largest cosmic structures?
3. How can we use models like the paper-plate activity to better visualize and comprehend the vast and complex structures of the universe?

Estimated 2 hrs - 3 hrs
Students research a specific telescope, satellite, or space probe to learn how different technologies are used to discover new and exciting information about the universe. Students create a poster and make a small presentation about their technology, its discoveries, and how it works.
Printed
● 1 Student Journal: Exploring the Universe (per student)
Reusable
● 1 Computer with Internet access (per group)
● 1 Marker, set (per group)
Consumable
● 1 Poster board (per group)
● 1 Art supplies, variety (per group)
● Student Journals can be printed individually for student use or as a reusable class set, or they can be assigned online.
● Arrange for computer access.
● Gather and display available supplies.
● Technology suggestion: You may want to review the process for using different search engine tools and the procedure for verifying sources of online information. You can also set up a web page with links for the assignment.
Developing and Using Models, Planning and Carrying Out Investigations, and Obtaining, Evaluating, and Communicating Information
During this activity, students will develop and use models to describe and predict phenomena related to the formation of the universe, such as how tiny particles from the Big Bang came together to form everything, including Earth. By researching specific telescopes, satellites, or space probes, students will evaluate the limitations of these models and modify them based on evidence to understand the mechanisms of natural phenomena. They will plan and carry out investigations using these technologies to gather data, evaluate the accuracy of their methods, and communicate their findings through presentations, thereby enhancing their understanding of the universe’s formation and the tools used to study it.
Scale, proportion, and quantity and Systems and system models
During this activity, students will explore how tiny particles from the Big Bang came together to form everything in the universe, including our planet Earth, by researching and presenting on various telescopes, satellites, and space probes. They will use models to understand systems and their interactions, observing how different scales of time, space, and energy phenomena are studied through these technologies. By examining the proportional relationships and scientific principles behind these tools, students will gain insights into the magnitude of properties and processes that are not observable at all scales, enhancing their understanding of the universe’s complex systems.
1. Lead the class in a pre-activity discussion:
○ What is the purpose of an astronomer's telescope? To gather light from a wide area and focus it in a small enough area to make it easy to study
○ Why are telescopes that rely on visible light used primarily at night? Light from the Sun makes it impossible to see light from stars.
○ What other tools and techniques do astronomers use to gather data about the solar system and the universe? Accept all ideas.
2. Students work in groups of three to four to complete this task. One grouping option is to group students who need more guided practice together and spend more time with them; let the other groups work more independently. Another option is to group students with mixed needs and have them work together; monitor all groups equally.
3. Assign each group technology to research, or let groups choose. Ensure that no two groups are researching the same topic. Telescope options could include the Hubble Space Telescope, Chandra X-Ray Observatory, Keck Observatory, Fermi Gamma-ray Space Telescope, Far Ultraviolet Space Explorer, Spitzer Space Telescope, WMAP, Very Large Array, and the Green Bank Telescope. Satellite options could include the International Space Station, Mars Reconnaissance Orbiter, Juno, and MAVEN. Space probe options could include Voyager 1, Voyager 2, Pioneer 10, Pioneer 11, Rosetta, Curiosity Rover, Cassini–Huygens, and New Horizons.
4. When students have completed their research and posters, have them present their poster and findings to the class and answer any questions from their classmates.
5. Remind students to take notes and complete the Student Journal during presentations.
6. Lead the class in a post-activity discussion.
○ Why were some telescopes in space? Some telescopes see light that is blocked by the atmosphere.
○ Why was no telescope capable of seeing all the different kinds of light? The technology to see one kind of light is very different from the technology for seeing a different kind of light.
○ Which telescope contributed the most to science over its lifespan? Accept all answers. Encourage creativity and awareness in their analysis of the telescope's contributions to science.
○ What is the difference between a satellite and a space probe? Satellites orbit an object, while probes fly past or land on an object.
○ Which tool or tools would you use to study beyond our solar system? Telescopes and probes can provide information from beyond the solar system.
○ Which technique is the best for exploring our solar system's position in the universe? Accept all answers. Encourage creativity and awareness in their analysis of contributions to science from each technique or technology.
Show a striking NASA or ESA image (e.g., Hubble Deep Field, James Webb’s Carina Nebula, or a rover’s selfie on Mars). Ask: “What tool do you think captured this?”
Suggest that groups include both visuals and analogies, such as comparing the function of their telescope/probe to something students use daily (“The Keck Observatory is like a giant pair of binoculars”).

Graphic
After the students have had time to observe everyone's presentations about various space exploration tools, provide them with a sheet of construction paper. Have the students fold the paper in half, hamburger-style, and draw a line down the middle to create two sections. Label one section as "History of Space Exploration" and the other section as "Future of Space Exploration." Ask students to draw a diagram under each label that best represents the label and to use the provided sentence stems to explain their diagrams. Ask them to share their graphic organizer with the class, and encourage them to read their sentences out loud.
● Stem: My diagram represents the history of space exploration because
● Stem: My diagram represents the future of space exploration because
How do the technologies we use to explore the universe help us understand the formation and evolution of everything from the Big Bang to our planet Earth?
1. How do different telescopes and space probes contribute to our understanding of how particles from the Big Bang formed stars, planets, and galaxies?
2. In what ways can the data collected by these technologies help us trace the history of matter from the Big Bang to the present universe?
3. How might future advancements in space exploration technology further enhance our understanding of the universe’s origins and the formation of Earth?
Notes

- .8.3
STEMscopedia
Reference materials that includes parent connections, career connections, technology, and science news.
Linking Literacy
Strategies to help students comprehend difficult informational text.
Picture Vocabulary
A slide presentation of important vocabulary terms along with a picture and definition.
Content Connections Video
A video-based activity where students watch a video clip that relates to the scope’s content and answer questions.
Career Connections - Astronomer
STEM careers come to life with these leveled career exploration videos and student guides designed to take the learning further.
Math Connections
A practice that uses grade-level appropriate math activities to address the concept.
Reading Science - Oh My Stars!
A reading passage about the concept, which includes five to eight comprehension questions.
Notes
Claim-Evidence-Reasoning
An assessment in which students write a scientific explanation to show their understanding of the concept in a way that uses evidence.
Multiple Choice Assessment
A standards-based assessment designed to gauge students’ understanding of the science concept using their selections of the best possible answers from a list of choices
Open-Ended Response Assessment
A short-answer and essay assessment to evaluate student mastery of the concept.
Guided Practice
A guide that shows the teacher how to administer a smallgroup lesson to students who need intervention on the topic.
Independent Practice
A fill in the blank sheet that helps students master the vocabulary of this scope.
Extensions
A set of ideas and activities that can help further elaborate on the concept.
Use this template to decide how to assess your students for concept mastery. Depending on the format of the assessment, you can identify prompts and intended responses that would measure student mastery of the expectation. See the beginning of this scope to identify standards and grade-level expectations.
Learning
The universe is all of space, time, matter, and energy that exists.
Galaxies are made of millions of stars, dust, and interstellar gases that stay relatively close together due to gravitational attraction.
What Prompts Will Be Used?
Does Student Mastery Look Like?
The galaxy we live in is the Milky Way galaxy, and it is a spiral galaxy.

Student Expectations
The student is expected to demonstrate understanding of how gravity affects the motion of objects in the solar system, and of how Earth, the Moon, and the Sun interact, by designing models and analyzing data.
• Gravity controls celestial motion in our solar system, our Milky Way galaxy, and throughout the whole universe. The celestial object with the strongest gravitational field has the strongest influence on the motion of other bodies near it. Orbits are a balance between forward momentum and gravity.
• The Sun continuously illuminates half of the Moon’s surface, however varying amounts of this illuminated surface are visible from Earth at any moment in time, changing from only a sliver to the full half of the illuminated Moon. These changes in the visibility of the Moon’s surface follow a predictable pattern called the lunar cycle.
• As Earth rotates on its axis, the Moon exerts a gravitational pull on Earth. Inertia acts as a counterbalance to the gravitational forces. Gravity and inertia are responsible for the creation of two ocean tidal bulges on opposite sides of Earth. This creates a predictable schedule of high tides and low tides that coincide with the lunar cycle.
• Eclipses occur when the Sun, Earth, and Moon are all aligned and one body casts a shadow on another body. A solar eclipse happens when the new Moon passes directly between Earth and the Sun. A lunar eclipse happens when Earth passes between the Sun and a full Moon.
• The Sun’s surface features, composed of the visible surface (the photosphere) and the outermost region (the corona), can affect Earth. Solar flares occur when magnetic energy that has built up in the solar atmosphere is suddenly released. Solar flares also produce bursts in the solar wind. Sunspots in the photosphere are areas with strong magnetic fields that are cooler, and thus darker, than the surrounding region.
E.6.8.4-8.7
This unit develops student understanding of gravity’s role in solar system motion and the interactions of Earth, the Moon, and the Sun through model design and data analysis. Learners build and use kinesthetic and physical models to explore orbital motion, lunar phases, eclipses, and tides; connect inertia and gravitational forces to stable revolution; and examine the Sun’s structure and activity. Students analyze observations, evaluate model limitations, apply scale to visualize distances and patterns, and communicate evidence-based explanations.
The terms below and their definitions can be found in Picture Vocabulary and are embedded in context throughout the scope.
Asteroid Belt
The region between the inner and outer planets where most asteroids orbit the Sun
Celestial Objects
Objects, such as planets, moons, and stars, that are located in space
High Tide
When the tide is at its greatest elevation
Inner Planets
The rocky, terrestrial planets Mercury, Venus, Earth, and Mars, whose orbits are inside the asteroid belt
Low Tide
When the tide is at its lowest elevation
Lunar Cycle
The Moon’s repeated pattern of movement and changes in appearance due to its position relative to Earth and the Sun
Lunar Eclipse
When the full moon passes into Earth’s shadow, causing the Moon to appear reddish in color when the Sun, Earth, and the Moon directly line up; lasts 1–3½ hours
Meteor
A small object that enters Earth’s atmosphere from space and burns due to friction, emitting light
Neap Tide
Tide with the smallest daily tidal range; occurs when the Sun, Earth, and the Moon form a 90-degree angle
Orbit
A curved path followed by a satellite as it revolves around an object
Outer Planets
The planets Jupiter, Saturn, Uranus, and Neptune, whose orbits lie beyond the asteroid belt
Solar Eclipse
When the Moon passes between Earth and the Sun, covering all or part of the Sun; occurs when the Sun, the Moon, and Earth directly line up; lasts for less than 12 minutes
Spring Tide
Tide with the largest daily tidal range, which occurs when the Sun, Earth, and the Moon line up with each other
Tide
The rise and fall of sea levels caused by the gravitational attraction of the Moon and the Sun
Students model and describe the relative motions of the Sun, Earth, and Moon through a scripted, kinesthetic performance.
• Work in small groups to read a script and assume roles (Sun, Earth, Moon via prop, Director, Narrator) with labeled materials.
• Use rope and a string-and-ball “Moon” to physically act out Earth’s orbit around the Sun and the Moon’s orbit around Earth while narrating the motions.
• Perform the sequence in space around the room (optionally filmed) and complete follow-up questions to document observations.
Activity - The Attraction Tango
Students explore how gravity and inertia interact to produce orbital motion and how Sun–Earth–Moon interactions drive daily tides.
• Model orbital motion using a ball-and-string setup to demonstrate how inertia and gravity balance to keep objects in stable revolution.
• Analyze motion when forces change and connect observations to Newton’s first law and planetary orbits.
• Construct and use a Sun–Earth–Moon tidal model to represent inputs, processes, and outputs that produce two daily high and low tides.
• Evaluate model limitations and relate lunar position to changing tide times and ranges, including spring and neap tides.
Making a Model - The Moon and the Sun Movements
Students use kinesthetic and physical models to investigate patterns and causes within the Earth–Sun–Moon system.
• Model solar and lunar eclipses using a central light source and “Moon-on-a-stick” to visualize alignments and shadows.
• Sequence lunar phases by rotating around a light source and recording observed illumination patterns.
• Construct a tidal model to show how Earth’s rotation and the Moon’s position produce predictable high and low tides.
• Use globes, flashlights, and balloon Earths to demonstrate day/night, Earth’s rotation, and revolution around the Sun.
Activity - Our Sun
Students investigate solar features, model the Sun’s structure, and communicate how solar activity affects life and technology on Earth.
• Analyze photos of sunspots, solar flares, and prominences; record predictions and key facts.
• Build and annotate a layered, 3D graphic organizer of the Sun’s structures.
• Research impacts of solar activity on Earth systems and technologies (e.g., GPS, power grids, communications).
• Prepare and deliver a 3–5 minute informational speech synthesizing findings.
Making a Model - Solar System Model
Students research assigned solar system objects and collaboratively build a scaled model to visualize distances and relative motion.
• Work in groups to investigate properties, surface features, and motion of specific objects (planets, moons, asteroids, comets), citing sources.
• Apply a 1 million km = 1 mm scale to calculate placements and construct a class model on 5 m paper with the Sun at the far left
• Record measurements and findings in journals/data tables and discuss scaling and gravitational forces that keep planets in orbit.

Estimated 15 min - 30 min
In this activity, students observe the motions of the Sun, the Moon, and Earth by creating a kinesthetic model of the orbital paths of Earth and the Moon around the Sun.
Materials
Printed
● 1 Acting Out Motions of the Sun, the Moon, and Earth (per student)
● 1 Acting Script (per student)
Reusable
● 1 String, 60 cm (per group)
● 1 Rope, lightweight, 4 m (per group)
● 1 Ball, table tennis (per group)
● 1 Marker, permanent, black (per teacher)
● 1 Tape, masking, roll (per teacher)
● 1 Camera, digital, video (per class)
Consumable
● 4 Labels, sticker (per group)
Developing and Using Models
Planning and Carrying Out Investigations
● Print one Acting Script document for each student in your class. These can be collected and reused. Print one Acting Out Motions of the Sun, the Moon, and Earth document for each student in your class.
● Make four sticker labels for each student group. Label them as follows: "The Sun," "Earth," "Director," and "Narrator." Wrap the string once around each table tennis ball, and tape it securely. Label each table tennis ball "The Moon."
During this activity, students will develop and use models to describe and predict the phenomenon of why planets orbit the Sun and do not float away into space. By creating a kinesthetic model of the orbital paths of Earth and the Moon around the Sun, students will evaluate the limitations of their models, modify them based on evidence, and use them to represent the systems and interactions involved. This hands-on experience will help students construct explanations and design solutions supported by evidence, applying scientific reasoning to understand the gravitational forces and interactions that govern planetary motion.
Patterns
Cause and effect: Mechanism and explanation
During this activity, students will use patterns to understand the phenomenon of why planets orbit the Sun and not float away into space. By observing and modeling the motions of the Sun, Moon, and Earth, students will identify patterns in orbital paths and use these patterns to explore cause and effect relationships, recognizing how gravitational forces create predictable paths and maintain the orbits of celestial bodies.
1. Distribute copies of the script to each student.
2. Have students get in groups and read through the Acting Script. Each group will read through it together.
3. Place the groups around the room to perform the play with props. If you have a group with five students, have the fifth student film the play.
○ Actor (the Sun): Peel and stick the Sun label as a name tag on your shirt.
○ Actor (Earth): Peel and stick the Earth label as a name tag on your shirt.
○ Director: Peel and stick the Director label as a name tag on your shirt.
○ Narrator: Peel and stick the Narrator label as a name tag on your shirt.
4. Direct students to answer the questions on the Acting Out Motions of the Sun, the Moon, and Earth document.
Why do the planets orbit the Sun and not float away into space?
1. Based on your observations during the activity, how does the gravitational force between the Sun and Earth compare to the gravitational force between Earth and the Moon?
2. How might the speed and direction of Earth’s orbit change if the gravitational pull of the Sun were stronger or weaker?
3. What role does gravity play in the stability of the orbits of planets and moons, and how might this be demonstrated through the kinesthetic model used in the activity?
Notes
FACILITATION TIP
Students tend to rush through movements. Prompt them to move slowly to reflect longer orbital timescales (e.g., Earth’s orbit = 1 year, Moon’s orbit = ~1 month). This helps highlight relative timing.

Estimated 1 hr - 2 hrs
In Part I, students demonstrate that systems in a dynamic equilibrium are stable due to a balance between inertia and gravity by modeling the revolution of one object around another. In Part II, students use a model to represent inputs, processes, and outputs due to interactions within the Sun–Earth–Moon system that result in daily tidal patterns on Earth.
Materials
Printed
• 1 Student Journal: The Attraction Tango (per student, group, or class)
• 1 Tidal Model (per group)
Reusable
Part I
• 2 Ball, table tennis (per group)
• 1 Tape, clear, 15 cm (per group)
• 1 String, lightweight, piece, 30 cm (per group)
• 1 Goggles, safety (per student)
• 1 Metric ruler (per teacher)
• 1 Scissors (per teacher)
Part II
• 5 Pushpins (per group)
• 1 Scissors (per group)
• 1 Pencil, colored, blue (per group)
• 1 Pencil, colored, brown (per group)
Consumable
Part II
• 1 Tape, roll, duct (per class)
• 1 Tape, clear, 2 cm (per group)
• 3 Cardboard, pieces, 12 in. x 12 in. (per group)
• 1 String, 20 cm (per group)
• Student Journals can be printed individually for student use or as a reusable class set, or they can be assigned online.
• Cut 30 cm lengths of string for each group in your class. For half of the table tennis balls, wrap string around each ball and secure it with cellophane tape. Each group receives one ball–string set and a table tennis ball without a string attached. Students also need goggles. While this activity does not call for students to release the ball being swung in the air, precautions are advised.
• Print one Tidal Model on white card stock or very heavy paper for each group in your class. The dimensions must be maintained as provided on the Tidal Model in order for this activity to work properly. Do not choose printing options such as Fit Printable Area.
Developing
Planning
During this activity, students will develop and use models to describe and predict the phenomenon of why planets orbit the Sun and do not float away into space. By modeling the revolution of one object around another, students will explore the balance between inertia and gravity, which maintains the stability of planetary orbits. They will evaluate the limitations of these models and modify them based on evidence to understand the mechanistic account of this natural phenomenon. Through this process, students will also plan and carry out investigations, analyze and interpret data, and construct explanations supported by evidence to deepen their understanding of gravitational interactions within the solar system.
Patterns
Cause and effect: Mechanism and explanation
During this activity, students will explore the phenomenon of why planets orbit the Sun and not float away into space by recognizing patterns in the balance between inertia and gravity. They will identify cause and effect relationships through modeling the revolution of one object around another, using these patterns to predict and explain the stability of planetary orbits within the solar system.
Part I: The Attraction Tango
1. For this activity, students work in groups of four.
2. Begin the activity with a discussion:
○ What force causes objects to fall toward the ground? Gravity
○ What do you have to do to an object to keep it from falling toward the ground? Use energy to cause it to move
○ Why does the Moon not fly away? The gravitational pull of Earth keeps it in orbit.
○ What would happen to the Moon if the gravity of Earth was suddenly turned off? The Moon would fly off into space.
3. Have students follow the directions listed on the Student Journal.
○ Put on a pair of goggles.
○ Take a table tennis ball and roll the ball across the floor of the classroom.
○ Take the table tennis ball with the string attached and hold the end of the string.
○ While holding only the end of the string, swing the ball around in a circle over your head like a lasso.
○ Stop moving your arm or hand.
4. Tell students to answer the questions.
5. Finish the activity with a discussion:
○ What keeps planets in orbit around the Sun? Gravity
○ What would happen if the gravitational pull of the Sun were turned off? Earth and all the planets would fly off into space. FACILITATION
After group practice, invite a few groups to demonstrate their swinging ball models for the class and explain in their own words what represents inertia vs. gravity.

○ What do the ball rolled on the floor and the released ball on a string have in common in terms of motion? Both the ball on the string and the ball rolled on the floor continue to move in a straight line until acted upon by a force such as gravity for the ball on a string and friction for the ball rolled on the floor.
Compare inertia to riding in a car—when the car stops suddenly, your body keeps moving forward. This helps connect Newton’s laws to everyday experiences.
○ Why do the ball rolled on the floor and the ball on the string continue to move in a straight line? According to Newton's laws of motion, a body in motion remains in motion until acted upon by a force.
○ What is the tendency of an object to maintain a constant motion called? The tendency to maintain the same motion is called inertia.
1. For this activity, students work in groups of four.
2. Begin the activity with a discussion:
○ What is high tide? High tide is the greatest distance inland a body of water reaches.
○ What is low tide? Low tide is the lowest point on land to which a body of water recedes.
○ What is a daily tide range? A daily tide range is the measurable distance between the water levels of high and low tides.
○ What typical pattern of daily tides occurs at most coastal locations on Earth with every cycle of Earth's rotation? Most coastal locations experience two high and two low tides each day.
Before students build the tidal model, ask them to predict whether high tide occurs once or twice per day and why. Compare their predictions to the model’s results.
○ What fundamental force could possibly be associated with daily tides? Accept all supported answers at this time. The entry statement of the student document indicates that gravity is a fundamental force that acts on all matter. However, students need to experience the activity before understanding the mechanisms of interactions.
3. Have students follow the directions listed on the Student Journal to create the model and simulations.
4. When students have completed the simulation, tell students to answer the questions.
5. Finish the activity with a discussion:
○ A limitation of this model is that it looks as if the Moon holds water in place while the solid Earth spins on its axis. What is really happening? The Moon's gravitational pull does not hold water in place while Earth spins. Rather, the Moon's gravitational pull bulges Earth's water on the surface toward the Moon as Earth rotates on its axis.
○ What are other limitations of this model? The model is also limited in that it implies water moves independently of the movement of solid Earth, which is not the case. Water is constrained by land masses and moves with the rotation of solid Earth.
Notes
○ Times for daily high tides and low tides change by a few minutes each day for coastline communities. What causes the time of daily tides to change as shown by your model? Each day, the Moon progresses along its orbital path, and the tidal bulge follows the Moon, directly affecting the times of tidal occurrence.
○ Why are we able to predict tides? We are able to predict tides because the tides are based on the positions of the Moon, Earth, and the Sun, which we can track.
○ Why does the Moon have a greater effect on Earth's tides than the more massive Sun? The Moon has a greater effect on Earth's tides than the more massive Sun because the Moon is much closer to Earth than the Sun.
○ When the formation of the Earth–Sun–Moon system causes linearly aligned gravitational forces, daily high tides are higher and low tides are lower than usual. Daily tidal ranges (the difference between water levels of high and low tides) are the greatest during spring tides; how often do they occur during each lunar cycle? Spring tides occur twice during each lunar cycle.
○ When the formation of the Earth–Sun–Moon system causes opposing gravitational forces, low tides are not as low as usual and high tides are not as high as usual. Daily tidal ranges (the difference between water levels of high and low tides) are the smallest during neap tides; how often do they occur during each lunar cycle? Neap tides occur twice during each lunar cycle. Notes

Safety Goggles
When using any objects that could cause harm, it is safest to protect the eyes by wearing goggles.
After students have had time to explore through the investigation, play a quick game of Find Your Section.
● Place the following vocabulary terms as headings on different sheets of chart paper in different sections of your classroom: Ocean Tide, Gravitational Pull, Lunar Cycle, First Quarter Moon, Full Moon, Last Quarter Moon, High Tide, and Low Tide.
● Pair the students with partners.
● Explain that they have to listen to your sentence that describes one of the vocabulary terms. Then they discuss with their partner before moving to the corner they think the sentence is describing. When all the partners have moved, let them know which partners were correct.
Possible descriptions/sentences could be the following:
● The daily change in the level of ocean water is _______.
● This is the attraction between two objects due to an invisible force.
● The Moon's repeated pattern of movement and changes in appearance due to its revolution around Earth is ______.
● The lunar phase when half the disk is illuminated and when the cycle is in the waxing phase is called the _______.
● This is the lunar phase when the entire disk is illuminated.
● The lunar phase when half of the disk is illuminated and when the cycle is in the waning phase is _________.
● This is the point when the tide is at its greatest elevation.
● The point when the tide level is at its lowest elevation is called the _______.
How does the balance between gravity and inertia keep planets in orbit around the Sun, preventing them from floating away into space?
1. How does the gravitational pull of the Sun compare to that of the Earth in keeping celestial bodies in orbit?
2. In what ways do the concepts of inertia and gravity explain the stable orbits of planets around the Sun?
3. How might the orbits of planets change if the gravitational force of the Sun were altered?

Estimated 2 hrs - 3 hrs
Students develop and use a kinesthetic model to predict and describe phenomena such as solar and lunar eclipses within the Earth–Sun–Moon system. Students make a tidal model to demonstrate how Earth rotates in and out of tidal bulges, causing shorelines to experience daily high and low tides. Students discover day and night are a result of Earth's rotation on its axis and a year is the result of Earth's revolution around the Sun.
Materials
Printed
● 1 Student Guide (per student, group, or class)
● 1 Student Journal (per student)
Part I: Solar and Lunar Eclipses
Reusable
● Paper, black sheets, as needed to cover windows (per class)
● 1 Lamp, shadeless (per class)
● 1 Light bulb, 60 watt (per class)
● 1 Cord, extension (per class)
● 1 Ball, table tennis (per student)
● 1 Golf tee (per student)
● 1 Hot glue gun (per teacher)
Consumable
● 6 Glue, sticks (per class)
Part II: Lunar Phases
Reusable
● Reuse paper and Moon balls from Activity 1
Consumable
● Reuse from Activity 1
Part III: A Tidal Model
Printed Material
● 1 Tidal Model (per group)
Reusable
● 5 Pushpins (per group)
● 1 Scissors, pair of (per group)
● 1 Pencil, blue (per group)
● 1 Pencil, brown (per group)
Consumable
● 1 Tape, cellophane, 2 cm (per group)
● 3 Cardboard, pieces, 12 in. x 12 in. (per group)
● 1 String, length, 20 cm (per group)
Part IV: Day and Night
Reusable
● 1 Flashlight (per group)
● Markers or colored pencils
● 1 Laminated time quadrant (per group)
● 1 Globe
Consumable
● 1 Large paperclip (per group)
● 1 Small foam ball (per group)
● 1 Tape, masking, roll (per class)
Part V: Model of Earth's Rotation and Revolution
Printed Material
● Picture of the Sun and Moon (per class)
Reusable
● Globe (per class)
● 1 Marker, permanent (per group)
● 1 Scotch tape, roll (per class)
Consumable
● Balloon (per group)
● Sharpened pencil (per group)
● Craft stick (per group)
● 1 Petroleum jelly, container (per class)
Developing and Using Models
Planning and Carrying Out Investigations
During this activity, students will develop and use kinesthetic models to describe and predict phenomena related to the Earth–Sun–Moon system, such as solar and lunar eclipses, tidal patterns, and the cycle of day and night. By engaging in these modeling exercises, students will explore the gravitational interactions that keep planets in orbit around the Sun, providing a mechanistic account of why planets do not float away into space. This hands-on approach allows students to evaluate the limitations of their models and modify them based on evidence, enhancing their understanding of celestial mechanics and the forces at play within our solar system.
Patterns
Cause and effect: Mechanism and explanation
During this activity, students will use kinesthetic models to explore the Earth-Sun-Moon system, identifying patterns in celestial movements that explain phenomena such as solar and lunar eclipses, tides, and the cycle of day and night. By recognizing these patterns, students can understand the cause and effect relationships that govern why planets, including Earth, orbit the Sun rather than floating away into space. This understanding is rooted in the gravitational forces and orbital dynamics that create predictable and observable patterns in our solar system.
Procedure and Facilitation
Preparation
● Prepare a "Moon-on-a-Stick" for each student by using hot glue to bond a table tennis ball to the flat end of a golf tee prior to class. (These can be reused each class period.)
● Set up the lamp with a 60-watt light bulb in a space large enough for the students to stand in a circle around the lamp. (The light bulb's height should be at the head level of standing students.) Use the extension cord, if necessary, and tape the cord onto the floor to lessen the tripping hazard. Darken the room so that the lamp is the only light source in the room (suggestions for window covering: black butcher paper or large, black, heavyplastic garbage bags.)
Facilitation
1. Each student performs the model individually, but they need a partner to view some aspects of the model. The student may be allowed to discuss the concepts with their group as needed.
2. Prepare to turn off the main lighting once students are in place around the lamp.
3. Turn the lights on once the students are ready to return to their seats.
4. You may also want to project an animation of the Earth–Sun–Moon system from an online source to support student understanding during the PostActivity Discussion.
Notes
FACILITATION TIP
Review partner expectations and behavior expectations while the lights are off.

Pre-Activity Discussion
1. What causes the Moon to change shape? The Moon changes shape due to the relative positions of Earth, the Sun, and the Moon.
2. What is an eclipse? An eclipse is when you cannot see the Sun for a while, or the Moon for a while.
3. Why do eclipses occur? Accept all ideas.
4. How could we test your ideas? Accept all ideas. Tell students to use their Moon-on-a-Stick to model how eclipses occur.
Post-Activity Discussion
FACILITATION TIP
If students struggle with writing complete sentences, provide sentence starters as needed.
For future content reference, have students record their answers in complete sentences in their lab journals throughout the discussion.
1. What is the cause that results in the effect of a solar eclipse? The alignment of the relative positions of Earth, the Sun, and the Moon is the cause of the effect of solar eclipses. A solar eclipse occurs when the Moon moves between the Sun and Earth during the new Moon phase, when the orbital path of the Moon intersects the orbital path of Earth.
2. What is the cause that results in the effect of a lunar eclipse? The alignment of the relative positions of Earth, the Sun, and the Moon is the cause of the effect of lunar eclipses. A lunar eclipse occurs when Earth is aligned between the Sun and the Moon during the full Moon phase, when the orbital path of the Moon intersects the orbital path of Earth.
3. What patterns occur in the Earth–Sun–Moon system that allow us to identify the cause of eclipses? The lunar phases, orbital paths, and relative movements of the system are patterns that occur in the Earth–Sun–Moon system that allow us to identify the cause of eclipses.
4. How could you use your diagrams of the eclipses as models to describe why eclipses occur? The diagrams are models that show the relative positions of Earth, the Sun, and the Moon that cause the lunar and solar eclipses. The areas of the shadows cast by the Moon during a solar eclipse and by Earth during a lunar eclipse show the effect of the relative positions on Earth.
Preparation
● Student Journals can be printed individually for student use or as a reusable class set, or they can be assigned online.
● Prepare a Moon-on-a-Stick for each student by hot gluing a table tennis ball on the flat end of a golf tee. (These can be reused for each class period.)
● Set up the lamp with the light bulb in a large space. (The light bulb's height should be at the head level of standing students.) Use either an incandescent or a fluorescent bulb to provide light shining in all directions. Ask students to stand in a circle around the lamp.
● Darken the room as much as possible by covering all windows and doors with black paper (suggestions for window covering: black butcher paper or large, black, heavy-plastic garbage bags.) Prepare to turn off the main lighting once students are in place around the lamp.
Facilitation
1. This activity works best in a completely darkened room with the lamp as the only light source in the room. Turn on the lamp at this time, and turn off any other lights in the room once the students are in position around the lamp.
2. As students begin performing the model, ask them to observe and report verbally to the group how much light they see on their moons. They should not see any light at this point. Ask students what Moon phase this would be, and have them record the Moon phase in their lab journal. This phase is a new Moon.
3. Model to show students how to make one-eighth turns. Ensure that students face the correct direction throughout the activity. Again, ask the students to observe and report how much light they see on their moons. Ask students what Moon phase this would be, and have them record the Moon phase in their lab journal. This phase is a waxing crescent. Ask students how they know it is waxing and not waning. You may want to use the reminders "wax on, wane off" or "light on the right = waxing."
4. Continue asking the students about the light they see on their Moon models at each of the phases. Ask students what Moon phase it would be for each of the rotations, and have them record the Moon phase in their lab journals.
5. When students rotate into the full Moon position, remind students to hold their Moon models so that the shadows of their heads do not block the light from the lamp.
6. When students rotate into the waxing gibbous position, discuss with the students how you know it is waxing. Stress that they should be seeing the shadow on the left side of the Moon now, so the lighted part of the Moon is now on the right. This is based on our location on Earth; in the southern hemisphere it would be the opposite.
7. When students rotate into the waning crescent position, have them explain whether the lighted section is getting larger or smaller. They should note that during waxing phases, it is getting larger, and during waning phases, it is getting smaller.
8. When students rotate into the new Moon phase once again, discuss how long this entire process would normally take (about 29 days).
Pre-Activity Discussion
1. We have modeled the motion of Earth, the Sun, and the Moon. How do we know that those motions exist? We can compare them with patterns that are easier for us to observe.
2. What are some patterns we can observe that indicate the motions of Earth, the Sun, and the Moon? Possible answers are seasons, day and night, eclipses, Moon phases, and tides. Write the list on the board.
Tell the students they are going to focus on lunar phases as a way to look at the cyclic patterns in the universe.
Post-Activity Discussion
For future content reference, have students record their answers in complete sentences in their lab journals throughout the discussion.
1. What is the first phase of the Moon called? New Moon
2. What is the shape of a crescent Moon? A fingernail
3. Which phase is larger: the crescent or the gibbous? Gibbous
If time is a constraint, have students work in pairs or small groups.

4. Why can we not see a new Moon? We cannot see a new Moon because the lighted side is facing toward the Sun.
5. How does the pattern of the lunar phases help us understand the movement of the stars in the Milky Way galaxy? By understanding the visual pattern created by the relative positions of Earth, the Sun, and the Moon as the Moon revolves around Earth, and Earth revolves around the Sun, we can look for similar patterns in the universe and galaxy to determine if other celestial bodies revolve around each other.
FACILITATION TIP
Before distributing materials, review safety expectations while using pushpins and scissors.
● Distribute the Tidal Model handout to each group. Each group also needs cardboard, tape, a blue map pencil, a brown map pencil, five pushpins, string, and scissors.
1. As students begin creating the model, remind students that their perspective is that of someone high above Earth looking down on the north pole. It is helpful to draw the diagram below to further student understanding of perspective as well as to help them see a "bigger picture." Explain that the diagram shows the direction of orbits of Earth and the Moon as seen looking down on the north pole (not to scale). The model shows that Earth rotates in and out of tidal bulges, causing continental shorelines to experience two high tides and two low tides each day. The large continental mass is emphasized in the model to give a clear visual of the high and low tides. The changing position of the Moon as it orbits Earth also changes the position of the tidal bulges. This results in a daily, predictable change in the times of high and low tides, given a specific location on Earth. Monitor use of models, and redirect as needed.
2. After Day 2, ask students how many high water levels the "continent" experiences on a daily basis. How many low water levels? Guide students to see where the "continent" is in high and low tide, if this is not apparent to them. Ask students if the one large continental mass is a true representation of land on Earth. Explain how the model exaggerates the size and height of the landmass for easy viewing of the effect of high and low tides and is not meant to be an exact replica of Earth's landmasses.
3. After Day 3, ask why the time for tides at any particular location changes on a daily basis. Each day, the Moon progresses along its orbital path, and the tidal bulge follows the Moon, directly affecting the time of high and low tide occurrence.
4. Discuss with students the limitations of models. The Moon's gravitational pull does not hold water in place while the solid Earth spins. Rather, the gravitational pull acts on all of Earth's water as the water is positioned due to Earth's rotation on its axis. The model is also limited in that it implies water moves independently of the movement of solid Earth, which is not the case. Water, in a particular location, is constrained by landmasses and moves with the rotation of solid Earth.
Preparation
● Time Quadrants can be printed individually for student note use or as a reusable class set.
● Place a globe at the front of the classroom for reference when making models.
● You may want to make a model as an example for them to refer to when making their own.
● Place materials needed for the model at a central location.
Facilitation
1. Explain that they will be creating a model of Earth and using it to make observations about the day and night cycle.
2. Have one member from each team collect the materials to create the model.
3. Move around the room facilitating the making of the model.
4. Explain that their focus should be on how the Sun's light falls on the X on their globe and the position of the Sun in relation to the location of the X at four different times.
5. Explain that Earth will be rotating counterclockwise to the next time period until observations have been made at all four time periods.
6. Explain that following the activity they will be providing a written explanation of their observations.
Pre-Activity Discussion
Ask students to share their ideas of what causes day and night. Record their responses on the board.
1. What do you think happens to the Sun during the night time? It is shining on the other side of Earth.
2. What comes first: day or night? Accept all answers.
Post-Activity Discussion
For future content reference, have students record their answers in complete sentences in their lab journals throughout the discussion.
1. What does this model indicate is the cause of day and night? Our location in relation to the Sun
2. In what direction does the Sun "rise" and "set"? Why? The Sun rises in the east and sets in the west. The direction of Earth's rotation causes the illusion of the sunrise and sunset in the east and west respectively.
3. Would you describe the pattern as cyclical or occasional? The pattern is cyclical since it repeats on a daily basis as Earth rotates on its axis.
Preparation
● You may wish to create a balloon model ahead of time for demonstration purposes. Alternatively, have your students use inflatable globes with suction cup darts to model Earth's tilt.
● Post the picture of the Sun in one part of the classroom and the picture of the full Moon on the opposite wall. Post the Constellation Cards from the Engage activity around the room as well.
Provide a word bank using vocabulary words to help students in their written explainations.

Safety Precautions
Safety needs to be reinforced due to the dangers of misusing the sharpened pencil or skewer.
1. Each group receives one balloon and one skewer.
2. Have one student in each group blow up the balloon only to the size of a cantaloupe (no larger than that, or it will pop).
If you do not have access to a globe, pull up a virtual globe for students to use.
3. Using the globe, students identify where Florida and China are located. On their balloons, they place a dot to mark and label those locations.
4. Using their craft sticks, students put a blob of petroleum jelly, about the size of a cotton ball, on the top and bottom of the balloon, or double layer using the scotch tape. It is important not to spread out the petroleum jelly.
5. They will carefully twist and insert the skewer into these entrance and exit points of the balloon.
6. Some balloons might pop. If this happens, the group will have to act out the rotation and revolution section.
7. Remind students that this lesson is not about the balloon and the skewer, but that these items will be used to model Earth's rotation on its axis and its revolution around the Sun.
8. Show students the picture of the Sun, full Moon, and stars on the wall, and tell them to observe these images as they model rotation.
9. Have them hold their Earth model out in front of them and turn it so that Florida is facing the Sun image to model daytime. Next, they turn their model away from the Sun to model night. As students use their models to make one full rotation, have them say, "Ro-DAY-tion equals ro-TA-tion." Be sure they recognize one rotation equals 24 hours.
10. Be sure that students take note of the images that can be seen from Florida as they rotate. Inform students that the Sun and stars maintain their location, but the Moon revolves around Earth, allowing us to see a different illuminated portion of the Moon at different times of the month. In this model, the illuminated portion of the Moon is in full view, but that is not always the case.
13. Reinforce with students that the Sun and stars stayed in the same location, but that as Earth revolved, they were able to see different constellations. FACILITATION
11. Next, students will model revolution. Place the picture of the Sun on a table, or have a student hold it. Have students hold their Earth models and stand in one large circle around the table.
12. To help students understand the difference between revolution and rotation, try this dance: Students side step twice (going counterclockwise). With each step, they say, "Revolve, revolve." Then, they count to eight while turning their model and say, "Rotate—2, 3, 4, 5, 6, 7, 8." Repeat this pattern over and over until they return to their original positions. Point out that it takes a long time to make it back around the room, which reinforces the fact that it takes 365 days for Earth to make a revolution around the Sun. (Note: Ensure students understand that revolution and rotation occur simultaneously.)
Mix, Pair, Share
After the students complete the explore part of the investigation, give them time to express what they have learned by participating in a Mix, Pair, Share.
Students should mix around the classroom until the teacher calls "pair." They should then find a partner to answer the teacher's question.
● Students should mix around the room.
● The teacher calls, "Pair up."
● Students should pair up with the person closest to them to make a high five.
● The teacher asks the question and gives time for students to think about the answer.
● Students share with their partner using a sentence stem.
● Possible questions and sentence stems could be the following:
○ Level 1 Knowledge Question: Can you list the two different types of eclipses?
■ Stem: The two different types of eclipses are _________.
○ Level 2 Comprehension Question: What can you say about the Moon's phases?
■ Stem: The Moon's phases are _________.
○ Level 3 Application Question: What would result if Earth rotated more slowly?
■ Stem: If Earth rotated more slowly, then _________.
○ Level 4 Analysis Question: What is the difference between a waxing crescent and a waning gibbous?
■ Stem: The difference between a waxing crescent and a waning gibbous is __________.
○ Level 5 Synthesis Question: Can you construct a model that demonstrates the lunar cycle?
■ Stem: I can construct a model that demonstrates the lunar cycle by _____________.
○ Level 6 Evaluation Question: What data was used to make the conclusion that Earth orbits the Sun?
■ Stem: The data I used to conclude that Earth orbits the Sun is ___________.
Phenomenon Connection
How does gravity influence the movement of celestial bodies, such as planets orbiting the Sun, rather than floating away into space?
1. How does the concept of gravity explain why planets, including Earth, orbit the Sun instead of drifting off into space?
2. In what ways do the models of solar and lunar eclipses help us understand the gravitational interactions between Earth, the Moon, and the Sun?
3. How can the tidal model demonstrate the gravitational pull of the Moon and the Sun on Earth, and how does this relate to the gravitational forces keeping planets in orbit?

Estimated 2 hrs - 3 hrs
In this activity, students observe various pictures of the Sun and, as a class, determine what structure is being shown, use a three-dimensional graphic organizer to model the structures of the Sun, and research the impact of these features on Earth.
Materials
Printed
● 1 Student Guide (per group)
● 1 Student Journal (per student)
● 1 Slideshow (per student or class)
● 1 Structures of the Sun (class set)
● 1 Model of the Sun (per student)
Reusable
● 1 Scissors, pair (per student)
● 1 Colored pencils or markers, box (per group)
● Computers with Internet access PowerPoint (optional)
Consumable
● 1 Glue, stick (per group)
● Prepare to project or make copies of pictures for each group of students.
● Print one Student Guide for each group in your class. Print one Student Journal for each student in your class. Print a class set of the reading Structures of the Sun and one Model of the Sun for each student.
Developing and Using Models
Planning and Carrying Out Investigations
During this activity, students will develop and use models to describe and predict the phenomenon of why planets orbit the Sun and do not float away into space. By observing and modeling the structures of the Sun, students will gain insights into the Sun’s magnetic fields and their effects, which can be related to gravitational forces that keep planets in orbit. This will help them understand and explain the unobservable mechanisms of gravitational interactions within the solar system.
Patterns
Cause and effect: Mechanism and explanation
During this activity, students will explore the structures of the Sun and their impact on Earth, using patterns to identify cause and effect relationships. By observing and modeling sunspots, solar flares, and prominences, students will recognize macroscopic patterns related to the Sun’s magnetic fields and their effects on technological systems on Earth. This understanding will help them predict phenomena such as disruptions in GPS systems and communication networks, illustrating the causal relationships between solar activity and its terrestrial impacts.
Notes
1. Place the following words on the board: Sunspot, Solar Flare, Solar Prominence.
2. Project the sunspot picture (1), and have students write in their Student Journal what they predict they are observing.
3. Describe the picture to the students by reading the following:
a. Visible or white-light images of the Sun show the photosphere and these dark areas. These dark areas are regions of intense magnetic fields. They appear dark because they are somewhat cooler than the surrounding gas.
4. Have students write two facts about the structure in their notebooks.
5. Project the solar flare picture (2), and have students write in their Student Journal what they predict they are observing.
6. Describe the picture to the students by reading the following:
a. This structure is a highly concentrated explosive release of energy within the solar atmosphere that occurs near the dark spots. It emits enormous amounts of energy.
7. Have students write two facts about the structure in their notebooks.
8. Project the prominence picture (3), and have students write in their Student Journal what they predict they are observing.
9. Describe the picture to the students by reading the following:
a. This structure is a large, bright, gaseous feature extending outward from the Sun's surface, often in a loop shape. These structures are anchored to the Sun's surface in the photosphere and extend outward into the Sun's corona.
10. Have students write two facts about the structure in their notebooks.
11. Tell students the correct names of each structure and have them change any wrong answers in their notebooks.
If time permits, have students who had the correct predictions share how they made their predictions.

FACILITATION TIP
If time is limited, read the Structures of the Sun orally to the class.
FACILITATION TIP
If students are able, allow them to practice their speech with a partner before presenting to the entire class.
12. Pass out the Model of the Sun to each student.
13. Have each student read the Structures of the Sun. Then, have them label and color the top of the graphic organizer (the one with the dotted lines).
14. Have students write two facts about each layer on the bottom of the graphic organizer.
15. After this is complete, have students cut out the graphic organizer, glue the bottom to the Student Journal, and glue the anchor tab to the side of the bottom.
16. Have students answer the questions in their Student Journals.
17. Read the driving question to the class and discuss what they know about sunspots and flares. How could this impact us here on Earth?
18. Have students select a topic to prevent repetition.
a. GPS systems
b. Cell phones
c. Power grids
d. Airplane navigation
e. Clocks
f. Astronauts and pilots
g. Communications
h. Radio waves
19. Instruct students to create an informational speech that is 3–5 minutes in length to include information needed. Make sure that the students include information about sunspots, solar flares, and magnetic fields on the Sun. Ensure that the informative speech consists of three parts: introduction of the topic, body (topic to be discussed), and a conclusion to wrap it all up.
20. Allow students to work for 45 minutes and complete work at home.
21. During the next class, have students present for at least 3 minutes but no more than 5 minutes.
Notes
Placemat
Take a piece of paper and draw a large circle in the middle. Divide the space outside the circle into roughly four equal sections using a pen or pencil. This is the "placemat." After the students have had the opportunity to explore the investigation, give them an opportunity to express their understanding of the Sun. Begin by grouping them into groups of four students. Have students create a duplicate placemat using yours as a model. Inside the center circle of the placemat, write the sentence stem the students will use. (Please see below for examples of sentence stems you could use.) Then, each student picks one of the four areas, completes the sentence stem, and draws a picture relating to the sentence he or she just completed. After all four students have written their sentence stem and have drawn their picture, allow them to share their placemat with the entire class.
Possible sentence stems could be the following:
● Level 1 Knowledge Stem: The Sun is located ___ within the solar system.
● Level 2 Comprehension Stem: The light we see comes from the Sun's
● Level 3 Application Stem: If the Sun were farther from the Earth, then
● Level 4 Analysis Stem: The Sun's interior must be very hot because ________.
● Level 5 Synthesis Stem: The Sun's layers are similar to layers found
● Level 6 Evaluation Stem: The Sun's energy moves by _________. You can have the placemat drawn on butcher paper to make it fun for the students. Notes
How do the structures and activities of the Sun, such as sunspots and solar flares, influence the gravitational forces that keep planets in orbit around the Sun instead of floating away into space?
1. How do the magnetic fields associated with sunspots and solar flares affect the gravitational pull of the Sun on the planets?
2. In what ways might solar activity, like solar flares, impact the stability of planetary orbits over long periods?
3. How does understanding the Sun’s structure help us comprehend the forces that maintain the orbits of planets in our solar system?

Estimated 1 hr - 2 hrs
Students are assigned celestial objects for research of properties, surface features, and relative motion. Students develop and use a scaled model to observe phenomena such as spatial distances between objects within our solar system that are too large to visualize.
Materials
Printed
● 1 Student Journal: Solar System Model (per student, group, class)
● 1 Solar System Model Project (per group)
Reusable
● 1 Meterstick (per group)
● 1 Calculator (per student)
● 1 Computer with Internet access (per group)
● 1 Scissors (per group)
Consumable
● 1 Paper, bulletin board, 5 meters (per class)
● 1 Tape, clear, 1 m (per class)
● 1 Lab journal (per student)
● 5 Sticky notes (per group)
Preparation
● Student Journal can be printed individually for student use or as a reusable class set, or it can be assigned online. Review the CER Key prior to conducting the CER with students. Print one Solar System Model Project per group.
● Obtain 5 meters of bulletin board paper and mark it off in 1-meter segments. Find a wall in the classroom or hallway to hang the paper, or clear a space to place the paper on the floor.

Model of Solar System with the Sun on the Far Left
● This model allows students to find the location of each planet more easily. Make sure students have calculators available.
Developing and Using Models
Planning and Carrying Out Investigations
During this activity, students will develop and use a scaled model to describe and predict the phenomenon of why planets orbit the Sun and do not float away into space. By constructing a model of the solar system, students will evaluate the limitations of their model and modify it to provide a mechanistic account of the gravitational forces that keep planets in orbit. This hands-on experience will help students understand the interactions and energy flows within the solar system, allowing them to apply scientific reasoning to explain the observed phenomena.
Patterns
Cause and effect: Mechanism and explanation
During this activity, students will develop and use a scaled model to observe patterns in the spatial distances and relative motion of celestial objects within our solar system. By identifying these patterns, students can explore the cause and effect relationships that explain why planets orbit the Sun and do not float away into space, recognizing the role of the Sun’s gravitational pull as a primary causal factor.
1. Ten groups are needed for this activity.
2. Tell the students their challenge is to use the scale 1 million kilometers = 1 millimeter to build a scale model of the solar system with their classmates.
3. Divide the class into ten research groups with the following assigned solar system object or objects:
○ Group 1: Planet Mercury and the Sun
○ Group 2: Planet Venus and associated moon(s)
○ Group 3: Planet Earth and associated moon(s)
○ Group 4: Planet Mars and associated moon(s)
○ Group 5: Planet Jupiter and associated moon(s)
○ Group 6: Planet Saturn and associated moon(s)
○ Group 7: Planet Uranus and associated moon(s)
○ Group 8: Planet Neptune and associated moon(s)
○ Group 9: Asteroids and Asteroid Belt
○ Group 10: Comets and Meteors
4. It is important for students to cite where they found their information. Review proper citation with students if appropriate.
5. You may want to review the process for using different search engine tools and the procedure for verifying sources of online information if students will be using computers for research. You can also set up a web page with links for the assignment.
Pre-Activity Discussion
1. The Roman name for the Sun was "Sol," which is why we call our planetary system the solar system. The solar system spans a distance of 14,900,000,000 km. The solar system is so huge—how can we study it? Accept all ideas, but mention making a model if the students do not mention it. It is impractical to try to build a model of the solar system unless we build it to scale.
2. How do you make something to scale? Use mathematical ratios and proportioning
Ask students if they have ever created any other models of something and how they made them to scale.

FACILITATION TIP
Allow students to work in small groups to complete their answers if needed.
For future content reference, have students record their answers in complete sentences in their lab journals throughout the discussion.
1. Why did we have to make a scale model rather than a full-size model? The solar system is too big for a full-size model.
2. Why do the planets stay in orbit around the Sun? The gravitational pull of the Sun is the largest.
3. What data surprised you about the object your group researched? Answers will vary.
Sample Student Responses and Answer Key Scale Model Distances:
Sun = 0
Mercury = 57.9 mm
Venus = 108.2 mm
Earth = 149.6 mm
Mars = 227.9 mm
Asteroids = 300–600 mm
Jupiter = 778.3 mm
Saturn = 1.4 m
Uranus = 2.9 m
Neptune = 4.5 m
Comet, meteor, and other answers will vary depending on research. All data should be in a data table.
For this activity, there are several specific components students need to research. A teacher-made table outline or graphic organizer handout may allow students to complete their research in an organized way without leaving out or forgetting to cover certain information. Students may have difficulty creating their own data table, so if they already have a handout, they are more likely to stay organized. Learn more strategies for helping students conduct research in the Intervention Toolbox.
Notes
After students have had enough time to explore the investigation, allow them to show you what they have learned from the investigation by taking part in Ticket Out. Ticket Out is a short written reflection about the lesson. Give each student an index card. Have all students write down the answer to the question you write on the board to reflect on the lesson.
● Question: How does building a scale model of the solar system help us better understand the distances between planets?
○ Stem: Building a scale model of the solar system helps us better understand the distances between planets because _____. After students complete the sentence stem, allow them to switch index cards with another student. They can read their sentence stems and talk about their answers.
How does the gravitational pull of the Sun keep the planets in orbit, preventing them from floating away into space?
1. Based on your research and the scale model, how does the distance of each planet from the Sun affect its orbital speed and path?
2. How does the mass of the Sun compare to the mass of the planets, and why is this significant in maintaining the planets’ orbits?
3. What role does gravity play in the motion of other celestial objects, such as asteroids and comets, within our solar system?
Notes

STEMscopedia
Reference materials that includes parent connections, career connections, technology, and science news.
Linking Literacy
Strategies to help students comprehend difficult informational text.
Picture Vocabulary
A slide presentation of important vocabulary terms along with a picture and definition.
Content Connections Video
A video-based activity where students watch a video clip that relates to the scope’s content and answer questions.
Career Connections - Astronomer
STEM careers come to life with these leveled career exploration videos and student guides designed to take the learning further.
Math Connections
A practice that uses grade-level appropriate math activities to address the concept.
Reading Science - Ocean Tides
A reading passage about the concept, which includes five to eight comprehension questions.
PhET: Simulation Practice
Student activities using the PhET Interactive Simulations from the University of Colorado Boulder.
Claim-Evidence-Reasoning
An assessment in which students write a scientific explanation to show their understanding of the concept in a way that uses evidence.
Multiple Choice Assessment
A standards-based assessment designed to gauge students’ understanding of the science concept using their selections of the best possible answers from a list of choices
Open-Ended Response Assessment
A short-answer and essay assessment to evaluate student mastery of the concept.
Guided Practice
A guide that shows the teacher how to administer a smallgroup lesson to students who need intervention on the topic.
Independent Practice
A fill in the blank sheet that helps students master the vocabulary of this scope.
Extensions
A set of ideas and activities that can help further elaborate on the concept.
Use this template to decide how to assess your students for concept mastery. Depending on the format of the assessment, you can identify prompts and intended responses that would measure student mastery of the expectation. See the beginning of this scope to identify standards and grade-level expectations.
Gravity controls celestial motion in our solar system, our Milky Way galaxy, and throughout the whole universe. The celestial object with the strongest gravitational field has the strongest influence on the motion of other bodies near it. Orbits are a balance between forward momentum and gravity.
The Sun continuously illuminates half of the Moon’s surface, however varying amounts of this illuminated surface are visible from Earth at any moment in time, changing from only a sliver to the full half of the illuminated Moon. These changes in the visibility of the Moon’s surface follow a predictable pattern called the lunar cycle.
As Earth rotates on its axis, the Moon exerts a gravitational pull on Earth. Inertia acts as a counterbalance to the gravitational forces. Gravity and inertia are responsible for the creation of two ocean tidal bulges on opposite sides of Earth. This creates a predictable schedule of high tides and low tides that coincide with the lunar cycle.
Eclipses occur when the Sun, Earth, and Moon are all aligned and one body casts a shadow on another body. A solar eclipse happens when the new Moon passes directly between Earth and the Sun. A lunar eclipse happens when Earth passes between the Sun and a full Moon.
The Sun’s surface features, composed of the visible surface (the photosphere) and the outermost region (the corona), can affect Earth. Solar flares occur when magnetic energy that has built up in the solar atmosphere is suddenly released. Solar flares also produce bursts in the solar wind. Sunspots in the photosphere are areas with strong magnetic fields that are cooler, and thus darker, than the surrounding region.
Does Student Mastery Look Like?

ISBN: 979-8-3308-1920-1
